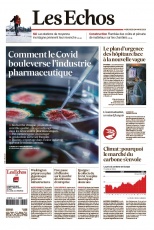
cover-small.jpg

Centre Presse Aveyron journal du 28 mars 2021

Obtenir le journal › Bienvenue à Villecomtal, terre d’accueil et de générosité D’Alep, en Syrie, à Villecomtal Tout le monde a encore en tête les terribles images des familles syriennes fuyant à la fois Daech et les …
100 Avec un peu plus de 100000€ par épisode pour une enveloppe annuelle de 25 à 30millions d’euros, le budget de la série Un si grand soleil reste toutefois inférieur aux budgets de Plus belle la vie et de Demain nous appartient: de 120000à 140000 € l’épisode.
Plus de 300 personnes se relaient 5 jours du 7 pour assurer la continuité de la série: «L’organisation est impressionnante» …
Clément Fournier sort les tracteurs du grenier Rendez-vous
Il allume la mèche. La flamme jaillit et voilà Clément Fournier qui mouline à toute vapeur et vigueur la manivelle. …
Renarde
C’est un renard, Renarde. De son vrai nom Bruno Dibra (ce qui est beaucoup), le Toulousain distille ce qu’il appelle …
Melo’Nomade
Melo’Nomade est un duo composé de la violoncelliste classique Raphaële Murer et du blues folkman sénégalais Magou Samb, héritier du …
La Dépêche du Midi journal du 28 mars 2021

Obtenir le journal › Faut-il rapatrier des femmes et enfants de jihadistes ? «Ses enfants ont été rapatriés. C’est une chance immense, grâce au gouvernement. Aujourd’hui ils vont mieux, ils sont entourés, aidés, …
Syrie : deux ans
Le groupe jihadiste Etat islamique (EI) représente toujours un grand danger, ont mis en garde mardi dans l’est de la …
« Enlevée par son père, ma fille a disparu dans l’enfer du jihad »
Dans « Reviens, Lila », on suit étape par étape les mois et les années après l’enlèvement de Lila : …
Déconfinement: le Portugal voit enfin le bout du tunnel
Le Portugal voit le bout du tunnel. Depuis plusieurs semaines, les cas de Covid-19 ont considérablement diminué dans le pays …
Un test PCR demandé à tous les Français qui voyagent en voiture
Les amoureux de l’Espagne l’avaient sans aucun doute remarqué : les Français qui souhaitaient se rendre en Espagne en voiture …
Le Télégramme journal du 28 mars 2021

Obtenir le journal › La Voix du Nord journal du 28 mars 2021

Obtenir le journal › Le Journal du dimanche journal du 28 mars 2021

Obtenir le journal › Cover Page EXCLUSIF RESTRICTIONS, ÉCOLES, VACCINATION : LES CONFIDENCES DE MACRON • L’alerte de 41 médecins hospitaliers et directeurs de crise : …
QUI VOTE RN ET POURQUOI
Sondage Ifop-Fiducial pour le JDD et Sud Radio 35 % des Français disent avoir déjà voté en faveur du Rassemblement …
Le RN avance, elle recule
RÉVÉLATEUR À un an de la présidentielle, notre sondage montre l’enracinement du parti d’extrême droite, la radicalisation de ses électeurs …
Le « en même temps » de Marine Le Pen
STRATÉGIE Tenter de convaincre de sa crédibilité tout en demeurant radicale et « antisystème » : enquête sur un grand …
Les hommes de la présidente
ENTOURAGE « Historiques », « réalistes » et figures de l’ombre : ceux qui conseillent la candidate d’extrême droite Une …
Courrier Picard journal du 28 mars 2021

Obtenir le journal › Nord Littoral journal du 28 mars 2021

Obtenir le journal › l’Indépendant journal du 28 mars 2021

Obtenir le journal › Un an de Covid, deux destins de femmes qui veulent changer de vie Yohanna Nydegger, 34 ans, est une fille de la montagne Noire. Serveuse au café du Commerce de Montolieu, elle disait …
Le CAF et les secours en montagne
Jusqu’à la Seconde guerre mondiale, les secours étaient assurés par les montagnards eux-mêmes, principalement par les Guides dans leurs vallées …
Le club alpin français fête 140 ans de passion
Pour cet anniversaire particulier tous les membres locaux sont sur le pied de guerre afin de marquer le coup, malgré …
Histoire de femmes dans le Minervois
On est fin février2021. La vigne dort. Dans un salon de Gourgazaud, quatre femmes sont réunies en assemblée générale.Annick Tiburce, …
«On doit d’abord se graisser les pieds soigneusement»
Théodore Camus, membre de la section de Lyon, donne par exemple quelques conseils pour s’équiper ainsi que les précautions à …
L’Ardennais journal du 28 mars 2021

Obtenir le journal › Libération Champagne journal du 28 mars 2021

Obtenir le journal › L’Equipe journal du 28 mars 2021

Obtenir le journal › VERSTAPPEN AU MAX Sakhir (BHR) – Désormais, on sait. On sait que le songe d’une nuit d’hiver, il y a deux semaines lors …
La surprise Gasly
La fièvre du samedi soir. Le bonheur d’une cinquième place, à l’issue d’une séance de qualifications indécise, où Pierre Gasly …
Alonso prend beaucoup de place
Même pour un champion de sa trempe, revenir ne sera pas facile pour Fernando Alonso. Plus on avance en âge, …
Aux origines d’Esteban Ocon
Sa pouponnière est à nulle autre pareille. Un mélange que beaucoup jugeraient détestable. Cette odeur souvent entêtante de l’huile, ce …
Aux origines de Pierre Gasly
Les mots d’une mère : « Pierre n’est pas né pilote. Il l’était déjà dans mon ventre. » Pascale Gasly a le sens …
L’Union journal du 28 mars 2021

Obtenir le journal › Le Bien Public journal du 28 mars 2021

Obtenir le journal › Midi Libre journal du 28 mars 2021

Obtenir le journal › Assemblée de la Saint-Hubert : le président critiqué par une minorité Les esprits se sont échauffés sous les tribunes du stade Raoul-Barrière, samedi matin Rien à voir avec le rugby ou …
Restos fermés aux salariés du BTP et possible confinement
Vendredi soir, à l’issue d’une visioconférence entre Valérie Michel-Moreaux et les acteurs économiques du département, la préfecture a suspendu l’autorisation …
Avec son challenge Strava, l’espace Trail attire une foule de concurrents
Ce nom ne dit sûrement rien au commun des mortels: Strava. Or, pour les amoureux de course à pied et …
Semaine sainte
L’église Saint-Joseph de Béziers (à la Font-Neuve) célèbre, comme toutes les églises, la Semaine sainte. Qui elle commence aujourd’hui, dimanche …
Vingt entreprises testent leur vulnérabilité face aux inondations
En tout, la Chambre de commerce et de l’industrie (CCI) et la Chambre des métiers et de l’artisanat (CMA) ont …
Le Journal de Saône et Loire journal du 28 mars 2021

Obtenir le journal › L’Est éclair journal du 28 mars 2021

Obtenir le journal ›
Corse Matin journal du 28 mars 2021

Obtenir le journal › La Provence journal du 28 mars 2021

Obtenir le journal › Le Petit Bleu d’Agen journal du 28 mars 2021

Obtenir le journal › Le journal duSUA l Une nouvelle fois, le SUA s’est lourdement incliné hier soir. Un terrible 57-3 qui met un peu plus en …
Une belle réussite pour la manifestation des acteurs culturels !
C’était l’effervescence ce samedi matin dans la petite rue Paulin Régnier qui abrite le Théâtre Du Jour – Théâtre École …
Les reines gourmandes du concours de boucherie d’Agen
Du côté du parc d’Aquitaine, Les plus matinaux sont arrivés au milieu de la nuit pour rejoindre la halle aux …
Gaz hilarant : un livreur de protoxyde d’azote braqué à Agen
Un individu s’est fait attaquer vendredi soir à Agen alors qu’il se trouvait dans son véhicule. Quatre voleurs lui ont …
Place Fallières, ultimes souvenirs des Carmélites
Nous rendions compte, dans une récente édition, des travaux réalisés sur le site de la Caisse primaire d’assurance maladie (CPAM), …
Le Parisien journal du 28 mars 2021

Obtenir le journal › DRUCKER « Je suis une ancienne voiture avec un moteur neuf » « Ça va ? Vous ne m’avez pas trouvé trop carbonisé ? » s’inquiète faussement Michel Drucker. Après plus de deux heures d’entretien face …
Angoisses gouvernementales
Evidemment, les ministres cherchent à relativiser. « Ce qui détend, c’est de se dire que, quoi que fasse le gouvernement, on lui …
Macron au chevet des jeunes
« Si on passe à côté des jeunes, si on ne comprend pas que c’est un enjeu majeur pour sortir de …
Ce qu’ils feraient s’ils étaient au pouvoir
Au début de la crise, ils ont pour la plupart contenu leurs critiques. Puis les leaders de l’opposition ont lâché …
Le bas de laine des Français intéresse Bercy
Que faire de ces milliards d’euros que les Français n’ont pas pu dépenser et qui dorment confortablement sur leurs comptes …
Les Dernières Nouvelles d’Alsace journal du 28 mars 2021

Obtenir le journal › Nord éclair journal du 28 mars 2021

Obtenir le journal › Toujours en kiosque
Le Perche 24 mars 2021

Obtenir le journal › Voici 26 mars 2021

Obtenir le journal ›
Le Chasseur Français 24 mars 2021

Obtenir le journal › PNP 26 mars 2021

Obtenir le journal › Conformément à la loi Informatique et Libertés du 06 janvier 1978, vous bénéficiez d’un droit d’accès, de rectification et de suppresion des données personnelles qui vous concernent. Vous pouvez exercer ces droits auprès de ePresse en écrivant à l’adresse suivante : TOUTABO 59 rue spontini 75116 Paris, à laquelle vous pouvez également exercer un droit d’opposition à recevoir des offres commerciales. Pour vous désinscrire de cette revue de presse, rendez-vous sur cette page.
TOUTABO, SA au capital de 488 213.90 euros, RCS Paris 480 467 000, 59 rue Spontini 75116 Paris
Les Unes de l’Actu du 27/03/2021
La Libre Belgique journal du 27 mars 2021

Obtenir le journal › Le Dauphiné Libéré journal du 27 mars 2021

Obtenir le journal ›
Le Figaro journal du 27 mars 2021

Obtenir le journal › L’Éclair des Pyrénées journal du 27 mars 2021

Obtenir le journal ›
L’Alsace journal du 27 mars 2021

Obtenir le journal › L’Ardennais journal du 27 mars 2021

Obtenir le journal › Libération journal du 27 mars 2021

Obtenir le journal › les nouvelles filières de l’exil Des trains du Pays basque aux plages de la Manche en passant par les aires de repos et stations-service utilisées par les …
RWANDA Les «responsabilités lourdes et accablantes» de la France
…
Coopération
C’est le sujet que personne ne veut affronter, celui qui charrie le plus de lâchetés et d’hypocrisies, le plus insoluble …
«Les passeurs ont une extrême adaptabilité»
Xavier Delrieu est commissaire de l’Office central pour la répression de l’immigration irrégulière et de l’emploi d’étrangers sans titre (Ocriest), …
A travers la France, les destins fragiles des exilés
De leur pays d’origine à celui dont ils rêvent, les exilés traversent des routes, des mers et des montagnes. Un …
L’Est éclair journal du 27 mars 2021

Obtenir le journal › Le Télégramme journal du 27 mars 2021

Obtenir le journal › La Marseillaise journal du 27 mars 2021

Obtenir le journal › Titre suite titre Révolte pour une « vraie loi climat » Les citoyens trahis de la Convention pour le climat appellent aux manifs …
Article
27926 – 0327 – 3,00 E bouches-du-rhône et var 3,00 E http://www.lamarseillaise.fr Du samedi 27 au dimanche …
Titre suite titre
Photo LM Dans son adresse aux Marseillais réalisée vendredi sur les réseaux sociaux, le maire Benoît Payan renouvelle ses promesses …
Pierre Huguet : ‘ L’école est une priorité pour nous ‘
L’adjoint au maire de Marseille chargé de l’éducation est l’invité du week-end. P. 14 et …
Titre suite titre
Bruno Le Maire a annoncé vendredi 15 millions d’aides à Arcelor avant d’aller « prêter » 40 millions à la …
Charente Libre journal du 27 mars 2021

Obtenir le journal › Courrier Picard journal du 27 mars 2021

Obtenir le journal ›
The Independent journal du 27 mars 2021

Obtenir le journal › La Voix du Nord journal du 27 mars 2021

Obtenir le journal ›
L’actu journal du 27 mars 2021

Obtenir le journal › Centre Presse journal du 27 mars 2021

Obtenir le journal › Le Petit Bleu d’Agen journal du 27 mars 2021

Obtenir le journal › Le journal duSUA l Après la déroute à Bayonne, on attend évidemment une réaction des Agenais à Brive aujourd’hui. Au-delà du résultat, c’est …
Stellia Koumba se libère ce soir
Quitte ou double, ce soir pour Stellia Koumba qui sera opposée à Mentissa dans une « battle » dont elle …
Une classe fermée à Palissy et des gestes barrières galvaudés
Depuis le retour des dernières vacances, la gestion de la crise sanitaire liée à la Covid-19 a été plutôt exemplaire …
10 % de la population a déjà reçu sa première dose de vaccin
En colloque ce vendredi dans la région voisine d’Occitanie, le délégué départemental de l’Agence régionale de santé de Nouvelle-Aquitaine, Joris …
Article
Marché bio > Sur le boulevard. Le marché biologique se développe en nombre de commerçants et propose désormais, en plus …
Sud Ouest journal du 27 mars 2021

Obtenir le journal › Le Progrès journal du 27 mars 2021

Obtenir le journal › Midi Libre journal du 27 mars 2021

Obtenir le journal › Aurélie encore cherchée La famille d’Aurélie Vaquier organise une marche solidaire ce dimanche à l’occasion de son anniversaire. Le départ est prévu à …
Le Black flambadou de Sébastien Gâches a fait des heureux
Avec son capucin, il dépose de la graisse sur du haché d’Aubrac.Près de six cents burgers, auréolés du coup de …
“Petites villes de demain” : l’tat et les communes main dans la main
Comme un symbole. Après avoir paraphé la première convention “Centre-bourg” de l’Hexagone en 2015 avec l’tat, puis le premier dispositif …
Les Jeunes agriculteurs en assemblée générale
Ce samedi 27mars, les membres des Jeunes Agriculteurs de Lozère se retrouvent en assemblée générale départementale à la salle des …
« Une étape supplémentaire pour exister dans le paysage »
Que signifie le rôle de chef de file PS pour ce scrutin?C’est être le “premier” des socialistes en vue du …
l’Indépendant journal du 27 mars 2021

Obtenir le journal › Mort carbonisé dans sa voiture après avoir percuté l’arrière d’un tracteur Hier, vendredi 26mars, c’est à 19h20 que les secours ont été alertés, alors qu’un terrible accident de la circulation impliquant …
Les retraités réclament un «plan de relance du pouvoir d’achat»
. Selon la CGT, le département recense environ 143000 retraités. Et pour beaucoup d’entre eux, la vie est loin d’être …
30 passagers d’un bus porteurs de faux tests PCR
L’autobus a été intercepté ce vendredi 26mars à la frontière du Perthus autoroute. À son bord, trente passagers aux papiers …
Accident domestique fatal: il perd le contrôle de sa disqueuse
Terrible accident domestique ce vendredi matin, vers 11 heures, dans une maison coursannaise.Un homme de 56 ans était en train …
Prison: un détenu retrouvé mort dans sa cellule
Hierà 2h40, lors de leur ronde nocturne, les agents pénitentiaires de la prison de Perpignan ont découvert l’un des détenus …
Centre Presse Aveyron journal du 27 mars 2021

Obtenir le journal › Cultures 12, «essentiel» pour le monde des arts aveyronnais Qu’ils soient bédéistes, passeurs de mémoire, musiciens, comédiens ou artistes, ils pensent forcémentà des jours meilleurs, mais ils continuent néanmoins …
Régionales.Les trois visages aveyronnais de la liste écologiste
Candidat malheureux au second tour des élections municipales à Toulouse, Antoine Maurice s’est lancé depuis plusieurs semaines dans la campagne …
Aéroport.Une liaison entre Rodez et Londres cet été avec Ryanair
Alors que les destinations de Charleroi en Belgique et Dublin en Irlande figuraient déjà au tableau d’affichage de l’aéroport Rodez-Aveyron, …
Rodez La sexagénaire retrouvée
Disparue depuis le 23mars, la sexagénaire portugaise Maria Soares Rodrigues (lire notre précédente édition) a été retrouvée saine et sauve …
Disparition.Jean Bousquié, une trace indélébile pour le Ségala
Conseiller général pendant 49 ans, de 1949 à 1998, conseiller municipal à La Salvetat-Peyralès durant 36 ans, co-fondateur du Syndicat …
Presse Océan journal du 27 mars 2021

Obtenir le journal › Les pharmacies sont déjà en rupture de stocks Les gens répondent extrêmement rapidement à nos sms pour un rendez-vous. Denis Millet est pharmacien à Nantes-Sud. Mercredi, il a …
Les vétérinaires et dentistes vont aussi vacciner
Cela peut paraître surprenant, mais les vétérinaires peuvent tout à fait vacciner des humains. C’est un acte technique qui fait …
L’Agence du médicament confirme un risque de thrombose rare avec l’AstraZeneca
Après la mort d’un étudiant à Nantes le 18 mars, un autre décès, et la survenue de plusieurs cas en France, …
Les off de la semaine
Affiches Le Nantais Eric Fonteneau, plasticien, membre de l’Académie de Bretagne et des Pays de la Loire, vient d’être sollicité par …
La ministre Élisabeth Moreno en visite lundi à Nantes
En début de matinée, ce lundi 29 mars, Élisabeth Moreno visitera la plateforme d’insertion professionnelle des femmes victimes de violences familiales, un …
La Croix journal du 27 mars 2021

Obtenir le journal › La Provence journal du 27 mars 2021

Obtenir le journal ›
Le Républicain Lorrain journal du 27 mars 2021

Obtenir le journal › La Presse de la Manche journal du 27 mars 2021

Obtenir le journal › Ouest-France édition France journal du 27 mars 2021

Obtenir le journal › Le Grand entretien – Quel lien entre la pandémie de Covid et la guerre ? L’historienne Annette Becker. Page …
Télévision – Anne-Élisabeth Lemoine, une cheffe de bande
En Dernière …
Fermer les écoles et confiner, la solution pour sauver l’été ?
Alors que l’épidémie de Covid s’étend, l’exécutif hésite à fermer les établissements scolaires (ici, Jean-Michel Blanquer, en visite hier, au …
Le pari des Saoud a mis le Yémen à l’agonie
Repères Dans quel état est le Yémen, six ans après le début de l’intervention saoudienne ? Le pays s’est littéralement effondré. Comparé à …
Navalny dénonce une privation de sommeil
L’état de santé d’Alexeï Navalny se dégrade-t-il depuis le début de sa détention à l’IK-2, une colonie correctionnelle à l’est …
La Dernière Heure/Les Sports journal du 27 mars 2021

Obtenir le journal › Corriere Della Sera journal du 27 mars 2021

Obtenir le journal ›
Mon Quotidien journal du 27 mars 2021

Obtenir le journal › Le Petit Quotidien journal du 27 mars 2021

Obtenir le journal ›
Le Journal de Saône et Loire journal du 27 mars 2021

Obtenir le journal › Nord éclair journal du 27 mars 2021

Obtenir le journal › La Dépêche du Midi journal du 27 mars 2021

Obtenir le journal › La cuvée du Covid On dit souvent que la France est le pays aux mille fromages. Elle est aussi assurément celui de milliers de …
Les Français dégustent mais les vins trinquent…
Du moine médecin François Rabelais, la France connaît l’éternel « Beuvez toujours, ne mourrez jamais ». Certes, en bon humaniste …
Les bons « plants » à suivre
En pleine crise du vin, entre mévente internationale et fermeture des bars et restaurants, les amateurs ont trouvé le chemin …
« Les aides de l’UE ne sont pas à la hauteur des enjeux »
Votre état des lieux concernant la filière viticole en Occitanie ? Le paysage est très contrasté selon qu’on parle …
« Mutation de la consommation »
Sur le canal du Midi, la période hivernale de chômage est finie. En théorie. Mais les bateaux restent pour l’essentiel …
Le Bien Public journal du 27 mars 2021

Obtenir le journal › Le Veinard journal du 27 mars 2021

Obtenir le journal › La Nouvelle République des Pyrénées journal du 27 mars 2021

Obtenir le journal › Un ballon d’oxygène C’est la version laïque et montagnarde du « Aide toi, le ciel t’aidera » : « Aide-toi et l’Etat t’aidera …
Justice: il menace les jeunes de leur mettre une «prune»…
« C’est encore une affaire de jeunes » pointe la présidente Élisabeth Gadoullet. En conflit avec un adulte. Le 21 …
« Fidéliser le nouveau public entrevu cet été »
Après avoir rappelé l’importance du tourisme dans l’économie locale (37 % des recettes du département, 10 % du PIB régional), …
Montagne : le ministre et les acteurs planchent sur demain
« Comme aurait dit Jacques Chirac, c’est beau mais c’est loin ! » A son arrivée à Piau-Engaly hier matin, …
Fin de la deuxième phase au 30 avril
Faisant suite à la première phase entre la place Verdun et les rues Ferrer et Cohou, la deuxième partie des …
Nord Littoral journal du 27 mars 2021

Obtenir le journal › Corse Matin journal du 27 mars 2021

Obtenir le journal ›
L’Est Républicain journal du 27 mars 2021

Obtenir le journal › La Nouvelle République journal du 27 mars 2021

Obtenir le journal › L’Equipe journal du 27 mars 2021

Obtenir le journal › MAUVAISE BLAGUE Et nous revoilà face au vide. Comme un lendemain de cuite à touiller sa tasse de café en se demandant …
La France est entrée dans une autre phase
On a vu un match de tranchées, d’hiver. Avec beaucoup de fautes. Et j’ai trouvé que le caractère était écossais. …
Les notes du match
Le juste Price Les Écossais ont entamé tambour battant la partie, jouant juste et alternant bien. Impeccable dans son rôle …
Au cœur du jeu
Repositionné ailier gauche, le centre parisien a encore réussi un match solide. Jouait-il vraiment ailier, d’ailleurs ? Il s’est tellement proposé …
Chardon ardent
Vingt-deux ans, ça fait loin. En avril 1999, Romain Ntamack n’était pas encore né, mais son père Émile disputait bien …
Ouest-France journal du 27 mars 2021

Obtenir le journal › Fermer les écoles et confiner, la solution pour sauver l’été ? Alors que l’épidémie de Covid s’étend, l’exécutif hésite à fermer les établissements scolaires (ici, Jean-Michel Blanquer, en visite hier, au …
Ne pas lâcher maintenant
L’image est tout un symbole. Le canal de Suez est impraticable depuis quatre jours et pour des semaines à venir. …
Le Grand entretien – Quel lien entre la pandémie de Covid et la guerre ?
L’historienne Annette Becker. Page …
Rugby – Le XV de France voit son rêve brisé par l’Écosse
En …
Navalny dénonce une privation de sommeil
L’état de santé d’Alexeï Navalny se dégrade-t-il depuis le début de sa détention à l’IK-2, une colonie correctionnelle à l’est …
L’Union journal du 27 mars 2021

Obtenir le journal › The New York Times International Edition journal du 27 mars 2021

Obtenir le journal › Le Maine Libre journal du 27 mars 2021

Obtenir le journal › Le temps du report ? Nous saurons dimanche si le conseil scientifique préconise un nouveau report des élections régionales et départementales, prévues les 13 et …
Apnée du sommeil : grâce à cet appareil, elle revit
La machine de ventilation a permis à Roselyne Leroy de retrouver un sommeil paisible et de l’énergie. Page …
Bientôt sept nouveaux centres de vaccination
Sarthe. D’ici à deux semaines, la vaccination va s’accélérer dans le département avec une stratégie et un maillage territorial renforcés. …
Le retour des éclaircies
La journée s’annonce calme, encore nuageuse en matinée mais les périodes ensoleillées vont gagner peu à peu du terrain. Les …
Tout de suite à l’heure d’été
Le passage à l’heure d’été a lieu dans la nuit de samedi à dimanche. Il faudra avancer les aiguilles d’une …
Le Parisien journal du 27 mars 2021

Obtenir le journal › Tour de vis dans les écoles La scène va se produire de plus en plus souvent. Hier matin, Louise, 6 ans, en CP, a dû quitter précipitamment …
Encore quelques jours avant de trancher
Le calme avant la tempête ? Alors que l’épidémie flambe dans une grande partie du pays, Emmanuel Macron se retrouve au …
Le nouveau plan de bataille de l’Europe
@erwanbenezet La goutte de vaccin qui a fait déborder le flacon. Alors qu’AstraZeneca accumule les retards de livraison à …
Ces femmes que le coronavirus a privées d’enfant
Au labo, en cette fin de matinée, une biologiste cherche des ovules au microscope, une autre prépare un cathéter de …
Une facture de 32 milliards pour le soutien à l’économie en 2021
L’état devrait dépenser environ 32 milliards d’euros (Mds€) pour soutenir l’économie en 2021, après une année 2020 qui a vu le …
Le Courrier de L’Ouest journal du 27 mars 2021

Obtenir le journal › La démocratie malade Que ferons-nous les 13 et 20 juin ? Une partie de la réponse devrait nous être donnée demain. Le Conseil scientifique a en …
Fillette tuée par un chien : d’où vient l’agressivité
page …
Elle ouvrent un bistrot boulevard Foch
…
Moulin et le SCO, la fin en juin
FOOTBALL. L’entraîneur emblématique d’Angers-SCO Stéphane Moulin a annoncé hier son intention de quitter le club au terme de sa dixième …
Trois parlementaires tentent de faire évoluer la loi
Depuis la loi Claeys-Leonetti de 2016, qui a permis de poser un cadre sur l’accompagnement des personnes en fin de …
Dordogne Libre journal du 27 mars 2021

Obtenir le journal › Libération Champagne journal du 27 mars 2021

Obtenir le journal ›
Aisne Nouvelle journal du 27 mars 2021

Obtenir le journal › The Guardian journal du 27 mars 2021

Obtenir le journal › La Tribune quotidien journal du 27 mars 2021

Obtenir le journal › La stratégie d’Airbus pour passer à des vols 100% aux carburants durables LA TRIBUNE – Airbus vient de lancer une étude sur les émissions en vol d’un avion avec un carburant 100% …
Covid-19 : la hausse préoccupante des jeunes décrocheurs en France
Les ravages de la pandémie sur la jeunesse s’amplifient. Selon les derniers chiffres de l’Insee (lien : https://www.insee.fr/fr/statistiques/5346969)dévoilés ce vendredi …
Industrie : la flambée du coût des matières premières met les PME sous pression
« C’est un truc de fou! » Ce sont les premiers mots qui viennent à la bouche de Samuel Lebain quand on …
"C’est une crise terrible pour le capitalisme traditionnel" (Robert Boyer, économiste)
LA TRIBUNE- Quelles leçons pouvons-nous tirer des pandémies du passé sur les plans économique et sanitaire ? ROBERT BOYER – …
Désinformation en ligne : bientôt la fin de l’impunité pour les réseaux sociaux ?
Alors qu’un fossé infranchissable semble séparer républicains et démocrates au point que certains commentateurs estiment que l’Amérique n’a pas été …
L’Equipe Magazine journal du 27 mars 2021

Obtenir le journal › Hauts et forts P eut-il être question de sport de haut niveau dès lors que l’on ne parle pas du tout de stats, …
COVER STORY
Elle doute, ses journées sont doubles et sa tâche immense, depuis son élection à la tête de la FFSG, il …
Le SAV
Arbitre sans crampons Non, il n’a pas été mis au repos après son beau geste acrobatique, Romain Poite, l’arbitre français …
Un double salto dans l’aventure
Si l’aventure s’arrête prématurément, elle pourra au moins se prévaloir d’avoir été la première candidate de cette nouvelle saison de …
À l’Est, plein de nouveaux
LES BONS « CLIENTS » Cinq victoires en cinq matches contre l’Arménie ; trois succès également contre la Slovénie. La …
Les Dernières Nouvelles d’Alsace journal du 27 mars 2021

Obtenir le journal › TV Grandes Chaines journal du 27 mars 2021

Obtenir le journal ›
Tout Lyon Essor Rhone journal du 27 mars 2021

Obtenir le journal › journal du 27 mars 2021

Obtenir le journal › Toujours en kiosque
Sciences et Avenir 25 mars 2021

Obtenir le journal › L’Humanité Dimanche 25 mars 2021

Obtenir le journal ›
La Tribune de Montélimar 25 mars 2021

Obtenir le journal › Connaissance des Arts 22 mars 2021

Obtenir le journal › Conformément à la loi Informatique et Libertés du 06 janvier 1978, vous bénéficiez d’un droit d’accès, de rectification et de suppresion des données personnelles qui vous concernent. Vous pouvez exercer ces droits auprès de ePresse en écrivant à l’adresse suivante : TOUTABO 59 rue spontini 75116 Paris, à laquelle vous pouvez également exercer un droit d’opposition à recevoir des offres commerciales. Pour vous désinscrire de cette revue de presse, rendez-vous sur cette page.
TOUTABO, SA au capital de 488 213.90 euros, RCS Paris 480 467 000, 59 rue Spontini 75116 Paris
Les Unes de l’Actu du 26/03/2021
| La Croix
journal du 26 mars 2021
|
||||||
| Les Echos
journal du 26 mars 2021
|
||||||
|
||||||
| La Dépêche du Midi
journal du 26 mars 2021
|
||||||
|
||||||
|
||||||
|
||||||
| L’Opinion
journal du 26 mars 2021
|
||||||
| La Nouvelle République des Pyrénées
journal du 26 mars 2021
|
||||||
|
||||||
| La Tribune quotidien
journal du 26 mars 2021
|
||||||
|
||||||
|
||||||
| Le Courrier de L’Ouest
journal du 26 mars 2021
|
||||||
| Le Parisien
journal du 26 mars 2021
|
||||||
|
||||||
| Centre Presse Aveyron
journal du 26 mars 2021
|
||||||
| Midi Libre
journal du 26 mars 2021
|
||||||
|
||||||
| L’Equipe
journal du 26 mars 2021
|
||||||
| Presse Océan
journal du 26 mars 2021
|
||||||
| l’Indépendant
journal du 26 mars 2021
|
||||||
|
||||||
| Le Petit Bleu d’Agen
journal du 26 mars 2021
|
||||||
|
||||||
| La Marseillaise
journal du 26 mars 2021
|
||||||
|
||||||
| Libération
journal du 26 mars 2021
|
||||||
|
||||||
| L’Humanité
journal du 26 mars 2021
|
||||||
| Ouest-France édition France
journal du 26 mars 2021
|
||||||
|
||||||
| Le Maine Libre
journal du 26 mars 2021
|
||||||
|
||||||
|
||||||
|
||||||
| Ouest-France
journal du 26 mars 2021
|
||||||
|
||||||
| Auto Plus
journal du 26 mars 2021
|
||||||
| Closer
journal du 26 mars 2021
|
||||||
| Elle
journal du 26 mars 2021
|
||||||
| Marianne
journal du 26 mars 2021
|
||||||
| Public
journal du 26 mars 2021
|
||||||
| Le nouvel Economiste
journal du 26 mars 2021
|
||||||
|
||||||
| Sport Auto
journal du 26 mars 2021
|
||||||
|
||||||
| Mieux Vivre Votre Argent
journal du 26 mars 2021
|
||||||
|
||||||
| France Dimanche
journal du 26 mars 2021
|
||||||
|
||||||
|
||||||
| Midi Olympique Vert
journal du 26 mars 2021
|
||||||
|
||||||
|
||||||
| Décision Boissons
journal du 26 mars 2021
|
||||||
|
||||||
|
||||||
|
||||||
| Toujours en kiosque | ||||||
|
||||||
|
||||||
| Conformément à la loi Informatique et Libertés du 06 janvier 1978, vous bénéficiez d’un droit d’accès, de rectification et de suppresion des données personnelles qui vous concernent. Vous pouvez exercer ces droits auprès de ePresse en écrivant à l’adresse suivante : TOUTABO 59 rue spontini 75116 Paris, à laquelle vous pouvez également exercer un droit d’opposition à recevoir des offres commerciales.
Pour vous désinscrire de cette revue de presse, rendez-vous sur cette page. TOUTABO, SA au capital de 488 213.90 euros, RCS Paris 480 467 000, 59 rue Spontini 75116 Paris |
Les Unes de l’Actu du 25/03/2021
La Tribune quotidien journal du 25 mars 2021

Obtenir le journal › « Nous sommes sur une trajectoire de croissance » (Pierre Éric Pommellet, PDG de Naval Group) LA TRIBUNE – Quel est le bilan de Naval Group en 2020 ? PIERRE ÉRIC POMMELLET – Nous avons démontré notre …
Rénovation: le rapport Sichel revu et corrigé par les professionnels
C’était l’une des grandes promesses du président de la République devant les 150 membres de la Convention citoyenne pour le …
La France veut mettre fin aux « fuites » carbone
A quelques mois de la Cop 26 de Glasgow, les ministères de l’Economie, des Affaires étrangères et de la Transition …
Ces maires de banlieue qui revitalisent leur centre-ville à coups de pelleteuse
Des rues où les habitants flânent, se donnent rendez-vous, font les boutiques… Un quartier ordinaire ailleurs, mais qui fait rêver …
Made in France ou équitable : quand le bio ne suffit plus, il faut encore se démarquer (3/3)
Si le bio a le vent en poupe (lien : https://objectifaquitaine.latribune.fr/business/2021-03-22/les-entreprises-du-bio-ont-connu-une-croissance-soutenue-en-2020-1-3-879488.html), le constat est généra
La Presse de la Manche journal du 25 mars 2021

Obtenir le journal › Le Journal de Saône et Loire journal du 25 mars 2021

Obtenir le journal › Centre Presse Aveyron journal du 25 mars 2021

Obtenir le journal › Sports.Fin de saison pour le football amateur aveyronnais Fin de partie pour les footballeurs aveyronnais amateurs. La Fédération française de football a annoncé, mercredi que la saison 2020-2021 …
Luc-la-Primaube De la drogue et du liquide saisis lors d’un contrôle routier
Les gendarmes de la compagnie de Rodez assistés des motards de la brigade motorisée ont effectué une saisie de drogue, …
Roquefort.La fumée blanche pour le bleu de brebis de Société? «Des nouveaux consommateurs»
L’INAO, Lactalis et la Confédération générale de roquefort ont trouvé un accord pour changer l’étiquetage de ce produit dont les …
Covid-19.Le «vaccinodrome» aveyronnais sera à Onet-le-Château
Dans sa volonté d’accélérer la campagne de vaccination contre la Covid-19, l’exécutif a souhaité décliner au niveau départemental le principe …
Baraqueville Un camion se couche sur la RN88, le trafic très perturbé
C’est peu avant 6heures, hier matin, que le chauffeur d’un ensemble routier qui venait de quitter la RN88 à 2 …
Dordogne Libre journal du 25 mars 2021

Obtenir le journal › La Libre Belgique journal du 25 mars 2021

Obtenir le journal › Ouest-France journal du 25 mars 2021

Obtenir le journal › Ille-et-Vilaine – Le e-commerce dope la demande d’entrepôts …
Anorexie – Laura témoigne au collège pour aider les autres
En dernière …
Vaccins : l’Union européenne cherche à reprendre la main
Alors que s’ouvrent deux jours de Conseil européen, la Commission a menacé de suspendre les exportations de vaccins vers les …
Union européenne : le défi de la crise des vaccins
Sous pression sanitaire et politique à la veille du Conseil prévu aujourd’hui et demain, les dirigeants européens sont depuis plusieurs …
Les agiles, les malins et les prudents
Dans la course à la vaccination, il y a les premiers de la classe, regardés avec admiration ou envie, puis …
Les Echos journal du 25 mars 2021

Obtenir le journal › Pourquoi l’euphorie des Bourses n’est pas synonyme de bulle Marchés : Après avoir battu des records, les indices boursiers hésitent face à la remontée des taux d’intérêt de long …
La France, championne du contrôle des investissements étrangers
Rachats : Pendant la crise sanitaire, Bercy a nettement serré la vis sur les acquisitions conduites par des groupes étrangers. …
Les conditions d’un rebond économique durable
Aux Etats-Unis, les indicateurs économiques redonnent espoir et l’intensification de la vaccination laisse penser que le rebond est bien à …
Carrefour à l’offensive au Brésil avec un rachat à plus d’un milliard
Distribution : Carrefour peut marcher seul. Deux mois après le veto du gouvernement au projet de rachat par Couche-Tard, le …
Commerce : les pistes de l’Etat pour aider les agriculteurs
AGRICULTURE : Le gouvernement veut « sortir de la logique où le pouvoir d’achat se ferait sur le dos des agriculteurs ». …
L’Humanité journal du 25 mars 2021

Obtenir le journal › Adaptons le bac C’est l’un des (nombreux) sujets de la crise sanitaire où l’absurde le dispute au scandaleux. Le bac 2021, c’est un …
L’homme du jour
Adieu pincettes et formules diplomatiques ! Bonjour colère et courroux contre les grandes puissances capitalistes ! Pour le directeur général de l’Organisation …
« Mères du samedi », le procès de la honte
Ils sont 46 ce jeudi à se retrouver sur le banc des accusés d’un tribunal d’Istanbul. Le but ? Faire taire …
Les lycéens réclament « un bac juste »
Dans les lycées, on a l’impression de vivre le scénario d’ Un jour sans fin, ce film dont le héros, …
« Le déni est caractéristique de cette gouvernance Blanquer »
Les conditions de préparation du bac 2021 sont-elles de nature à générer des inégalités entre les candidats ? Claire Guéville …
L’Est Républicain journal du 25 mars 2021

Obtenir le journal › Le Républicain Lorrain journal du 25 mars 2021

Obtenir le journal › Le Courrier de L’Ouest journal du 25 mars 2021

Obtenir le journal › La saison de football amateur est définitivement arrêtée pages …
Les rails du tramway arrivent à Monplaisir
L’aiguillage qui permettra aux rames de faire demi-tour a été posé hier boulevard Schuman.PAGE …
Les pharmacies vaccinent aussi
Maine-et-Loire. Depuis hier, certaines pharmacies vaccinent avec les doses AstraZeneca. Les officines ont reçu deux flacons pour une vaccination au …
Il veut que sa fille handicapée aille à l’école
page …
Le chantier des silos contesté à Morannes
Le projet de construction de dix silos à grains à Morannes-sur-Sarthe, près de Durtal, est une affaire pleine de rebondissements. …
Le Maine Libre journal du 25 mars 2021

Obtenir le journal › Vaccination : au tour des résidences seniors Le Mans. Les pensionnaires des résidences seniors bénéficient désormais des vaccins. Un vrai soulagement pour beaucoup d’entre eux qui aspirent …
Beillé et Sainte-Sabine : élections partielles
Ce sont les premières élections partielles depuis le scrutin de mars et juin 2020. Des élections municipales partielles complémentaires auront lieu …
Plus couvert
Les nuages seront davantage présents dans le ciel sarthois aujourd’hui après un mercredi très printanier. Il y aura tout de …
Au tour des résidences seniors
Dans la résidence Domitys Le Vallon des Bois au Mans, la vaccination a commencé hier mercredi 24 mars. Tout se déroule …
A 86 ans, rencontrer enfin son arrière-petite-fille
Lylian Van Huffel l’attendait avec impatience ce vaccin. Cette dame, âgée de 86 ans, était donc ravie hier de se faire …
La Croix journal du 25 mars 2021

Obtenir le journal › Même elle La France n’a pas le monopole du couac. « Une erreur doit être appelée une erreur (…). Je demande pardon à …
Il a contribué à la fatigue démocratique
L’instabilité gouvernementale israélienne a d’abord des causes structurelles. Les gouvernements tombent parce que les coalitions ne tiennent pas, et ceci …
Ce qu’il fait n’est pas interdit par la loi, juste contraire aux normes
L’émiettement du paysage politique en Israël est une réalité qui dépasse Benyamin Netanyahou. S’il était arrivé en tête, Yaïr Lapid …
Le vote à 16 ans en débat 2
Le comportement d’une partie significative de la jeunesse face au nécessaire confinement pour limiter la circulation du virus nous montre, …
Le vote à 16 ans en débat 3
Quel serait l’intérêt du vote à 16 ans ? C’est l’âge où l’on prend feu et flamme pour une cause, et c’est …
Le Dauphiné Libéré journal du 25 mars 2021

Obtenir le journal › Courrier Picard journal du 25 mars 2021

Obtenir le journal › Libération journal du 25 mars 2021

Obtenir le journal › 2022 Bertrand s’élance vers le haut de la France …
NEW YORK La Grosse Pomme retrouve la pêche
Reportage, pages …
covid Faut-il refermer les écoles ?
Confrontés à une flambée des cas chez les jeunes et à des protocoles sanitaires insuffisants, des enseignants et des médecins réclament la fermeture des établissements. …
Autruche
«En dernier recours.» La fermeture des écoles ne doit intervenir «qu’en dernier recours», écrivait le Conseil scientifique dans son dernier avis. …
Infections dans les établissements scolaires : un virus qui se tient sage ?
Un virus discipliné en cours ? A écouter le ministre de l’Education nationale, le milieu scolaire n’est en aucun cas …
L’Ardennais journal du 25 mars 2021

Obtenir le journal › Nord éclair journal du 25 mars 2021

Obtenir le journal › La Marseillaise journal du 25 mars 2021

Obtenir le journal › Article 27926 – 0325 – 1,40 E bouches-du-rhône et var 1,40 E http://www.lamarseillaise.fr Jeudi 25 mars 2021 – …
Force ouvrière boude le comité technique
Syndicat majoritaire chez les Territoriaux mais dont le secrétaire général, Patrick Rué, n’a pas obtenu de dérogation de la nouvelle …
Une nouvelle tête pour le Frac
Photo I.S. Muriel Enjalran prend la tête du fonds régional d’art contemporain et entend bien investir tous les territoires de …
Titre
vaccination Dans la région et dans le monde En Provence comme en France, la stratégie de vaccination patine. Dans le …
ils devront encore attendre
Caissières Dès juillet 2020, le Conseil scientifique éditait une stratégie de vaccination ciblant outre les professionnels exposés (santé, Ehpad…), les …
L’Est éclair journal du 25 mars 2021

Obtenir le journal › The Guardian journal du 25 mars 2021

Obtenir le journal ›
L’Union journal du 25 mars 2021

Obtenir le journal › La Provence journal du 25 mars 2021

Obtenir le journal › Presse Océan journal du 25 mars 2021

Obtenir le journal › Le fret ferroviaire s’allie pour peser plus Marché. Le fret ferroviaire en Pays de la Loire concerne quatre marchés principaux : les céréales, destinées à l’exportation, les produits …
Les chiffres de la circulation
En 2019 488 circulations (voyageurs et marchandises) en moyenne par jour : 391 TER, 60 TGV, 9 Intercités, 28 trains de fret. En gare de Nantes : 312 circulations …
Gare de Nantes-État : l’adieu au chemin de fer
L’Île de Nantes poursuit sa mue et, à l’horizon fin 2022, il ne restera que peu de traces du passé …
Nantes plus proche de Rennes et Paris via la SNCF
Comment rapprocher Nantes des métropoles voisines, Rennes et Angers, et de la capitale, Paris ? Cet enjeu fait l’objet d’études où …
Le Carnet : la zone demeure sous surveillance
Impossible, ce mercredi 24 mars, d’accéder au site du Carnet. Plus de 24 heures après l’évacuation, sans heurts, de la Zad sur …
L’Éclair des Pyrénées journal du 25 mars 2021

Obtenir le journal › Le Progrès journal du 25 mars 2021

Obtenir le journal ›
Corse Matin journal du 25 mars 2021

Obtenir le journal › La République des Pyrénées journal du 25 mars 2021

Obtenir le journal › La Dépêche du Midi journal du 25 mars 2021

Obtenir le journal › La santé mentale préoccupe l’exécutif Les conséquences de l’épidémie de Covid-19 sur la santé mentale des Français sont devenues une priorité du gouvernement. Un mois …
Le péril jeune
Les enfants sont les premières victimes de tout conflit et pourtant, ce sont des cris que l’on n’entend jamais. Ou …
Les Français face à la vague psy du Covid
Le succès de la série « Thérapie », diffusée sur Arte, qui met en scène avec beaucoup de finesse un …
Les complémentaires santé vont rembourser des consultations de psychologues
Les fédérations de mutuelles, assurances santé et institutions de prévoyance ont annoncé lundi dernier la prise en charge de plusieurs …
« Les enfants expriment ce qui ressemble à un burn-out »
De nombreux professionnels alertent sur la santé mentale des enfants, adolescents et jeunes adultes. Vit-on une épidémie de détresse psychologique …
La Dernière Heure/Les Sports journal du 25 mars 2021

Obtenir le journal › L’Alsace journal du 25 mars 2021

Obtenir le journal › La Nouvelle République des Pyrénées journal du 25 mars 2021

Obtenir le journal › Pas de fumée sans feu À peine les gyrophares déployés en nombre attiraient les curieux hier sur la place de la mairie, que déjà les …
Mort du bébé Sacha : l’ex nounou bientôt libérée ?
« Les parents de Sacha ont le souffle coupé ». L’ancienne nounou de leur nourrisson décédé, condamnée le 5 février …
Le collège Massey désinfecté
Suite à plusieurs cas de Covid-19 au sein de la direction et des assistants d’éducation, le collège Massey à Tarbes …
La fusion IUT-ENIT se précise
C’est lors d’une conférence de presse conjointe que les pouvoirs publics ont approuvé publiquement un avis favorable au développement du …
Reffye : « Rendez-nous nos heures ! »
Les enseignantes et enseignants du lycée professionnel Reffye se sont mobilisés ce mardi devant l’Inspection Académique des Hautes-Pyrénées. Réunis autour …
Ouest-France édition France journal du 25 mars 2021

Obtenir le journal › Vaccins : l’Union européenne cherche à reprendre la main Alors que s’ouvrent deux jours de Conseil européen, la Commission a menacé de suspendre les exportations de vaccins vers les …
Les chiffres et les mots
Trois de plus. Le Rhône, l’Aube et la Nièvre devraient rejoindre la liste des seize départements soumis à des mesures de …
Anorexie – Laura témoigne au collège pour aider les autres
En dernière …
Pollution de l’air – Des restrictions de circulation dans les villes d’ici à 2025
Page Auto – …
Les agiles, les malins et les prudents
Dans la course à la vaccination, il y a les premiers de la classe, regardés avec admiration ou envie, puis …
Sud Ouest journal du 25 mars 2021

Obtenir le journal › L’actu journal du 25 mars 2021

Obtenir le journal ›
La Nouvelle République journal du 25 mars 2021

Obtenir le journal › Charente Libre journal du 25 mars 2021

Obtenir le journal ›
Le Petit Quotidien journal du 25 mars 2021

Obtenir le journal › Le Veinard journal du 25 mars 2021

Obtenir le journal ›
The New York Times International Edition journal du 25 mars 2021

Obtenir le journal › Al Bayane journal du 25 mars 2021

Obtenir le journal › L’Opinion journal du 25 mars 2021

Obtenir le journal › Vaccination: additionner les forces plutôt que les diviser La France se dirige vers les 100 000 morts de la Covid au rythme de 250 décès quotidiens, les contaminations …
Les assureurs espèrent tourner la page de la crise en se donnant une «raison d’être»
A quoi sert l’assurance ? La Fédération française du secteur (FFA) craint que les Français se posant la question n’aient …
Vaccins: la menace du blocus
La partie paraissait pourtant déjà gagnée. Grâce au pouvoir de dissuasion de son mécanisme de contrôle des exportations de vaccins …
L’Afrique dénonce l’égoïsme vaccinal des Occidentaux
Dans une tribune publiée le 7 février sur le site du Guardian, Paul Kagame dénonçait le nationalisme vaccinal des Etats-Unis …
Malgré les ratés, l’Union européenne défend sa politique en matière de vaccins
Le 14 juillet, comme promis par Thierry Breton, le commissaire au Marché intérieur ? Ou le 21 juillet, date de …
Corriere Della Sera journal du 25 mars 2021

Obtenir le journal › La Voix du Nord journal du 25 mars 2021

Obtenir le journal › L’Equipe journal du 25 mars 2021

Obtenir le journal › UN GRAIN DE SABLE S’il s’était seulement agi de préparer l’Euro à venir, on n’en aurait pas fait tout un plat, sans doute, parce …
« Accident, un bien grand mot »
« Quelle analyse faites-vous de ce match ? Le résultat n’est pas satisfaisant et amène de la déception. On a eu des …
Deschamps, des choix non payants
Coman, la sortie du meilleur offensifSix ans après ses débuts, Kingsley Coman est toujours à la recherche d’un statut solide …
Griezmann
Il y avait à peu près tout d’Antoine Griezmann dans son but : le lutteur à la conquête du ballon, cette …
Bouchtchane hésitant mais résistant
Préféré à Piatov dans le but, BOUCHTCHANE (4), surpris par la frappe enroulée de Griezmann (19e), se loupe en dévissant …
Le Télégramme journal du 25 mars 2021

Obtenir le journal › Le Figaro journal du 25 mars 2021

Obtenir le journal ›
Mon Quotidien journal du 25 mars 2021

Obtenir le journal › Centre Presse journal du 25 mars 2021

Obtenir le journal › Le Parisien journal du 25 mars 2021

Obtenir le journal › L’épidémie s’emballe, tenir… jusqu’à quand ? Le mail est tombé à 8 h 24, hier. Destinataires : les 100 000 personnes qui œuvrent à l’Assistance publique-Hôpitaux de Paris, le plus grand …
« Sans nouvelles mesures, on devra trier les patients »
Dans un entretien accordé à notre journal il y a une semaine, Karine Lacombe, cheffe du service infectiologie de l’hôpital …
Les autotests ne devraient pas être vendus en grande surface
C’était il y a dix jours. Interrogé sur BFM, le directeur général de la Santé, Jérôme Salomon, annonçait la prochaine …
Espoirs, méfiance et attentes
La France approche les 10 millions d’injections de vaccins contre le Covid. Les sérums Pfizer et de Moderna, stockés à – 80 °C, …
La stratégie de l’exécutif sous le feu des critiques
Partout — ou presque —, les signaux virent au rouge, partout, à droite comme à gauche, et même dans la …
Midi Libre journal du 25 mars 2021

Obtenir le journal › « Moi je veux mourir sur scène, devant les projecteurs » Ce mercredi midi, sur le toit du Cratère, on a chanté du Dalida…«Viens, mais ne viens pas quand je serai …
Les dépôts sauvages, tant de taches dans la nature
Une petite rue transversale entre Celleneuve et La Martelle. Un coin discret pour se débarrasser, ni vu ni connu, de …
Les syndicats agricoles appellent à la mobilisation
Sur leur page Facebook, les Jeunes Agriculteurs 48 appellent à se joindre à la mobilisation, prévue ce jeudi 25mars à …
L’hommage au colonel Arnaud Beltrame
Le 24mars 2018, le colonel Arnaud Beltrame était assassiné lors des attaques terroristes de Trèbes, dans l’Aude. Ce mercredi matin, …
Des tests salivaires en masse, dès ce vendredi, en direct du Créa
«N’avoir ni mangé, ni bu, ni fumé 30 minutes avant de le faire»est la seule condition rédhibitoire au test salivaire. …
Aisne Nouvelle journal du 25 mars 2021

Obtenir le journal › France-antilles Martinique journal du 25 mars 2021

Obtenir le journal ›
Le Petit Bleu d’Agen journal du 25 mars 2021

Obtenir le journal › Libération Champagne journal du 25 mars 2021

Obtenir le journal › l’Indépendant journal du 25 mars 2021

Obtenir le journal › 18 ans de réclusion pour «viols et actes de torture» Commencé vendredi 19mars, le procès à huis clos de Moktar Sadji, 26 ans, aurait bien pu ne pas se poursuivre …
Les explications de la direction départementale
Nicolas Demonet, directeur départemental des finances publiques, s’appuie, notamment sur le constat engendré par la crise sanitaire: «Nos guichets ont …
Tuée au Guatelama: 11 ans après, ils veulent un procès dans les P.-O.
Le 25mars 2010, Florence Denèfle, professeur détachée de l’Éducation nationale en poste au lycée français de Guatemala Ciudad, est retrouvée …
Une pétition pour reporter les élections
S’il a été fondé à Narbonne, le Club Socrate s’emploie à lancer le débat à l’échelledu département, et même de …
Interpellé après l’incendie de 10 véhicules et 4 mobile-homes
Entre 21heures et 23heures, ce mardi 23mars, les sapeurs-pompiers des centres de secours de Palau et d’Elne ont dû intervenir …
Nord Littoral journal du 25 mars 2021

Obtenir le journal › The Independent journal du 25 mars 2021

Obtenir le journal ›
Les Dernières Nouvelles d’Alsace journal du 25 mars 2021

Obtenir le journal › Le Bien Public journal du 25 mars 2021

Obtenir le journal › TeleObs journal du 25 mars 2021

Obtenir le journal › N° 2943 – du 25 mars 2021 " CITIZEN KITANO " ARTISTE TOTAL MERCREDI – ARTE FILMS, SÉRIES, DOCUMENTAIRES. VOTRE GUIDE DU …
TAKESHI KITANESQUE
MERCREDI – 22H45 – ARTE Vous a-t-il été facile d’approcher Takeshi Kitano ? Yves Montmayeur …
CARRÉMENT CRAIGNOS
DISPONIBLE SUR FRANCE.TV ** Un gros paquet d’oseille à trouver fissa et une bande de bras cassés pour remplir cette …
IT’S A SIN
DISPONIBLE SUR CANAL+ ** « It’s a Sin » démarre comme une comédie populaire, fraîche et enjouée. Elle nous plonge …
DES VOIX DANS LA TÊTE
MARDI – 23h30 – FRANCE 2 Pierre, Vincent, Camille, Julie, Paulo et Aïcha sont ce que l’on appelle des « …
L’Echo Sarthois journal du 25 mars 2021

Obtenir le journal › Les Nouvelles – L’Echo Fléchois journal du 25 mars 2021

Obtenir le journal › L’Express journal du 25 mars 2021

Obtenir le journal › Le PDG d’Hachette Livre réagit Dans l’article consacré à Hachette Livre (« Vivendi, le dernier combat d’Arnaud Nourry », L’Express du 18 mars) figurent un …
Une nouvelle récompense pour L’Express
Bonne nouvelle pour L’Express, qui vient de décrocher une bourse décernée par le Centre européen de journalisme. Chaque année, ce …
Cafouillage au sein de l’UE
Brillant « papier » de Marion Van Renterghem, « Le grand ratage de l’Europe » (L’Express du 11 mars), concis …
Personnages de fiction et réalité
Vous rendez compte du livre de Johann Zarca, Chems, (L’Express du 11 mars) en affirmant, après avoir évoqué ma place …
La France, le Maroc et le cannabis
Le Maroc est aujourd’hui le premier producteur mondial de cannabis, lequel est devenu la drogue la plus consommée sur la …
Challenges journal du 25 mars 2021

Obtenir le journal › Confidentiel L’économiste Olivier Vigna va remplacer Arnaud de Bresson comme délégué général de Paris Europlace. Le Hyatt Regency Chantilly (2,2 millions …
Altice injecte de la data dans sa régie pour défier le marché publicitaire
« La première régie intégrée », dixit son directeur général Raphaël Porte. Altice Media Ads & Connect (150 personnes) a …
Médias
En vue de la présidentielle, France Bleu et France Télévisions réfléchissent à une offre numérique d’infos de proximité avec France …
Les entreprises entrent en guerre contre les fake news
La blockchain pour lutter contre le « news hacking ». Le sujet résonne à l’heure où Facebook est accusé par …
La Chine rêve d’impérialisme technologique
L’Office européen des brevets a publié son rapport annuel. Avec 44 293 dépôts en 2020, les entreprises américaines continuent de …
L’Auto Journal journal du 25 mars 2021

Obtenir le journal › OÙ SONT LES PETITES ? Quand Toyota donne des indices sur la remplaçante de son Aygo, l’événement dépasse le renouvellement de gamme du géant japonais. …
ÇA VOUS A FAIT RÉAGIR…
Comme j’ai bien fait d’acheter ce matin votre magazine dans lequel j’ai eu plaisir à lire votre édito ! Moi …
LES PERLES DE L’AVVOCATO
Gianni Agnelli, célèbre patron de Fiat et grand passionné de Ferrari, aurait fêté ses 100 ans cette année. Pour lui …
La 308 tourne le dos à la Golf !
C’est à partir d’un constat simple que la cheffe de projet marque, Agnès Tesson, et ses équipes, ont tracé les …
Avant-goût
Révolution chez les constructeurs premium : quelques semaines après Jaguar, c’est au tour de Volvo d’annoncer un futur 100 % …
Le Journal du Bâtiment et des TP journal du 25 mars 2021

Obtenir le journal › L’Histoire journal du 25 mars 2021

Obtenir le journal › L’Humanité Dimanche journal du 25 mars 2021

Obtenir le journal › CE CÉSARISME QUI NOUS MÈNE DANS LE MUR Le temps perdu se rattrape-t-il ? Nous voilà plongés dans un « surplace allégé », après que le premier ministre …
HYPNOSE VOLCANIQUE
Le pays de Glace a repris feu. Cela fait des millénaires que l’Islande, à cheval sur les plaques continentales européenne …
À LA CANTINE, L’HEURE DE BIEN MANGER A SONNÉ !
Quelle salade ! Le choix de la municipalité lyonnaise de bannir temporairement des restaurants scolaires la viande, le temps du …
« LES MENUS VÉGÉTARIENS, MOINS CHERS, PERMETTENT DE PROPOSER DE LA VIANDE BIO ET LOCALE »
En quoi consiste l’option végétarienne quotidienne dans les cantines ? L’idée, c’est de pouvoir servir à chaque repas un …
L’ÉLEVAGE NON INDUSTRIEL ABANDONNÉ EN RASE CAMPAGNE
Les éleveurs bovins en ont gros sur la patate. Leurs revenus plongent… Et on leur demande de jouer les figurants …
Paris Match journal du 25 mars 2021

Obtenir le journal › Cover page VACCIN LES VRAIS DANGERS D’ASTRAZENECA MADAME CLAUDE SA VIE DEVIENT UN FILM FLORIAN ZELLER LE FRANÇAIS QUE L’AMÉRIQUE S’ARRACHE SON …
Le choc des générations
Le nouvel ouvrage de Delphine de Vigan, « Les enfants sont rois », décortique les réseaux sociaux et leurs travers. …
Anne-Elisabeth Lemoine, reine de l’échiquier
Elle succède à Anne-Sophie Lapix pour animer « Le grand échiquier », désormais programmé en prime time le samedi sur …
Ange Basterga, le Corse qui cartonne sur Netflix
Bingo, le long-métrage est primé en 2017 au Festival de Cognac. De quoi intriguer le géant américain Netflix qui fait …
Louise Mushikiwabo, la francophonie en marche
Nommée en octobre 2018 secrétaire générale de la Francophonie, Louise Mushikiwabo a présenté la semaine dernière un rapport d’étape de …
Le Point journal du 25 mars 2021

Obtenir le journal › Le Progrès Saint-Affricain journal du 25 mars 2021

Obtenir le journal › Valeurs Actuelles journal du 25 mars 2021

Obtenir le journal › Virus : à chacun sa fête ! de l’Institut Située dans le même XVIe arrondissement de Paris que le siège de Valeurs actuelles, cette pharmacie a …
EN HAUSSE
Pinturault Le Savoyard de 30 ans devient le meilleur skieur du monde en décrochant le gros globe de cristal, …
Inauguration du stade Charles-de-Gaulle
Reporté à cause du Covid-19, le baptême du stade Charles-de-Gaulle de Colombey-les-Deux-Églises aura lieu le dimanche 6 juin. Pour inaugurer …
EN BAISSE
Castex Le Premier ministre a finalement reculé après les multiples railleries contre les attestations incompréhensibles qui recensaient quinze motifs …
Quelle fin de quinquennat pour Macron ?
C’est une question qui agite ministres, conseillers et le principal intéressé : comment Emmanuel Macron doit-il envisager la fin de …
Ca m’intéresse journal du 25 mars 2021

Obtenir le journal › Diapason journal du 25 mars 2021

Obtenir le journal › L’Obs journal du 25 mars 2021

Obtenir le journal › L’urgence vaccinale Il y a un an, s’adressant à la nation tout entière, Emmanuel Macron entrait « en guerre » contre la …
UN TROU SOUS LA MANCHE
« S’il le faut, j’irai voir la reine. » Jacques Damas est un patron hors norme. « Théâtral », prévient …
PERDRE SON LATIN
L’autre jour, un ami, ancien camarade de lycée, m’appelle. Il a la voix qui tremble. Le souffle court. Il veut …
LES MOTS CROISÉS
Horizontalement 1. Pointer au guichet de poste. 2. On y découvre les charmes de la traînée. 3. Usant d’expédients …
RIEN QUE SUR LE WEB
Les articles de « l’Obs » ne sont pas seulement dans le journal. Reportages, analyses, enquêtes, interviews, débats… découvrez tous …
Management journal du 25 mars 2021

Obtenir le journal › Vogue journal du 25 mars 2021

Obtenir le journal › Valeurs Actuelles Hors-Série journal du 25 mars 2021

Obtenir le journal › L’histoire, monument en péril Accusés, levez-vous ! Le box est trop étroit pour que tous les prévenus puissent s’y tenir ensemble pour une dernière …
Franck Ferrand : “Le remords, la repentance, l’autoflagellation sont devenus nos nouveaux sports nationaux”
Propos recueillis par Raphaël Stainville À la suite d’André Castelot et d’Alain Decaux, dont il se réclame volontiers, Franck …
Ostracisés !
…
Vercingétorix le Gaulois
Si l’on excepte ce que nous rapporte César dans le livre VII de son De bello gallico, la matière documentaire …
Ce baptême qui a fait la France
Il s’avance, nouveau Constantin, pour se guérir de la maladie d’une vieille lèpre (…) et Remi lui dit : “Dépose …
Politis journal du 25 mars 2021

Obtenir le journal › FABER ET LE COMPROMIS EN FRICHE Emmanuel Faber, ex-PDG de Danone, a-t-il vraiment «trahi la loi du profit », comme l’affirme Patrick Piro dans le billet …
La peste soit des États…
Merci à Politis pour son dossier sur la responsabilité humaine dans la pandémie actuelle, paru dans le numéro 1644. C’est …
Mais quel second tour ?
Le temps de laisser s’écrémer la boue informative, entre les chiffres de la pandémie instrumentalisée et les spéculations lepenomacronniennes pour …
Le retour d’un imposteur
Que vaut la parole d’un Manuel Valls ? Dans un livre, qui paraît cette semaine sous un titre emprunté à …
SOMMAIRE N°1646 – DU 25 AU 31 MARS 2021
EN COUVERTURE 09 LA SEMAINE12 JUSTICE Chez Ikea, les meubles ont des oreilles 20 PORTFOLIO Paysages de l’exil Entre intime …
Sciences et Avenir journal du 25 mars 2021

Obtenir le journal › Serment d’intégrité Il y avait le serment d’Hippocrate, il y aura désormais le serment d’intégrité scientifique. Il est possible que l’annonce de …
De l’hydrogène dans les voitures ?
Votre dossier expose les ambitions françaises pour développer la filière hydrogène dans les transports. La comparaison entre le véhicule à …
Erratum
Dans le schéma de la pile à combustible du dossier sur l’hydrogène ( S. et A. n° 889), p. 33 …
Les promesses de l’hydrogène
Lecteur assidu de votre publication depuis de longues années, j’ai été très étonné par l’article sur l’hydrogène, qui propose cette …
Soignons nos microbiotes
C’est une jungle qui colonise quasiment tout notre organisme : plus de 10 000 milliards de bactéries élisent domicile dans …
Society journal du 25 mars 2021

Obtenir le journal › Fabio Viscogliosi 1. Sur le site The Local, un journaliste britannique a attribué une moyenne de 5/10 à la France pour sa …
Télex
La question “Comment l’oreille de cette patiente s’est-elle transformée ‘en gelée de pommes cuites’?” a été posée par Sciencepost.fr. Sur …
Télex
Qui est amoureux de la race de mouton Bleu du Maine et s’attache à la faire renaître? C’est David Rocheteau, …
SOS médias
Pourquoi publier ce livre maintenant? Julia Cagé: Ces derniers mois, un certain nombre de coups ont été portés à l’indépendance …
Télex
En Aveyron, le marché du roquefort marque le pas, contrairement à celui de la fibre optique. … Depuis plusieurs mois, …
Mi Semanal journal du 25 mars 2021

Obtenir le journal › Le Journal d’Elbeuf journal du 25 mars 2021

Obtenir le journal ›
La Chronique Républicaine journal du 25 mars 2021

Obtenir le journal › Le Courrier Vendéen journal du 25 mars 2021

Obtenir le journal ›
Le Démocrate Vernonnais journal du 25 mars 2021

Obtenir le journal › Le Courrier Indépendant journal du 25 mars 2021

Obtenir le journal ›
L’Informateur d’Eu journal du 25 mars 2021

Obtenir le journal › La Gazette du Centre Morbihan journal du 25 mars 2021

Obtenir le journal ›
Le Journal de L’Orne journal du 25 mars 2021

Obtenir le journal › Liberté – Le Bonhomme Libre journal du 25 mars 2021

Obtenir le journal ›
Le Penthièvre journal du 25 mars 2021

Obtenir le journal › La Vie Quercynoise journal du 25 mars 2021

Obtenir le journal ›
Le Trégor journal du 25 mars 2021

Obtenir le journal › Les Nouvelles de Falaise journal du 25 mars 2021

Obtenir le journal ›
Le Petit Bleu journal du 25 mars 2021

Obtenir le journal › Pontivy journal journal du 25 mars 2021

Obtenir le journal ›
Le Journal Des Sables journal du 25 mars 2021

Obtenir le journal › Le Publicateur Libre journal du 25 mars 2021

Obtenir le journal ›
Le Pays Malouin journal du 25 mars 2021

Obtenir le journal › Le Ploermelais journal du 25 mars 2021

Obtenir le journal ›
L’Hebdo de Sèvre & Maine journal du 25 mars 2021

Obtenir le journal › La Voix – Le Bocage journal du 25 mars 2021

Obtenir le journal ›
Le Républicain Lot et Garonne journal du 25 mars 2021

Obtenir le journal › La Voix du Cantal journal du 25 mars 2021

Obtenir le journal ›
Le Journal Du Pays Yonnais journal du 25 mars 2021

Obtenir le journal › Le Républicain Sud Gironde journal du 25 mars 2021

Obtenir le journal › Le Villefranchois journal du 25 mars 2021

Obtenir le journal › Orcibal souffle sa première bougie Mars 2020- mars 2021. Une année a passé depuis l’arrivée aux commandes de la nouvelle municipalité de Villefranche après 20 …
DES MENUS LOCAUX DANS NOS CANTINES
D epuis 2019, la communauté de communes Ouest Aveyron porte un projet d’ambition : un PAT, soit un projet alimentaire …
SEULEMENT 10 G DE GASPILLAGE PAR ENFANT
La cantine scolaire de Savignac a un atout, et il s’appelle Olivier. L’école du village fait partie des neuf primaires …
Les Ateliers de la Fontaine tiennent le cap malgré la crise
C omment continuer à proposer des activités culturelles en pleine crise sanitaire ? C’est le défi qu’essaient de relever « …
Le vide-greniers du comité des fêtes se prépare
Le Comité des fêtes de Villefranche s’est retrouvé à Graves pour parfaire les derniers préparatifs du vide-greniers prévu ce dimanche …
Le Résistant journal du 25 mars 2021

Obtenir le journal › L’Hebdo de Charente Maritime journal du 25 mars 2021

Obtenir le journal ›
L’Angerien Libre journal du 25 mars 2021

Obtenir le journal › Voix du Jura journal du 25 mars 2021

Obtenir le journal ›
L’Action Républicaine Nogent journal du 25 mars 2021

Obtenir le journal › Dossier Familial journal du 25 mars 2021

Obtenir le journal › Stratégies journal du 25 mars 2021

Obtenir le journal › L’audio, terre d’innovation Il y a deux ans, le patron d’un studio de podcast me glissait à l’oreille qu’il retrouvait l’adrénaline de la …
« La voix recèle de possibilités multiples encore peu exploitées »
La Cnil qui se penche sur Clubhouse et son utilisation des données personnelles. Clubhouse affole les médias mais aussi …
LE BOOM DES PODCASTS D’ACTUALITÉ
Tous les éditeurs français rêvent d’avoir leur Daily, ce podcast quotidien d’information lancé par le New York Times en 2017 …
LE GRAND RETOUR DE LA CASSETTE
Les tendances sont-elles un éternel recommencement ? À en voir la résurrection de la cassette audio ces dernières années, on …
Parler et partir avec VVF
objectif UNE QUALITÉ D’INFO AVEC MOINS D’EFFORTS. VVF devait sortir en mars 2020 le premier site touristique 100 % vocal …
Le Pèlerin journal du 25 mars 2021

Obtenir le journal › Voix du Midi journal du 25 mars 2021

Obtenir le journal ›
Tribune de Lyon journal du 25 mars 2021

Obtenir le journal › Le Réveil de Neufchâtel journal du 25 mars 2021

Obtenir le journal ›
L’Orne Combattante journal du 25 mars 2021

Obtenir le journal › Rolling Stone journal du 25 mars 2021

Obtenir le journal ›
La Maurienne journal du 25 mars 2021

Obtenir le journal › Le Journal de Tournon-Tain journal du 25 mars 2021

Obtenir le journal › The Running Heroes Society journal du 25 mars 2021

Obtenir le journal › ÉDITO On ne va pas se mentir, vous nous avez manqué. Peut-être pas autant que le five du mardi soir avec …
C’est quoi cette question encore ?
À quoi reconnaît-on une course bio? La course bio est française, de saison et l’inscription coûte plus cher. …
La brassière s’amuse
Octobre 2020. Entre la place de l’Opéra et le boulevard Haussmann, le public s’agite pour assister à l’un des événements …
“ ON M’A TELLEMENT RÉPÉTÉ QUE J’ÉTAIS UNE REBELLE ”
À quoi ressemble ton quotidien depuis le début de la Covid-19? Je m’entraîne. J’ai été blessée l’année dernière, je …
Rabbit Run Eminem (2002)
Break de fin brutal sur l’apostrophe essoufflée, “Rabbit run” ! Comme un coureur “casse” sur la ligne d’arrivée, en rompant …
L’Auvergnat de Paris journal du 25 mars 2021

Obtenir le journal › Le confinement édulcoré La douche écossaise se poursuit pour les cafetiers et restaurateurs français. En début de semaine dernière, le Gouvernement leur présentait …
Chez Yvonne
Chez Yvonne, la winstub emblématique du cœur de Strasbourg (Bas-Rhin) qui a notamment reçu Boris Eltsine, Jacques Chirac et Helmut Kohl, change de …
L’homme d’affaires Abi-Nader Chukri
L’homme d’affaires Abi-Nader Chukri est parvenu à acquérir neuf fonds de commerce dans le centre-ville de Perpignan au croisement des rues de …
Julien Dumas
Julien Dumas, 41 ans, vient d’annoncer son départ du Lucas Carton, 8 ans après son arrivée au poste de chef. …
Pascal Hainigue
Pascal Hainigue devient le nouveau chef pâtissier du Bristol. Le chef du palace de la rue du Faubourg-Saint-Honoré, Éric Frechon …
La Tribune de Montélimar journal du 25 mars 2021

Obtenir le journal › L’Echo de Vibraye journal du 25 mars 2021

Obtenir le journal › Toujours en kiosque
So Foot Club 17 mars 2021

Obtenir le journal › Le Journal d’Abbeville 24 mars 2021

Obtenir le journal ›
L’Eveil Normand 24 mars 2021

Obtenir le journal › Les P’tites Princesses 24 mars 2021

Obtenir le journal › Conformément à la loi Informatique et Libertés du 06 janvier 1978, vous bénéficiez d’un droit d’accès, de rectification et de suppresion des données personnelles qui vous concernent. Vous pouvez exercer ces droits auprès de ePresse en écrivant à l’adresse suivante : TOUTABO 59 rue spontini 75116 Paris, à laquelle vous pouvez également exercer un droit d’opposition à recevoir des offres commerciales. Pour vous désinscrire de cette revue de presse, rendez-vous sur cette page.
TOUTABO, SA au capital de 488 213.90 euros, RCS Paris 480 467 000, 59 rue Spontini 75116 Paris
Les Unes de l’Actu du 24/03/2021
Midi Libre journal du 24 mars 2021

Obtenir le journal › Des reproches pleuvent sur la direction de l’hôpital Pour la première fois, la CGT santé de l’hôpital d’Alès a entrepris de lancer une consultation en direction des quelque …
Le Team 104 a changé de locaux… mais pas de philosophie
Christine, Philippe et Alexis avec une BMW construite dans l’atelier.«Bienvenue aux passionnés.»C’est le message inchangé, voire accentué, de Philippe Diversay …
Juillet : fiesta campera
L’union fait la force. Les clubs taurins nîmois Buous i cavaus, Amis de toros, Palmas y pitos, la peña Ordonezet …
Un cinéma prochainement à Gignac ?
C’est au cours du conseil communautaire du 22mars que le projet a été évoqué, à l’occasion du programme pluriannuel des …
Les Rive auront bien lieu au pôle mécanique
Il s’agit d’un grand rendez-vous alésien. L’édition 2021 des Rencontres internationales des véhicules écologiques (Rive) se tiendra,en extérieur et en …
Ouest-France édition France journal du 24 mars 2021

Obtenir le journal › Coup de pression sur les vaccins En visite hier à Valenciennes, Emmanuel Macron a exhorté à vacciner « matin, midi et soir ». Le gouvernement met la pression …
La croissance encore trop aquavore
La plupart des médias ont séché sur le sujet. La Journée mondiale de l’eau avait lieu lundi. L’actualité française n’en …
Chine – La tension monte avec ses voisins et l’Occident
…
Affaire Magali – « C’était une femme extraordinairement ordinaire »
L’avocat de la famille.Page …
Biométrie : gros contrat pour Thales
La récente prise de contrôle de Gemalto par Thales (2019) porte ses fruits : le ministère de l’Intérieur a sélectionné la …
Le Veinard journal du 24 mars 2021

Obtenir le journal › Dordogne Libre journal du 24 mars 2021

Obtenir le journal › La Croix journal du 24 mars 2021

Obtenir le journal › Le ton monte La diplomatie n’a pas bonne presse. Ce métier, aussi ancien que les relations internationales, est facilement assimilé à un exercice …
« Aux États-Unis, la communauté asiatique est très bien intégrée »
Alessia Lefébure Sociologue et directrice adjointe de l’École des hautes études en santé publique« Les tensions raciales sont fortes et durablement …
Racisme anti-asiatique, un phénomène mal identifié mais bien réel
Ce mercredi 24 mars, dans un contexte marqué par les tueries d’Atlanta aux États-Unis, cinq prévenus doivent répondre devant le tribunal …
Dix ans de mobilisation
20 juin 2010. Plusieurs milliers de personnes se rassemblent à Belleville pour dénoncer les violences et les vols contre la communauté …
Derrière la porte des Ehpad (suite)
(…) À l’entrée en Ehpad, la personne âgée doit laisser à la porte une large part de ce qu’elle est : …
La Nouvelle République journal du 24 mars 2021

Obtenir le journal › Nord éclair journal du 24 mars 2021

Obtenir le journal › La Marseillaise journal du 24 mars 2021

Obtenir le journal › Titre sur 3 lignes Photo Dôme de Marseille Si les ministères de la Culture et de la Santé sont officiellement d’accord pour des concerts-tests, …
Titre sur 2 lignes
relance industrielle 26 millions d’euros – moitié état, moitié Région – sont investis en Paca pour l’industrie via 8 nouveaux …
Titre sur 4 lignes
Vague d’arrestations hier dans les associations kurdes installées en France : huit à Marseille mais aussi à Draguignan et Paris. …
Article
27926 – 0324 – 1,40 E bouches-du-rhône et var 1,40 E http://www.lamarseillaise.fr Mercredi 24 mars 2021 – …
" La puissance publique doit tenir sa place "
Le golfe de Fos est un des territoires parmi les plus industrialisés de France. Il compte plusieurs raffineries, des usines …
The Guardian journal du 24 mars 2021

Obtenir le journal › La Libre Belgique journal du 24 mars 2021

Obtenir le journal › Le Petit Bleu d’Agen journal du 24 mars 2021

Obtenir le journal › Nature l La tulipe d’Agen est une paléo-variété de tulipe en voie de disparition. l Certaines continuent toutefois de s’épanouir dans …
Le Centre de congrès, centre de vaccination et bientôt vaccinodrome ?
Les indicateurs sont mauvais et alertent sur une aggravation de la situation sanitaire à l’échelle du pays. Evoquer une « …
La Covid-19 continue, lentement mais sûrement, de progresser
Depuis des mois maintenant à raison de deux fois par semaine, un point très institutionnel concernant la Covid est effectué …
Le refuge de Brax fait peau neuve grâce à un legs
Il est parfois des bonnes âmes grâce auxquelles se réalisent des merveilles. Violette Maillard est de celles-là, paix à son …
La tulipe d’Agen est à la fête
« Les champs étaient rouges de tulipes dans les années 60 ! », rappelle avec regret Florent Hervouet, chargé de …
La Provence journal du 24 mars 2021

Obtenir le journal › Libération Champagne journal du 24 mars 2021

Obtenir le journal ›
Le Républicain Lorrain journal du 24 mars 2021

Obtenir le journal › Le Progrès journal du 24 mars 2021

Obtenir le journal › l’Indépendant journal du 24 mars 2021

Obtenir le journal › Des silences et des motspour ne pas oublier, troisansaprès Des dépôts de gerbe, et une minute de silence: sur la place de la République de Trèbes, ainsi baptisée en …
La bénédiction des Rameaux en jauge limitée
L’an passé, les nombreuses processions rythmant la semaine avaient toutes été très perturbées, voire annulées. Les offices eux aussi étaient …
FSU et CGT: «Les crèches ne sont pas des poulaillers»
LLa métaphore est pour le moins hyperbolique… Mais a le mérite de mettre le doigt là où ça fait mal. …
Covid: reprise des débats malgré des cas contact
On a beau être la justice, on ne devrait pas passer au-dessus ! », a fait remarquer une de nos …
«Je suis un soldat. On va se venger des Américains et des sionistes»
Début janvier2020, Farid fait ses courses dans un supermarché. Au moment de payer ses achats, il lance à la caissière. …
La Nouvelle République des Pyrénées journal du 24 mars 2021

Obtenir le journal › Pauvre jeunesse « Engagez-vous qu’ils disaient, vous verrez du pays ! » Réplique culte du centurion romain expédié dans les cieux par …
« Une expérience à faire dans sa vie »
Après la parenthèse de 2020, le service national universel fait son grand retour. Les services de la direction académique mènent …
La situation se dégrade dans les établissements scolaires
C’était à craindre. De 11 élèves testés positifs dans la semaine du 8 au 15 mars, le bilan s’est envolé …
Les escrocs présumés des toits arrêtés
Un scénario bien rodé, et très lucratif. Deux jeunes hommes appartenant à la communauté des gens du voyage, âgés de …
À Salles, une biche aveugle attise la curiosité
Elle est devenue la mascotte de Salles-Argelès, et tout le monde s’inquiète pour elle au village. Depuis une semaine, une …
Les Dernières Nouvelles d’Alsace journal du 24 mars 2021

Obtenir le journal › L’Ardennais journal du 24 mars 2021

Obtenir le journal ›
L’Est Républicain journal du 24 mars 2021

Obtenir le journal › Corse Matin journal du 24 mars 2021

Obtenir le journal › Les Echos journal du 24 mars 2021
Obtenir le journal › Le plan d’urgence des hôpitaux face à la nouvelle vague épidémie : Les établissements hospitaliers publics, privés et solidaires d’Ile-de-France vont devoir déprogrammer 80 % des soins, deux fois plus qu’aujourd’hui, …
Free passe à l’offensive sur le marché des télécoms d’entreprise
Concurrence : Après avoir dynamisé la concurrence sur les marchés de la téléphonie fixe, de l’Internet et du mobile, Free …
Climat : pourquoi le marché du carbone s’envole
matières premières : Le relèvement des objectifs climatiques européens attire les spéculateurs sur le marché européen des quotas d’émissions de …
Epargne : la collecte du Livret A au plus haut depuis douze ans
FINANCE : En février, les Français ont placé 3,77 milliards d’euros sur leurs livrets d’épargne réglementée (Livret A et LDDS). C’est …
Washington prépare un plan gigantesque pour ses infrastructures
INVESTISSEMENTS : Trois mille milliards de dollars. C’est l’ampleur du plan sur lequel travaillent les conseillers de Joe Biden pour …
L’Humanité journal du 24 mars 2021

Obtenir le journal › Bonne nouvelle Dans le centre-ville d’Argentan (Orne), des archéologues ont mis au jour une chapelle datant du Moyen Âge. Les fouilles ont …
Gaspard Fontaine
Il n’a que 19 ans, mais la force de son engagement en fait déjà un militant aguerri. Cet insoumis, étudiant en …
Ne tirez pas sur l’ambulance !
Au petit matin, à Rangoun, il est de plus en plus difficile de reconnaître les rues laissées la veille. L’odeur …
L’actualité sur l’Humanité.fr
Croizat au Panthéon À l’initiative de l’Humanité, élus, syndicalistes et intellectuels interpellent le président de la République afin que le …
Dette morale
La mise en attente dans un vestibule d’horreurs excite notre appétit pour la solution d’une énigme enfin trouvée. Celle de …
La Presse de la Manche journal du 24 mars 2021

Obtenir le journal › The New York Times International Edition journal du 24 mars 2021

Obtenir le journal › Centre Presse Aveyron journal du 24 mars 2021

Obtenir le journal › Covid-19.La situation se dégrade et devient inquiétante en Occitanie En chiffres La région Occitanie reste parmi les moins touchées de l’Hexagone. Pour autant, et en particulier ces dix derniers jours, «l’épidémie …
Firmi Un automobiliste met en danger la vie des policiers
Un homme de 30 ans a été interpellé dimanche 21mars vers 15heures à Firmi puis placé en garde à vue …
Agriculture.Les éleveurs de plus en plus inquiets de la future Pac
La première mouture du projet est très défavorable aux exploitations bovines. De quoi mettre directement en danger l’élevage aveyronnais selon …
Environnement.L’État au chevet des forêts pour mieux les valoriser 40 arbres plantés, ce jeudi 25mars, sur l’Aubrac Ressources: peu d’attrait en Aveyron à cause du morcellement En chiffres En chiffres 40 arbres plantés jeudi 25mars sur l’Aubrac
C’est remarquable ! Il faut saluer le plan de relance avec la prise de conscience de l’État » , fait …
À votre service
RÉDACTION 8-10, av. Victor-Hugo12021 Rodez Cedex 905 81191200Fax : 05 81 19 12 01redaction@centrepresse.comAbonnement et portage à domicile : https://abonnement.centrepresseaveyron.frou …
Ouest-France journal du 24 mars 2021

Obtenir le journal › La croissance encore trop aquavore La plupart des médias ont séché sur le sujet. La Journée mondiale de l’eau avait lieu lundi. L’actualité française n’en …
Coup de pression sur les vaccins
En visite hier à Valenciennes, Emmanuel Macron a exhorté à vacciner « matin, midi et soir ». Le gouvernement met la pression …
Affaire Magali – « C’était une femme extraordinairement ordinaire »
L’avocat de la famille.Pages 3 …
Chine – La tension monte avec ses voisins et l’Occident
…
Magali, « une femme extraordinairement ordinaire »
Ils sont aujourd’hui centrés sur leur souffrance et l’absence abyssale de Magali. William Pineau, l’avocat des parents de la victime, …
L’Est éclair journal du 24 mars 2021

Obtenir le journal › L’Éclair des Pyrénées journal du 24 mars 2021

Obtenir le journal › Presse Océan journal du 24 mars 2021

Obtenir le journal › Stop Carnet promet de nouvelles actions Résistance. « On ne va rien lâcher ». Gabriella Marie, l’une des porte-parole du collectif Stop Carnet, a mal vécu hier l’évacuation …
Le Carnet évacué au bout de sept mois de Zad
Un peloton d’une trentaine personnes masquées, disciplinées, visiblement fatiguées, marchant le long de la RD 723 en direction de Paimbœuf. …
L’avenir du site est toujours aussi flou
Évacuation, et puis quoi ? L’avenir du site du Carnet interroge toujours, encore plus après l’intervention des gendarmes pour expulser les …
Le maire de Saint-Viaud : « Que les esprits s’apaisent »
Pour Roch Chéraud, ce retour à la normalité était attendu depuis de longues semaines. Le maire de Saint-Viaud, l’une des …
Un vaccin recommandé aux plus de 55 ans
Contactée vendredi, l’Agence régionale de santé des Pays de la Loire avait assuré ne pas être informée du cas du …
Le Télégramme journal du 24 mars 2021

Obtenir le journal › L’actu journal du 24 mars 2021

Obtenir le journal › Libération journal du 24 mars 2021

Obtenir le journal › le péril jeûne Enquête sur Thierry Casasnovas, un gourou prônant les jus de légumes contre le cancer ou le Covid, cristallisant les combats …
Covid long Avec les galériens du virus
Témoignages, pages …
NANCY SINATRA «A 20 ans, j’ai promis à mon père de faire un tube»
Interview, pages …
Régionales Pour Macron, la tentation du report
pages …
Hard-core
Arracheurs de dents à l’occasion, les vendeurs ambulants débitaient leurs boniments sur les marchés, allégeant les bourses de leurs crédules …
L’Equipe journal du 24 mars 2021

Obtenir le journal › OBJECTIF DUNE Puisqu’il n’y a plus de saison en ces temps chaotiques et bouleversés, puisque l’Euro 2020 aura lieu en 2021, puisque …
DD fait monter ses grognards
Contraints de rester à Clairefontaine à cause de cas de Covid-19 détectés au sein du personnel de leur hôtel d’Enghien-les-Bains, …
C’était un 7-1 trompeur
Confronté à un dilemme pour le poste de gardien (voir page 6), Andreï Chevtchenko a moins l’embarras du choix chez …
Rabiot, la confiance de DD
Rappelé par Deschamps en septembre, après le psychodrame d’avant la Coupe du monde 2018, quand il avait refusé d’être réserviste, …
Pogba
Paul Pogba avait quitté les Bleus, en novembre, au sortir d’un match XXL au Portugal (1-0, le 14) et d’une …
Corriere Della Sera journal du 24 mars 2021

Obtenir le journal › L’Union journal du 24 mars 2021

Obtenir le journal ›
L’Alsace journal du 24 mars 2021

Obtenir le journal › Le Bien Public journal du 24 mars 2021

Obtenir le journal ›
Nord Littoral journal du 24 mars 2021

Obtenir le journal › Mon Quotidien journal du 24 mars 2021

Obtenir le journal ›
La Voix du Nord journal du 24 mars 2021

Obtenir le journal › France-antilles Martinique journal du 24 mars 2021

Obtenir le journal › Le Courrier de L’Ouest journal du 24 mars 2021

Obtenir le journal › La transformation de Nazareth ANGERS. Il ne reste plus grand-chose aujourd’hui de cette verdure de novembre 2019 autour de l’ancien couvent de Nazareth. Le point …
L’UF Angers fait un pas de plus vers la montée en Ligue Féminine
Victorieuses de Chartres (90-64), les Angevinesconfortent leur place de leader de LF2. pages …
Les Résonances Saint-Martin à voir en ligne
Les guitaristes Titi Robin et Roberto Saadna donneront l’une des quatre créations du festival de la Collégiale à Angers. Performance, …
Un film saumurois vise le festival de Cannes
Le film « Umami no tabi », avec Gérard Depardieu et Pierre Richard, est en plein montage à …
« Parler de syndicat, c’est péjoratif »
Témoignages Olivier est un cas rare. Pourquoi ? Parce que ce salarié d’une très petite entreprise du Choletais, qui préfère rester anonyme, …
Le Maine Libre journal du 24 mars 2021

Obtenir le journal › « Ici, on sait prendre le temps de vivre » Fresnay-sur-Sarthe. Les habitants ont témoigné de leur attachement à leur commune inscrite au concours de l’émission de France 3 « Le …
À Allonnes, l’école Massenet ferme pendant une semaine
Après la campagne de tests salivaires, des enfants ont été dépistés positifs dans chaque classe de maternelle. Page …
Nuisances : les riverains de la LGV attendent toujours des réponses
L’association réclame, entre autres, l’aménagement d’équipements anti-bruit tout au long des voies. Page …
« Erman Kunter a tiré le meilleur de moi-même »
Antoine Eïto a joué son 250e match sous le maillot du MSB contre Orléans le 20 mars. L’occasion pour le …
Que du « positif » pour Asnières-sur-Vègre
Jean-Pierre Bourrely était maire d’Asnières-sur-Vègre quand la société de production l’a contacté, lui annonçant qu’Asnières-sur-Vègre avait été retenu pour participer …
Le Dauphiné Libéré journal du 24 mars 2021

Obtenir le journal › Courrier Picard journal du 24 mars 2021

Obtenir le journal › La Dépêche du Midi journal du 24 mars 2021

Obtenir le journal › Vaccination : Macron veut accélérer Donner à voir pour mieux tourner la page. Alors que depuis jeudi soir, les annonces du troisième confinement ont provoqué …
Montée au front
La prise de parole d’Emmanuel Macron hier à l’occasion d’un déplacement dans un centre de vaccination à Valenciennes (Nord) était …
« Le décalage entre les annonces et la réalité de terrain »
Si officiellement, Toulouse a commencé sa campagne de vaccination hier… « Nous, nous devons recevoir nos deux flacons, soit 20 …
Quand ces centres vont-ils voir le jour
Longtemps réticent à l’idée de mettre en place des vaccinodromes pour la campagne de vaccination en France, le gouvernement a …
Macron : « Il y aura des tentatives d’ingérence dans l’élection présidentielle »
turquie > Macron : « Il y aura des tentatives d’ingérence dans l’élection présidentielle ». Le président Emmanuel Macron, interrogé …
Charente Libre journal du 24 mars 2021

Obtenir le journal › Le Petit Quotidien journal du 24 mars 2021

Obtenir le journal ›
La République des Pyrénées journal du 24 mars 2021

Obtenir le journal › La Dernière Heure/Les Sports journal du 24 mars 2021

Obtenir le journal › La Tribune quotidien journal du 24 mars 2021

Obtenir le journal › « La crise a accéléré le mouvement tectonique vers l’investissement durable » (Stéphane Lapiquonne, BlackRock) LA TRIBUNE – En un an, les indices boursiers sont passés du krach à l’exaltation. Comment voyez-vous la sortie de …
Relance : une rallonge de 300 millions d’euros pour soutenir l’industrie
"La relance avance malgré la situation sanitaire" a assuré le ministre de l’Economie Bruno Le Maire. Près d’un an après …
StopCovid/TousAntiCovid : Anticor porte plainte contre Olivier Véran pour "favoritisme"
Anticor le dénonçait depuis le mois de juin 2020 (lien : https://www.latribune.fr/technos-medias/internet/l-application-stopcovid-un-ratage-spectaculaire-850914.html), elle passe désormais à l’action
La concentration dans le secteur du bio suscite des interrogations (2/3)
La concentration dans le secteur de la distribution bio se poursuit. Après l’acquisition de l’enseigne bordelaise So.bio en 2018 (lien …
Loi climat, logement: « Fichez-nous la paix ! », s’agace le patron du bâtiment
De la même manière que 2020 n’a pas été une réussite pour la production de logements neufs (lien : https://www.latribune.fr/entreprises-finance/industrie/biens-d-equipement-btp-immobilier/crise-du-log
Sud Ouest journal du 24 mars 2021

Obtenir le journal › The Independent journal du 24 mars 2021

Obtenir le journal › Le Parisien journal du 24 mars 2021

Obtenir le journal › Un week-end sous cloche… mais avec cérémonies religieuses La France vivra-t-elle une fête de Pâques quasi sous cloche ? Pour Jean Castex, la réponse est on ne peut plus claire. Dans …
Vaccination Le gouvernement veut (encore) accélérer
Une série d’annonces en forme de contre-attaque. Voilà dix jours que l’exécutif est acculé par la suspension — temporaire mais …
Confinement : de nouvelles zones sur la sellette
Hier matin, Benjamin Clouzeau, réanimateur au CHU de Bordeaux (Gironde), a accepté quatre nouveaux cas de Covid-19 dont deux avaient moins …
Sur les régionales, Matignon suivra l’avis du conseil scientifique
Ce n’est désormais plus qu’une question de jours. L’avis du conseil scientifique sur le déroulement des élections régionales et départementales …
La fonction publique peine à généraliser le télétravail
Télétravailler est presque devenu un geste barrière. Et l’Etat n’entend pas être pris en défaut, à l’heure où certaines entreprises sont …
Al Bayane journal du 24 mars 2021

Obtenir le journal › Le Figaro journal du 24 mars 2021

Obtenir le journal › L’Opinion journal du 24 mars 2021

Obtenir le journal › A 70 ans, Georges* s’est rendu ces dernières semaines à trois reprises dans un centre d’Asnières-sur-Seine (Hauts-de-Seine) avec son ordonnance … Jeunes-vieux: enquête sur les nouvelles fractures
Le repas s’était bien passé. Personne n’avait parlé de ce metteur en scène dont le Rosemary’s baby avait fait frissonner …
Covid: «J’aère régulièrement Matignon et je vaccine»
Une « troisième voie » impénétrable, un slogan « freiner sans enfermer » énigmatique, une attestation digne de Kafka, des …
Fuite de vaccins: la Commission européenne va durcir les règles
Alors que la France relance laborieusement sa campagne de vaccination contre la Covid, la Commission de Bruxelles a l’intention d’élargir …
« Les clivages sont plus marqués sur les sujets de société »
Les opinions sur les questions de société sont-elles différentes selon les générations ? Paradoxalement, les clivages sont plus marqués sur ces …
Le Journal de Saône et Loire journal du 24 mars 2021

Obtenir le journal › Centre Presse journal du 24 mars 2021

Obtenir le journal › AUTOhebdo journal du 24 mars 2021

Obtenir le journal › DRIVE TO SURVIVE Sans grande originalité, j’ai passé la majeure partie de mon week-end à ingurgiter la troisième saison de la série Netflix …
“SANS LES FREINS”
…
COURSES SPRINT POURQUOI ÇA COINCE ?
Alors qu’un consensus global semble s’être dégagé depuis des semaines au sein des teams sur la question des manches Sprint, …
LE TRACÉ DE DJEDDAH ENFIN DÉVOILÉ
Comme pour chaque nouveau circuit urbain, le théâtre du premier Grand Prix d’Arabie saoudite de l’histoire nous est vendu comme …
MERCEDES, VRAIMENT EN DIFFICULTÉ ?
Et si pour une fois ce n’était pas de la langue de bois ? Mercedes a si souvent crié au …
Ici Paris journal du 24 mars 2021

Obtenir le journal › Cover page En plein tournage, la comédienne de 53 ans s’est effondrée… Julien DORÉ Papa pour la 1re fois ! Brigitte & …
ici LE SOMMAIRE
Actualité P. 04 ici LES ÉCHOS P. 06 ici LES ÉCHOS d’ailleurs P. 08Mathilde SEIGNER P. 09Carla & Brigitte P. …
Les sourires de la semaine
Marie-Christine Barrault et Guy Marchand en mars …
Soul
Blu-Ray, 24,99 € DVD, 19,99 € Prof de musique dans un collège, Joe Gardner rêve depuis toujours de devenir jazzman. …
Haute Fidélité
Raphaël Columbia, 16,99 € Haute Fidélité (terme à prendre dans tous les sens ici) est un peu passé inaperçu, c’est …
Science et Vie journal du 24 mars 2021

Obtenir le journal › Sexisme originel Quand j’ai appris la découverte d’une jeune chasseuse, enterrée il y a 9 000 ans avec tout son attirail en …
ET POUR UNE DOUBLE ÉTOILE ?
Dans votre article sur les supernovae noires (S&V n° 1240), la théorie proposée correspond à un modèle isolé d’étoile. Or …
Qualifier un drone d’écologique
" Qualifier un drone d’écologique car sa seule émission est de la vapeur d’eau ( S&V n° 1242), c’est occulter …
VACCIN ANTI-COVID : FUSION VIRALE ?
Merci pour votre article sur les vaccins contagieux ( S&V n° 1241), certes un peu anxiogène ! Vous citez notamment …
GREFFE D’UTÉRUS : PREMIÈRE NAISSANCE FRANÇAISE
En février 2015, nous vous faisions part de la naissance du premier bébé né d’un utérus transplanté ( S&V n°1169). …
Grand Gibier journal du 24 mars 2021

Obtenir le journal › Le gibier sort du bois ! Privé d’un match musclé de rugby France-Écosse pour cause de Covid, le programme télévisé du jour proposait sur France 5 …
UN GOÛT DE TROP-PLEIN ?
Avec des prélèvements supérieurs à 1 500 cerfs dans 18 départements et à 2 000 têtes dans 8 départements, le …
EN FORÊT DE VERDUN
Ludwig Johar et son directeur de battue Étienne Delouche gèrent les 2 350 ha de forêts domaniales de Verdun, ainsi …
DE BONS PROCÉDÉS
Alors que la saison des dégâts sur prairies se poursuit et que les premiers semis ne tarderont pas, la fédération …
Quand le chat n’est pas là
Le confinement profite bien aux sangliers en terre girondine puisque dès 18 h, heure légale du couvre-feu, ces derniers ont …
Géo Histoire journal du 24 mars 2021

Obtenir le journal › Jeux Vidéo Magazine journal du 24 mars 2021

Obtenir le journal › Le Chasseur Français journal du 24 mars 2021

Obtenir le journal › Avril Lune montante : du 4 au 18. Lune descendante : du 1er au 3, et du 19 au 30. Au …
Le cycle de la vie
Coincé entre le printemps qui s’étire et l’été qui se rapproche, avril est un mois de transition. Pour peu que …
L’oiseau rare !
Bien souvent, nous traquons sa silhouette tendue comme un i, lorsqu’en alerte, il est plus que jamais l’invisible de la …
Bruits et odeurs de la campagne : un patrimoine sensoriel
Une loi a été promulguée fin janvier, visant à définir et à protéger le patrimoine sensoriel des campagnes françaises. Devant …
Plomb : le clap de fin
Les faits L’Agence européenne des produits chimiques (ECHA) vient de sonner l’assaut final contre l’utilisation du plomb dans les …
Le Journal de Mickey journal du 24 mars 2021

Obtenir le journal › Cover page 32 PAGES DE BD Quand les animaux changent de peau LE CONTE EST BON La fabuleuse histoire de Donaldrillon Quelles …
Sommaire
Quelles sont vos chouchous de l’année? N° 1 SOPRANO Tous les résultats de notre grand sondage annuel, p. 40 Quand …
c’est fou!
Chouette, un hibou! Ce hibou porte bien son nom de grand duc, ou grand duc d’Europe. C’est le plus imposant …
10 façons de rire selon les langues
En France, pour exprimer le rire, on pousse des «Ha, ha! Ho, ho! Hi, hi!» mais ce ainsi partout. Petit …
Photoblag
BIENVENUE À BORD! CONTRÔLE DES BILLETS, S’IL VOUS …
Les Veillées des Chaumières journal du 24 mars 2021

Obtenir le journal › Une heure pour la Terre Cette initiative 2007 nous vient d’Australie. Afin de sensibiliser les habitants au changement climatique et à la nécessité d’une transition …
Paul Signac, le peintre qui a libéré la couleur
La technique de Paul Signac consiste à tapisser sa toile de petites touches de couleurs pures. À quelques pas de …
Les dames des Trois-Îlets
Flora, peux-tu venir immédiatement ? J’ai renversé un vase dans ma chambre ! Viens nettoyer, dit sèchement Éléonore de La …
Franz Stock, l’archange des geôles allemandes
Le 28 février 1948, ils ne sont qu’une dizaine à accompagner la dépouille de Franz Stock au cimetière parisien de …
Li Shizhen, la médecine chinoise lui doit beaucoup !
Quand Li Shizhen naît, début juillet 1518, à Qizhou (dans la province actuelle du Hubei), la Chine est sous l’empire …
La Revue du Vin de France journal du 24 mars 2021

Obtenir le journal › Point de Vue journal du 24 mars 2021

Obtenir le journal ›
Psychologies Magazine journal du 24 mars 2021

Obtenir le journal › L’Echo de l’Armor et de l’Argoat journal du 24 mars 2021

Obtenir le journal ›
L’Éveil de Lisieux journal du 24 mars 2021

Obtenir le journal › L’Eveil Normand journal du 24 mars 2021

Obtenir le journal › Auto Plus Occasion journal du 24 mars 2021

Obtenir le journal › Des occasions à ne pas rater Une fois n’est pas coutume, c’est avec un dossier sur des voitures d’occasion accessibles à des budgets plutôt élevés (de …
Les 10 STARS qui arrivent en occasion
Comme sa cousine la VW Golf, l’A3 tarde à envahir nos rues. Mais il y a déjà pléthore de voitures …
Une bonne occasion pour 2 000 € ?
Impossible de trouver un diesel Crit’Air 2 à moins de 3 000 € en bon état. – Pour ceux qui …
La nouvelle galère des diesels ?
Les démarches Pour réclamer une prise en charge totale ou partielle (en fonction du barème ci-dessous), envoyez un courrier …
Volkswagen Tiguan (2016-…)
Ce test a été réalisé avec un Tiguan 2.0 TSI 180 de fin 2017, livré d’office avec la boîte auto. …
Le Courrier de l’Eure journal du 24 mars 2021

Obtenir le journal › Le Perche journal du 24 mars 2021

Obtenir le journal ›
L’Orne Hebdo journal du 24 mars 2021

Obtenir le journal › Le Réveil Normand journal du 24 mars 2021

Obtenir le journal › La Gazette du Comminges journal du 24 mars 2021

Obtenir le journal › Des papillons dans le ventre pour les lépidoptères «Le papillon est une fleur éprise de liberté qui vole. Il y a une grâce à l’observer. Il symbolise pour …
LE CUIVRÉE DES MARAIS DÉPLOIE SES AILES SUR LE COMMINGES
Parmi les centaines d’espèces de lépidoptères abondant dans la chaîne pyrénéenne, le « Lycanea Dispar », constitue selon Jean-Louis Fourrès …
UN LOUIS D’OR BIEN ÉVEILLÉ
Louis est venu au monde samedi 20 mars à 16h29 à la maternité de Saint-Gaudens. Du haut de ses 51 …
Plus qu’un guide, un compagnon de randonnée
Après deux premiers ouvrages, restitutions commentées et poétiques de ses pérégrinations naturalistes, Jean-Louis Fourrès a lancé il y a deux …
EMMA FIÈRE DE SA SŒUR LÉONIE
Léonie Bosc est née le lundi 15 mars 2021 à 02h06 à l’hôpital Joseph Ducuing à Toulouse. « Tout s’est …
Le Journal de Spirou journal du 24 mars 2021

Obtenir le journal › Le Courrier de Mantes journal du 24 mars 2021

Obtenir le journal ›
La Dépêche du Bassin journal du 24 mars 2021

Obtenir le journal › La Marne journal du 24 mars 2021

Obtenir le journal ›
Toutes Les Nouvelles journal du 24 mars 2021

Obtenir le journal › Abricot journal du 24 mars 2021

Obtenir le journal ›
Les P’tites Filles à la Vanille journal du 24 mars 2021

Obtenir le journal › Les P’tites Princesses journal du 24 mars 2021

Obtenir le journal ›
Meine Woche journal du 24 mars 2021

Obtenir le journal › National Geographic Kids journal du 24 mars 2021

Obtenir le journal ›
Quelle Histoire journal du 24 mars 2021

Obtenir le journal › Réponse à Tout ! journal du 24 mars 2021

Obtenir le journal ›
Tout Comprendre Junior journal du 24 mars 2021

Obtenir le journal › Ici Paris Hors – Série journal du 24 mars 2021

Obtenir le journal ›
Sorcières journal du 24 mars 2021

Obtenir le journal › Mille et Une Histoires journal du 24 mars 2021

Obtenir le journal ›
Papoum journal du 24 mars 2021

Obtenir le journal › Pirouette journal du 24 mars 2021

Obtenir le journal › HorsSerie_ScAvenir journal du 24 mars 2021

Obtenir le journal › Cacophonie alimentaire Vous voilà aux fourneaux, mijotant un bœuf bourguignon. De délicieux effluves d’ail et d’oignon flattent vos narines, les lardons rissolent, …
« Se nourrir, se réunir, se réjouir »
Alors que manger pourrait constituer l’acte le plus simple du monde, le contenu de notre assiette nous angoisse de plus …
NOS ASSIETTES À LA LOUPE
…
LES 20 CONSEILS du Dr Laurent Chevallier, nutritionniste
Se référer à quelques règles de base La notion d’interdit strict de tel ou tel aliment n’a pas de …
VIANDE ET POISSON
Une base de protéines essentielles à l’organisme Viandes, poissons et œufs apportent des protéines animales constituées des vingt acides …
La Gazette de la Manche journal du 24 mars 2021

Obtenir le journal › Comment ca marche journal du 24 mars 2021

Obtenir le journal ›
Histoires Vraies journal du 24 mars 2021

Obtenir le journal › Wapiti journal du 24 mars 2021

Obtenir le journal ›
Terre Sauvage journal du 24 mars 2021

Obtenir le journal › Phosphore journal du 24 mars 2021

Obtenir le journal ›
Géo Ado journal du 24 mars 2021

Obtenir le journal › J’apprends à lire journal du 24 mars 2021

Obtenir le journal ›
Julie journal du 24 mars 2021

Obtenir le journal › Pomme d’Api journal du 24 mars 2021

Obtenir le journal ›
Histoires pour les petits journal du 24 mars 2021

Obtenir le journal › J’aime Lire journal du 24 mars 2021

Obtenir le journal ›
Okapi journal du 24 mars 2021

Obtenir le journal › Graffiti Art journal du 24 mars 2021

Obtenir le journal › Toujours en kiosque
Tout Lyon Essor Rhone 20 mars 2021

Obtenir le journal › Courrier Français 19 mars 2021

Obtenir le journal ›
Le Drenche 23 mars 2021

Obtenir le journal › Revue des Comptoirs 23 mars 2021

Obtenir le journal › Conformément à la loi Informatique et Libertés du 06 janvier 1978, vous bénéficiez d’un droit d’accès, de rectification et de suppresion des données personnelles qui vous concernent. Vous pouvez exercer ces droits auprès de ePresse en écrivant à l’adresse suivante : TOUTABO 59 rue spontini 75116 Paris, à laquelle vous pouvez également exercer un droit d’opposition à recevoir des offres commerciales. Pour vous désinscrire de cette revue de presse, rendez-vous sur cette page.
TOUTABO, SA au capital de 488 213.90 euros, RCS Paris 480 467 000, 59 rue Spontini 75116 Paris
Les Unes de l’Actu du 23/03/2021
La Nouvelle République des Pyrénées journal du 23 mars 2021

Obtenir le journal › Les bonnes nouvelles La vie n’est pas qu’un long fleuve noir, intranquille, qui charrie turpitudes (complotistes de toutes natures et plus souvent contre …
Une venue au monde épique pour Louka
C’est un événement qu’ils avaient soigneusement préparé. Des mois de lectures, de programmes dédiés, de formation avec une sage-femme pour …
Fort recul en février
Dans un communiqué diffusé le 22 mars, l’Insee publie les données de l’ensemble des décès, toutes causes confondues, du 1er …
Article
Tarbes> Les agriculteurs perturbent le trafic routier. La circulation a été fortement perturbée, hier après-midi sur la D817, route de …
Une nouvelle fenêtre de développement pour Isia
Au-dessus de la RN21, la crise semble avoir épargné la société Isia. Cette entreprise qui déploie des ERP, des solutions …
Quotidien Numérique d’Afrique journal du 23 mars 2021

Obtenir le journal › Mon Quotidien journal du 23 mars 2021

Obtenir le journal ›
Le Télégramme journal du 23 mars 2021

Obtenir le journal › Al Bayane journal du 23 mars 2021

Obtenir le journal ›
L’Est éclair journal du 23 mars 2021

Obtenir le journal › Dordogne Libre journal du 23 mars 2021

Obtenir le journal › Libération journal du 23 mars 2021

Obtenir le journal › NUS En 1917, Modigliani de l’émoi à l’émeute …
pourquoi pas nous ?
Quand les Etats-Unis, le Royaume-Uni ou Israël piquent à tour de bras, seuls 2,4 millions de Français ont pour l’instant reçu leurs …
PRÉCARITÉ L’hébergement d’urgence à visage humain
…
DROITS SOCIAUX Amazon en guerre contre les syndicats
…
Intendance
Nous revoilà donc avec «l’intendance suivra». Essayant de rattraper le temps perdu depuis le début de la vaccination mondiale, l’exécutif …
L’Equipe journal du 23 mars 2021

Obtenir le journal › KYKY FAIT LE MÛR DÉCINES (Rhône) – La démonstration du PSG face à l’OL (4-2, dimanche) s’est achevée depuis quelques minutes. À proximité du …
« Quand je le vois, je me régale »
« Qu’avez-vous pensé à la lecture de “L’Équipe”, lundi matin, en découvrant que Kylian Mbappé avait battu votre record en marquant son …
LA POSSESSION, ET VITE !
Le PSG, cette équipe de possession à outrance qui s’inspirait du modèle barcelonais sous l’ère de Laurent Blanc au milieu …
Paris moins déplumé qu’à l’accoutumée
Ces deux prochaines semaines, le Camp des Loges continuera de résonner au son des « vamos » de la colonie sud-américaine parisienne. …
Lille est las
Contre Nîmes (1-2, dimanche), c’était l’équipe type lilloise du moment, à deux exceptions près : Jonathan Ikoné avait déclaré forfait le …
l’Indépendant journal du 23 mars 2021

Obtenir le journal › «Avec pudeur et humilité» Que représente pour vous et le groupement de gendarmerie de l’Aude cette date du 23mars 2018?A titre personnel, ça reste …
Le Train Rouge à nouveau sur les rails pour Pâques
À l’arrêt depuis la tempête Gloria, le Train Rouge se relance. Un glissement de terrain qui s’était produit fin janvier2020, …
La mortalité en baisse de 11% par rapport à 2018-2019
Comme toujours, les chiffres sont à prendre avec des pincettes. Les dernières données disponibles au 18mars 2021 «», prévient le …
Incendies en série
Ce dimanche soir, les pompiers étaient sur tous les fronts avec des départs de feu se multipliant en raison de …
Incendie mortel: la garde à vue de l’ex-compagnon prolongée… dans le doute
Le mystère reste entier sur les causes exactes du décès d’une femme âgée de 55 ans à la suite de …
Le Maine Libre journal du 23 mars 2021

Obtenir le journal › Ça coince un peu au niveau du rond-point de l’Océane Durant la semaine, en début de matinée, il faut compter environ quinze minutes pour franchir la zone en travaux. Page …
Dépistages à l’école : un exercice bien rodé
Reportage. À Allonnes, 104 des 109 élèves de l’école Jules-Massenet se sont prêtés, hier, au dépistage salivaire du Covid-19. Les parents recevront …
« J’apprends à connaître mes aptitudes »
Installé en Sarthe depuis 2018, Florian Maitre, 24 ans, dispute sa 2e saison chez les pros avec Total Direct Énergie. Encore …
Gratto’Folies : aujourd’hui votre troisième carte
Alors que la 3e semaine de jeu démarre aujourd’hui, nous avons déjà récompensé près de mille gagnants. Page …
Des délais d’organisation resserrés
Le dépistage s’est organisé au pas de course à l’école Massenet raconte le directeur, Arnaud Perrotin : On a été informés …
La Presse de la Manche journal du 23 mars 2021

Obtenir le journal › Le Bien Public journal du 23 mars 2021

Obtenir le journal › La Dépêche du Midi journal du 23 mars 2021

Obtenir le journal › Covid-19 : l’Occitanie face à la troisième vague Le nombre de départements en rouge vif sur la carte de France du taux d’incidence au Covid-19 ne cesse d’augmenter. …
Trop peu, trop tard ?
« Les semaines devant nous seront difficiles. La vague monte » concédait ce dimanche le ministre de la Santé Olivier …
« Il faut s’attendre à un pic des patients en réanimation »
16 départements sont confinés depuis ce week-end. En Occitanie, devrions-nous anticiper un confinement ? Si nous observons les chiffres de …
à Montauban, malgré la hausse du taux d’incidence, la vie continue
« Je ne savais même pas que les chiffres augmentaient à ce point ! ». Olivier, derrière le comptoir du …
Condamnation et consternation après la tenue d’un carnaval sauvage
« Nous allons poursuivre les responsables. » Au lendemain de la tenue d’un carnaval sauvage qui a réuni, au mépris …
Centre Presse Aveyron journal du 23 mars 2021

Obtenir le journal › Justice.Prison ferme après des violences sur sa compagne et son enfant Les faits ont eu lieu la semaine dernière, à Lunac.Face aux juges du tribunal judiciaire de Rodez, le prévenu peine …
400
Soit le nombre de vaccins reçus par l’hôpital Jacques-Puel de Rodez. De nouvelles doses du vaccin Pfizer qui vont permettre …
Société.Découvrir l’engagement sous toutes ses formes
Les dispositifs facilitant l’engagement de nos concitoyens sont en plein essor en France et en Aveyron.Il s’agit notamment:- duService national …
La Cavalerie Un légionnaire exclu, après la diffusion de vidéos néonazies
« Ça s’est passé chez nous, il n’y a aucun doute. Bien évidemment, je n’étais pas au courant. » Au …
Villeneuve-d’Aveyon Un blessé léger dans une collision entre deux véhicules
Hier matin un accident a eu lieu à la sortie de Villeneuve-d’Aveyron. Aux alentours de 11heures, une voiture est entrée …
Le Figaro journal du 23 mars 2021

Obtenir le journal › La Nouvelle République journal du 23 mars 2021

Obtenir le journal › La Marseillaise journal du 23 mars 2021

Obtenir le journal › Titre sur 4 lignes procès guérini Photo AFP À l’entame de la deuxième semaine de procès, le tribunal correctionnel de Marseille s’est penché sur …
Article
Photo J.N. Aix-en-provence Vaccination jackpot pour les médecins à l’acte ? Des praticiens du centre de vaccination multiplieraient par dix …
Article
Aubagne Objectif zéro déchet Le conseil de territoire du Pays d’Aubagne et de l’Étoile lance un programme test de réduction …
Article
27926 – 0323 – 1,40 E bouches-du-rhône et var 1,40 E http://www.lamarseillaise.fr Mardi 23 mars 2021 – …
Titre sur 2 lignes
hospitalisations en hausse Pandémie et confinements ont percuté un secteur psychiatrique laminé par des années d’abandon. P. 2 et …
The Guardian journal du 23 mars 2021

Obtenir le journal › La Voix du Nord journal du 23 mars 2021

Obtenir le journal › La Croix journal du 23 mars 2021

Obtenir le journal › Économiser l’eau L’eau n’a pas de prix, et pourtant il est utile de lui en donner un. Tel est le paradoxe auquel …
Un livre sur « le monde face à la pandémie »
Le livre Pourquoi êtes-vous si craintifs ? N’avez-vous pas encore la foi ? qui paraît mercredi 24 mars, est édité par Bayard et …
« C’est le Christ qui m’a ouvert les portes de cette prison »
De mars à juin, nous n’avons pas pu rencontrer les détenus, et les célébrations religieuses n’ont repris qu’en décembre. Nous …
Faut-il revoir l’ordre de priorité vaccinale ?
Alors que le taux de vaccination des résidents d’Ehpad et, dans une moindre mesure, des plus de 75 ans progresse, …
Islam (suite)
Je reviens sur votre dossier consacré aux difficultés que l’islam peut soulever aujourd’hui. Il paraît dommage qu’il n’ait pas abordé …
Corse Matin journal du 23 mars 2021

Obtenir le journal › L’Ardennais journal du 23 mars 2021

Obtenir le journal › L’Humanité journal du 23 mars 2021

Obtenir le journal › Un vaccin trop vert ? « Il est trop vert et bon pour des goujats. » On pourrait presque paraphraser la fable de La Fontaine le …
Bonne nouvelle
Le salaire minimum va augmenter sensiblement au Qatar, pour atteindre un euro de l’heure. Il va passer de 173 euros (750 rials) …
Marie Portolano
Journaliste sportive, c’est une vocation qui remonte à l’enfance pour Marie Portolano. Oui mais, dans le sport, les femmes sont …
Sylvie Dubois, une candidature cousue de fil rouge
Orléans (Loiret), correspondance. Derrière une frange blonde bordée par un regard clair et franc, Sylvie Dubois affiche sa détermination. …
En Aveyron, le gisement de la solidarité n’est pas épuisé
Aveyron, envoyée spéciale. Une marée humaine pour défendre l’emploi. Dimanche, à Decazeville (Aveyron), 3 200 salariés, syndicalistes, élus politiques de tous …
Le Parisien journal du 23 mars 2021

Obtenir le journal › Le Covid, même plus peur ! Devant l’unité Covid, barrée par un digicode, une affiche a été ajoutée à l’entrée. « Merci de refermer la porte derrière …
« Je ne vais pas en mourir si je l’ai »
Devant « Koh-Lanta », vendredi, ils étaient cinq. Trois, le lendemain, à répéter une chorégraphie de street jazz. Quatre, samedi après-midi, à …
Au moins 35 « vaccinodromes » vont ouvrir
C’est un mot avec lequel il va falloir se familiariser et que l’épidémie va rendre populaire : « vaccinodrome ». Le ministre de la …
« On va droit dans le mur »
Dans sa voix, il y a un peu de lassitude, mais surtout de l’inquiétude. Celle de devoir faire moins bien …
Le double risque du président
« Emmanuel Macron sait qu’il prend un risque. Et ce n’est pas un hasard, d’ailleurs, si c’est Jean Castex qui a …
Le Républicain Lorrain journal du 23 mars 2021

Obtenir le journal › La Libre Belgique journal du 23 mars 2021

Obtenir le journal › Le Courrier de L’Ouest journal du 23 mars 2021

Obtenir le journal › Belle-Beille se prépare pour sa « Grande Lessive » jeudi Le centre Tati propose une journée d’animationsà destination des scolaires et des habitants. …
La transmission respectée sur le bout des plumes
…
Ces start-up choisissent Angers
Économie. Comme de nombreux entrepreneurs, Thomas Valentin et Jean Toselli ont quitté leur vie parisienne pour faire grandir leur agence …
Gratto’folies : votre troisième carte à gratter
La troisième semaine de jeu démarre. Nous avons déjà récompensé près de mille gagnants. Page …
Pénurie de dons : le Secours populaire en état d’alerte
Alors que le mécénat se concentre sur les soignants et la recherche, les associations d’entraide voient leurs moyens menacés. Le …
Ouest-France journal du 23 mars 2021

Obtenir le journal › Ille-et-Vilaine – Meurtre de Magali : que reproche-t-on aux beaux-parents ? Le procureur de Rennes. …
Football – Ousmane Dembélé, les dessous d’un renouveau
…
Ces « entreprises à mission » qui ne visent pas le seul profit
Depuis une loi de 2019, les sociétés peuvent inscrire dans leurs statuts des « missions » : réduction de l’empreinte carbone, utilisation de …
Pour une fraternité universelle
Voici deux semaines, le pape François rentrait de son voyage historique en Irak. Depuis, son appel à la fraternité universelle …
AstraZeneca : enquête après un décès
Un étudiant de 24 ans, a été retrouvé mort, jeudi, dans son appartement du boulevard Vincent-Gâche, à Nantes. Originaire de La …
Le Veinard journal du 23 mars 2021

Obtenir le journal › Aisne Nouvelle journal du 23 mars 2021

Obtenir le journal ›
Sud Ouest journal du 23 mars 2021

Obtenir le journal › L’Est Républicain journal du 23 mars 2021

Obtenir le journal › Les Echos journal du 23 mars 2021

Obtenir le journal › Ce que va changer la taxe carbone européenne Le projet d’instaurer une taxe carbone aux frontières de l’UE aura des conséquences commerciales directes pour les secteurs concernés. Il …
La Turquie fragilisée par la chute de sa monnaie
Marchés : La devise turque et la Bourse d’Istanbul ont plongé de 10 % après le limogeage surprise du gouverneur …
Vaccins : Londres baisse d’un ton pour éviter le clash avec l’Europe
NéGOCIATIONS : Pour éviter un arrêt brutal des exportations du vaccin AstraZeneca par Bruxelles qui tient à ce qu’on lui …
Le plan de Bercy pour faire face à la dette Covid
DEFICIT : Même si le « quoi qu’il en coûte » est encore loin de sa ligne d’arrivée, il faut déjà l’anticiper. …
Surcroît d’épargne : Bercy prêt à un geste pour les petites donations
Avec le « quoi qu’il en coûte », les critiques sur le « président des riches » se sont faites moins récurrentes …
Le Petit Bleu d’Agen journal du 23 mars 2021

Obtenir le journal › Le journal duSUA l Le SUA reprend le chemin du Top 14, ce samedi, à Brive. Là où il avait gagné l’année dernière. …
Prêts à payer plus d’impôts sur l’Agglo ?
Le conseil de l’agglomération d’Agen se tiendra dans la soirée du 25 mars, à Foulayronnes – retransmission à suivre en …
Vous qui passez sans me voir… fleurs sauvages et urbaines
Il fut un temps où les villes refusaient toute végétation libre. La moindre pousse d’herbe était immédiatement et copieusement arrosée …
Nigelle de Damas et « Ruine de Rome »…
Le Museum national d’histoire naturelle à Paris, le MNHN, a mis en place un observatoire via le programme « sauvages …
Frédéric Tournay sera le nouveau patron des pompiers de Lot-et-Garonne
Saint-Sixte > Un incendie ravage un hangar. Ce dimanche 21 mars, un incendie s’est déclaré dans un hangar sur la …
Charente Libre journal du 23 mars 2021

Obtenir le journal › Libération Champagne journal du 23 mars 2021

Obtenir le journal ›
L’actu journal du 23 mars 2021

Obtenir le journal › L’Éclair des Pyrénées journal du 23 mars 2021

Obtenir le journal ›
The Independent journal du 23 mars 2021

Obtenir le journal › La République des Pyrénées journal du 23 mars 2021

Obtenir le journal › La Tribune quotidien journal du 23 mars 2021

Obtenir le journal › Télécoms d’entreprise : Free vient défier Orange en cassant les prix Xavier Niel aime se mettre en scène. Dans une campagne de communication sur la Toile, le fondateur et propriétaire d’Iliad, …
Austin, nouvelle capitale de la tech américaine ?
Chaque année, à l’approche des premiers frimas, des hordes d’oiseaux parcourent le ciel texan. Certains ne font que passer pour …
Alimentation: l’attirance pour le bio des Français augmente
La crise sanitaire n’a pas infléchi la tendance. Les aliments bio, dont le marché n’a cessé d’afficher une croissance à …
« Austin va devenir un centre majeur de la tech dans les dix prochaines années »
Investisseur historique de la Silicon Valley, Jim Breyer a fait carrière chez Accel Partner, où il a misé 12,7 millions …
Les entreprises du bio ont connu une croissance soutenue en 2020 (1/3)
« A chaque crise sanitaire, son regain d’intérêt pour le bio. Cela réveille un esprit de sécurisation chez les consommateurs. …
Les Dernières Nouvelles d’Alsace journal du 23 mars 2021

Obtenir le journal › The New York Times International Edition journal du 23 mars 2021

Obtenir le journal › L’Opinion journal du 23 mars 2021

Obtenir le journal › L’impôt sur les sociétés va-t-il servir à payer la dette ? « Un débat sur la dette trois fois par semaine jusqu’à atterrissage du quoi qu’il en coûte. » C’est en …
Elections régionales: l’enjeu démocratique du vote en juin
La France serait-elle la seule nation à se montrer incapable d’organiser des élections en temps de Covid ? Elle qui …
Biden: Joe le cogneur
Cogner d’abord et parler ensuite. Les Américains appellent cela la « bloody-nose strategy », la stratégie du bourre-pif. C’est manifestement celle choisie …
En Asie, Joe Biden parie sur le Quad pour contrer la Chine
« Nous allons rétablir nos alliances et nous engager à nouveau dans le monde, non pas pour relever les défis …
Dissuasion nucléaire: des fissures dans le «bunker» français
La récente parution dans l’Opinion d’un entretien avec deux chercheurs sur la crédibilité de notre dissuasion nucléaire a suscité un …
Presse Océan journal du 23 mars 2021

Obtenir le journal › « Un comportement irresponsable » Impuissance. « L’événement de ce week-end a été organisé sans autorisation, ni même demande d’autorisation […] qui aurait été refusée par …
Le carnaval sauvage de Rezé ne fait pas rire
Les chaînes de télé en continu diffusent depuis dimanche les images des 6 500 carnavaliers rassemblés à deux pas de la Canebière, …
« Ce sont les habitants qui l’ont organisé »
À Rezé, le collectif de la Commune, directement mis en cause par la municipalité, rejette toute responsabilité dans le carnaval …
AstraZeneca : enquête sur le décès d’un Nantais
Une mort incompréhensible . Le corps sans vie d’Anthony R., étudiant de 24 ans, qui s’apprêtait à boucler sa 6e année de …
Christelle Morançais rappelle l’État à ses engagements
Christelle Morançais (LR), présidente de la région Pays de la Loire, vient d’écrire à Jean-Baptiste Djebbari, ministre délégué chargé des …
Midi Libre journal du 23 mars 2021

Obtenir le journal › Chaises musicales C’est quasiment à un jeu de chaises musicales que se livrent en ce moment les commerçants mendois: Saveur gour’Mende déménage …
Le dernier numéro de Patrimòni
Le nouveauPatrimòni(n°91) de mars et avril, le magazine des patrimoines de l’Aveyron et de ses voisins, est paru. Le nouveau …
Un Alésien concourt pour la deuxième fois au Nikon film festival
C.Thibaud et J.Attard ont tourné dans un appartement parisien.Deux minutes et vingt secondes pour épater Éric Judor, notamment. Le compère …
Un président d’Agglo qui a inauguré aussi Nemausa et la Smac PalomaUn président d’Agglo qui a inauguré aussi Nemausa et la Smac Paloma
Si cette année, Jean-Paul Fournier célèbre ses vingt-ans à la tête de la mairie, il ne faut pas oublier qu’il …
Constant Tchouassi : « On part en conquête »
Vous êtes en demi-finale d’accession en Ligue A. Quels sentiments éprouvez-vous?Énormément de fierté tout d’abord. Car c’est la première demi-finale …
Courrier Picard journal du 23 mars 2021

Obtenir le journal › Le Petit Quotidien journal du 23 mars 2021

Obtenir le journal › Ouest-France édition France journal du 23 mars 2021

Obtenir le journal › Vie quotidienne – Les paniers-repas à cuisiner chez soi ont la cote Page Vie …
Pour une fraternité universelle
Voici deux semaines, le pape François rentrait de son voyage historique en Irak. Depuis, son appel à la fraternité universelle …
Ces « entreprises à mission » qui ne visent pas le seul profit
Depuis une loi de 2019, les sociétés peuvent inscrire dans leurs statuts des « missions » : réduction de l’empreinte carbone, utilisation de …
Football – Ousmane Dembélé, les dessous d’un renouveau
…
Un recueil de noms de rues porteurs de diversité
Entretien Les personnalités issues de la diversité sont-elles les grandes absentes des plaques de nos rues, places, etc. ? Oui et non. Sur les …
L’Union journal du 23 mars 2021

Obtenir le journal › La Dernière Heure/Les Sports journal du 23 mars 2021

Obtenir le journal ›
Nord Littoral journal du 23 mars 2021

Obtenir le journal › Centre Presse journal du 23 mars 2021

Obtenir le journal ›
L’Alsace journal du 23 mars 2021

Obtenir le journal › France-antilles Martinique journal du 23 mars 2021

Obtenir le journal ›
Le Progrès journal du 23 mars 2021

Obtenir le journal › Corriere Della Sera journal du 23 mars 2021

Obtenir le journal ›
Le Dauphiné Libéré journal du 23 mars 2021

Obtenir le journal › Nord éclair journal du 23 mars 2021

Obtenir le journal ›
La Provence journal du 23 mars 2021

Obtenir le journal › Paris-Normandie journal du 23 mars 2021

Obtenir le journal ›
Le Journal de Saône et Loire journal du 23 mars 2021

Obtenir le journal › France Football journal du 23 mars 2021

Obtenir le journal › Nous Deux journal du 23 mars 2021

Obtenir le journal › Le bonheur d’être étonné La vie nous réserve toujours des surprises. Parfois, elles ne sont pas très bonnes (nous en avons eu un certain …
Vivre d’amour enchaînés
Le mois dernier, deux jeunes Ukrainiens se sont lancé un défi que l’on ne sait pas trop comment qualifier. Pour …
Le dessin de la semaine
…
46
C’EST, EN MILLIONS D’EUROS, LE PRIX EXORBITANT QUE DEMANDE L’ACTEUR JOHNNY DEPP pour céder son domaine de 15 hectares, au …
Paris reprend des couleurs
Pas besoin de vivre dans la capitale pour connaître les mythiques colonnes Morris. Depuis la fin du XIXe siècle, les …
L’Eclaireur – La Dépêche journal du 23 mars 2021

Obtenir le journal › Eure Infos journal du 23 mars 2021

Obtenir le journal ›
Les Informations Dieppoises journal du 23 mars 2021

Obtenir le journal › Le Pays Briard journal du 23 mars 2021

Obtenir le journal ›
L’Eveil Pont-Audemer journal du 23 mars 2021

Obtenir le journal › Le Bulletin de Darnétal journal du 23 mars 2021

Obtenir le journal ›
Le Pays d’Auge journal du 23 mars 2021

Obtenir le journal › Le Drenche journal du 23 mars 2021

Obtenir le journal › Revue des Comptoirs journal du 23 mars 2021

Obtenir le journal › vraie feuille de route ou leurre ? Le Gouvernement a communiqué cette semaine sur un plan de réouverture en trois phases. Si on peut saluer le fait …
un an à l’épreuve de la Covid
Le 14 mars dernier, soit un an après la première annonce de la fermeture des cafés, bars, restaurants et discothèques, …
première victoire contre axa
La cour d’appel d’Aix-en-Provence (13) a condamné Axa à indemniser un restaurateur marseillais pour ses pertes d’exploitation dues à la …
la place des femmes en gastronomie
39 femmes sont étoilées Michelin en France en 2021, sur 638 restaurants étoilés (contre 33 en 2020 et 27 en …
un plan en trois phases pour la réouverture
Après une première réunion de travail au début mars entre les représentants du secteur CHRD et des membres du Gouvernement, …
Toujours en kiosque
Picsou Magazine 10 mars 2021

Obtenir le journal › Réforme 18 mars 2021

Obtenir le journal ›
La Revue Nationale de la Chasse 17 mars 2021

Obtenir le journal › L’Éclaireur Gamaches 18 mars 2021

Obtenir le journal › Conformément à la loi Informatique et Libertés du 06 janvier 1978, vous bénéficiez d’un droit d’accès, de rectification et de suppresion des données personnelles qui vous concernent. Vous pouvez exercer ces droits auprès de ePresse en écrivant à l’adresse suivante : TOUTABO 59 rue spontini 75116 Paris, à laquelle vous pouvez également exercer un droit d’opposition à recevoir des offres commerciales. Pour vous désinscrire de cette revue de presse, rendez-vous sur cette page.
TOUTABO, SA au capital de 488 213.90 euros, RCS Paris 480 467 000, 59 rue Spontini 75116 Paris
Les Unes de l’Actu du 22/03/2021
La Nouvelle République des Pyrénées journal du 22 mars 2021

Obtenir le journal › Le poids de la culture On se serait cru un an en arrière, à l’heure du premier confinement, quand une longue file s’était formée devant …
Tilhouse : « Touche pas à ma forêt » rassemble
Le collectif « Touche pas à ma Forêt » avait choisi la journée internationale de la Forêt, hier dimanche 21 …
Article
Bagnères > La disparue de Beaudéan retrouvée morte. Le corps sans vie de Sylviane Delavault, qui avait disparu de son …
Le « banquet » de Mouysset
La résidence artistique organisée par l’association Médianes (avec le soutien de la DRAC, du GIP, de la CAF, de l’Education …
Cérémonie d’hommage au Maréchal Foch
Samedi matin, une cérémonie d’hommage au Maréchal Foch a eu lieu devant la statue équestre du grand homme en présence …
Midi Libre journal du 22 mars 2021

Obtenir le journal › Mondial à contresens Argent sale, morale déliquescente. Le cocktail de la honte entourant l’attribution de la Coupe du monde au Qatar en 2022 …
Double casquette
Mercredi dernier, Emmanuelle Gazel, maire de Millau et présidente de la communauté de communes Millau Grands causses, et Valérie Michel-Moreaux, …
Le centre de sauvegarde au chevet de la faune sauvage
La structure entend poursuivre ses actions sur le castor.Le Centre régional de sauvegarde de la faune sauvage caussenard (CRSFSC) tenait …
««Un travail à faire pour expliquer que le statut changeUn travail à faire pour expliquer que le statut change»»
Le CFA Nicolas-Albano a enregistré 12% d’inscriptions en plus lors de la rentrée 2020. L’illustration que ce mode de formation …
Les écoles vont devenir de véritables productrices d’énergies solaires
Parce qu’elle se dit«soucieuse de participer à la transition et assurer l’équilibre énergétique du territoire», la Ville de Millau a …
L’Est éclair journal du 22 mars 2021

Obtenir le journal › L’Alsace journal du 22 mars 2021

Obtenir le journal › l’Indépendant journal du 22 mars 2021

Obtenir le journal › Pollution et manque d’eau: quel outil pour préserver la vallée de l’Agly? Le fleuve Agly au niveau de Rivesaltes.Comme un séisme. La pollution aux pesticides qui a privé les habitants de Tautavel …
Pratiques agricoles : les actions déjà engagées
Non contente d’être favorable à l’évolution des pratiques, la Chambre d’agriculture en est déjà actrice.Trois forages de nouveau conformes La …
Aux Aigles de la Cité Jean Mazières Au Super U de Trèbes Christian Medves et Hervé Sosna Au centre hospitalier Arnaud Beltrame
Le vendredi 23mars 2018, peu après 10h, Jean Mazières est le premier à croiser la route du terroriste, à Carcassonne. …
« Une enquête a été ouverte pour meurtre par conjoint et incendie volontaire »
Tout a débuté dans la nuit de ce samedi à dimanche, un peu après minuit, quand des riverains ont donné …
Une voisine de l’immeuble témoigne:«D’elle, je ne connaissais que les cris»
Les yeux rivés sur son balcon noirci par les flammes, la jeune femme semble peiner à comprendre ce qu’il vient …
Sud Ouest journal du 22 mars 2021

Obtenir le journal › Peuvent-ils vraimentgagner? …
Le terminal à conteneurs fait peau neuve
…
Hurmic ne parlera pas de la présidentielle
Attendue à Bordeaux ce lundi pour la réunion de l’association internationale des maires francophones, Anne Hidalgo rencontrera aussi les cadres …
«Jene peux pas rester en de hors du chemin »
Nous vivons une période totalement inédite.Ce qui a changé, c’estl’état de notre sociétéet lesperspectives politiques.Depuis 2017, nombrede femmes et d’hommesde …
«Idées en commun», le premier étage de sa fusée vers 2022
Anne Hidalgo n’est pas encore candidate à la présidentielle. Mais l’interview qu’elle nous a accordée le montre sans ambiguïté: 2022 …
Centre Presse journal du 22 mars 2021

Obtenir le journal › L’Ardennais journal du 22 mars 2021

Obtenir le journal ›
The Guardian journal du 22 mars 2021

Obtenir le journal › La Voix du Nord journal du 22 mars 2021

Obtenir le journal › Ouest-France journal du 22 mars 2021

Obtenir le journal › Abus dans l’Église : l’ampleur du mal Quelque 10 000 personnes victimes d’abus sexuel par des clercs, en France, depuis 1950. Telle est l’estimation de la Commission indépendante sur …
Covid-19 – Le mal-être des enfants submerge l’hôpital
Page …
Le moral des habitants de l’Ouest reste plutôt bon
Notre baromètre Ouest-France. À l’occasion des prochaines élections, trois mille personnes ont été interrogées en Bretagne, Normandie et Pays de …
Israël – Le Premier ministre Netanyahou, favori des élections
…
En deux ans, le 4e référendum pro ou anti Bibi
Lassés, 6,5 millions d’Israéliens sont appelés, demain, à élire les membres de leur Parlement, la Knesset, qui désigne le Premier ministre. …
Libération journal du 22 mars 2021

Obtenir le journal › Idées Le Covid ou la «vie en temps réel» Interview du philosophe Frédéric Worms, pages …
les luttes entrent en scène
Parti du milieu culturel, le mouvement s’est élargi à des revendications concernant tous les précaires au fur et à mesure qu’il s’étendait, jusqu’à …
Télétravail Pandémie, Canaries, paradis
Reportage dans les îles espagnoles, pages …
Vallaud-Belkacem Pourquoi elle défie Wauquiez aux régionales
Rencontre avec la candidate PS à la région auvergne-Rhône-Alpes, pages …
Mini-ZAD
C’est le scénario que redoute l’exécutif, une agrégation des colères qui mettrait définitivement à l’arrêt un pays déjà fragilisé par …
La Nouvelle République journal du 22 mars 2021

Obtenir le journal › The Independent journal du 22 mars 2021

Obtenir le journal ›
Al Bayane journal du 22 mars 2021

Obtenir le journal › Le Républicain Lorrain journal du 22 mars 2021

Obtenir le journal › Le Parisien journal du 22 mars 2021

Obtenir le journal › Le flex office monte en puissance « Le télétravail imposé a obligé les entreprises à réfléchir à leur organisation. La crise du Covid a accéléré la transformation, …
Chouette, je vais devenir maman !
@Berlepetit Attendre un « heureux événement » en pleine pandémie, elles l’ont choisi et elles assument. Alors que la France a …
Et si un baby-boom suivait le baby-krach ?
N’en déplaise aux romantiques, les joies de la vie confinée n’ont pas entraîné un rebond des naissances. Les longues heures …
« C’est pertinent s’il est jumelé avec du télétravail »
Autrice du livre « Les entreprises à l’heure du flex office » (Ed. L’Harmattan), publié en septembre, Delphine Minchella estime que ce …
Cas contacts et positifs se multiplient au gouvernement
Avalanche de cas positifs au Covid chez les ministres ! Après Elisabeth Borne en fin de semaine dernière, c’est Roselyne Bachelot …
La Marseillaise journal du 22 mars 2021

Obtenir le journal › Titre sur 2 lignes Journée mondiale de l’eau Comme en 2012, les associations se mobilisent pour un forum alternatif mondial de l’eau à Marseille. …
Article
OGC Nice / OM Se relever après la raclée Les Olympiens n’ont pas pesé lourd face aux Niçois. Une lourde …
Article
27926 – 0322 – 1,40 E bouches-du-rhône et var 1,40 E http://www.lamarseillaise.fr Lundi 22 mars 2021 – …
Titre sur 3 lignes
Var Profitez de visites en libre accès et découvrez le patrimoine de la Métropole Toulon Provence Méditerranée depuis votre smartphone …
Article
Photo FFPJP Pétanque Michel Le Bot élu président de la fédération Le Haut-Garonnais a pris la tête de la Fédération …
La Libre Belgique journal du 22 mars 2021

Obtenir le journal › Le Dauphiné Libéré journal du 22 mars 2021

Obtenir le journal ›
La Presse de la Manche journal du 22 mars 2021

Obtenir le journal › The New York Times International Edition journal du 22 mars 2021

Obtenir le journal ›
Le Petit Quotidien journal du 22 mars 2021

Obtenir le journal › La République des Pyrénées journal du 22 mars 2021

Obtenir le journal › Le Maine Libre journal du 22 mars 2021

Obtenir le journal › Dans les trains, la sécurité renforcée depuis l’automne En Sarthe, des gendarmes réservistes patrouillent dans les TER afin de lutter contre la délinquance. Page …
Le tramway accueillera davantage de monde
Le Mans. Afin notamment d’améliorer l’accueil des usagers, Le Mans métropole souhaite agrandir ses rames et aménager ses quais. Les …
Remportez une box « 4 jours de break »
Vous avez envie de faire une pause et de partir quelques jours ? Le Maine Libre vous propose de réaliser ce …
Usagers surpris, rassurés ou circonspects
Que font des gendarmes en tenue dans un TER loin d’être bondé ? Ou en gare de Château-du-Loir en plein après-midi ? Certains …
Retour du soleil ce lundi
Après un dimanche un peu gris, le soleil sera de retour dans le ciel sarthois en ce lundi. Côté températures, …
Courrier Picard journal du 22 mars 2021

Obtenir le journal › Le Bien Public journal du 22 mars 2021

Obtenir le journal › L’Opinion journal du 22 mars 2021

Obtenir le journal › Air France-KLM se porte mieux en Bourse que dans le ciel Ça ne plane toujours pas pour les compagnies aériennes. En présentant le mois dernier ses terribles comptes annuels 2020, Air …
De quoi l’attestation dérogatoire est-elle le nom?
Un formulaire, deux pages, 12 motifs de sortie de chez soi, des astérisques renvoyant à des « items » citant des décrets …
Troisième confinement: pourquoi faire simple…
La troisième voie est un cul-de-sac. Sous les critiques et les moqueries, l’exécutif a abandonné partiellement samedi l’attestation de déplacement …
Magie de Bercy, le nouveau confinement ne coûtera rien!
Chaque confinement produit un effet de sidération devant les restrictions de libertés, les fermetures imposées à de nombreux acteurs économiques …
Contre la Covid-19, l’exécutif se bat avec le son mais sans l’image
Là-bas, des personnes patientent devant une cathédrale transformée en centre de vaccination. Ailleurs, elles se font piquer dans un ancien …
La Dépêche du Midi journal du 22 mars 2021

Obtenir le journal › Couper le robinet On le dit « gaz hilarant ». Mais ce qui est vraiment drôle, c’est qu’on peut l’utiliser pour des usages …
Une loi contre le gaz hilarant : fini de rire
Le gaz hilarant ne fait plus rire. Le protoxyde d’azote, ce produit utilisé dans le milieu médical pour soulager les …
« Protéger les jeunes d’un danger de santé publique »
Pour la première fois une loi va être votée pour encadrer et alerter sur l’utilisation, chez les jeunes, du protoxyde …
Jean-Marie, 27 ans, Toulouse.
Jean-Marie, Lucien, Julia… Ils ont tous essayé le protoxyde d’azote dans des ballons de baudruche juste « pour voir ce …
Pourquoi le gouvernement se refuse à parler de confinement
Le ministre de la Santé se refuse toujours à utiliser le mot « confinement » concernant les 16 départements où …
Le Télégramme journal du 22 mars 2021

Obtenir le journal › Le Progrès journal du 22 mars 2021

Obtenir le journal › Le Petit Bleu d’Agen journal du 22 mars 2021

Obtenir le journal › rugby l L’Agenais a inscrit l’essai libérateur samedi soir permettant à la France de s’imposer (32-30) l Il a été désigné …
Fréquentation du centre-ville d’Agen en 2020 (nombre de passages mensuels)
Cet histogramme permet de bien visualiser l’effet du premier confinement, avec un impact relativement mesuré en mars et mai 2020, …
La fréquentation du centre-ville plus forte que la crise sanitaire en 2020
Les villes moyennes – celles où vivent entre 20 000 et 100 000 habitants – ont mieux résisté à la …
Jean Dionis : Pour les régionales, « il n’y a pas que l’envie qui est déterminante »
Certains attendaient avec impatience cette émission politique sur l’antenne de France 3 Aquitaine « Dimanche en politique » avec Jean …
Chien maltraité à Agen : elle raconte son sauvetage
Une semaine après ce triste évènement, Léa ne regrette en rien son geste. « Non au contraire », lâche-t-elle spontanément …
France-antilles Martinique journal du 22 mars 2021

Obtenir le journal › Nord Littoral journal du 22 mars 2021

Obtenir le journal › L’Equipe journal du 22 mars 2021

Obtenir le journal › LE LION C’EST PARIS DÉCINES (RHÔNE) – Et à la fin, il est bien possible que ce soit encore le PSG qui gagne, parce …
Mbappé, le pur-cent
DéCINES – Dès ses premières prises de balle, il était annoncé que cette soirée ressemblerait davantage à ce que Kylian …
Paris, milieu royal
DéCINES (Rhône) – À l’aller, le 13 décembre, c’est au milieu que le PSG avait perdu le match (0-1). Face …
Pochettino : « C’est très fort, ce qu’ils ont fait »
L’entraîneur argentin du PSG, Mauricio Pochettino, était très satisfait de la domination totale de ses hommes face à l’OL.« Qu’avez-vous …
Aouar forfait, Claude-Maurice et Laurienté appelés
Le Niçois Alexis Claude-Maurice a été appelé hier par Sylvain Ripoll en équipe de France Espoirs pour remplacer le Lyonnais …
Corriere Della Sera journal du 22 mars 2021

Obtenir le journal › L’actu journal du 22 mars 2021

Obtenir le journal ›
La Provence journal du 22 mars 2021

Obtenir le journal › Nord éclair journal du 22 mars 2021

Obtenir le journal › Le Courrier de L’Ouest journal du 22 mars 2021

Obtenir le journal › Un joyau à ouvrir aux Angevins BEAUCOUZÉ. Le château de Mollières qui date de 1501 devrait être la prochaine acquisition de Paritosh Gupta. Cet Angevin d’origine indienne …
L’Ablette s’en tire plutôt bien
…
Des ateliers d’écriture au lycée pour le Printemps des poètes
pAGE …
« Une écologie de solutions »
ENTRETIEN Presse Océan : les élections régionales dans la région s’annoncent rudes… Yannick Jadot : « Cela va être l’occasion d’un débat très riche sur …
Le Sidaction 2021 aura lieu du 26 au 28 mars
Le Sidaction 2021 en région aura lieu les 26, 27 et 28 mars. En raison de la crise sanitaire, les animations …
L’Union journal du 22 mars 2021

Obtenir le journal › Les Dernières Nouvelles d’Alsace journal du 22 mars 2021

Obtenir le journal ›
L’Est Républicain journal du 22 mars 2021

Obtenir le journal › Libération Champagne journal du 22 mars 2021

Obtenir le journal › Ouest-France édition France journal du 22 mars 2021

Obtenir le journal › Le moral des habitants de l’Ouest reste plutôt bon Notre baromètre Ouest-France. À l’occasion des prochaines élections, trois mille personnes ont été interrogées en Bretagne, Normandie et Pays de …
Covid-19 – Le mal-être des enfants submerge l’hôpital
Page …
Israël – Le Premier ministre Netanyahou, favori des élections
…
Abus dans l’Église : l’ampleur du mal
Quelque 10 000 personnes victimes d’abus sexuel par des clercs, en France, depuis 1950. Telle est l’estimation de la Commission indépendante sur …
Israël : la foi absolue des partisans de Netanyahou
Beït Shéan. De notre correspondant Quand on lui demande où il habite, Prospère Dadia a sa réponse toute prête : Je dis …
Centre Presse Aveyron journal du 22 mars 2021

Obtenir le journal › 2025 personnes ont déjà signé la pétition lancée il y a 6 jours sur internet par le Collectif de réflexion sur …
travers le département…
Feu de cuisine à Decazeville. Les sapeurs-pompiers du Bassin ont par principe et par précaution déployé les grands moyens, hier, …
Social.Fin de la grève des postiers dans le Bassin decazevillois
La direction de La Poste a fait savoir hier matin que la signature d’un protocole d’accord avec la CGT, dépositaire …
Sécurité Routière.Les contrôles de la semaine sur les routes de l’Aveyron
Afin de renforcer la sécurité sur les routes du département, des contrôles opérés par la police nationale et les militaires …
Social.2000à 3000 personnes pour défendre Sam et le Bassin
Comme il y a un mois, ils ont été nombreux à se mobiliser, hier, à Viviez, en soutien aux salariés …
La Croix journal du 22 mars 2021

Obtenir le journal › La guerre des doses La tourmente coronavirale souffle fort de nouveau sur l’Europe. Partout, on confine et reconfine, d’une main plus légère que lors …
Intersectionnalité
En 1989, l’afro-féministe Kimberlé Williams Crenshaw développe ce concept pour croiser les discriminations de classe, de race ou de genre : …
Race
Les études dites « postcoloniales » sont issues des Cultural Studies des années 1970 aux États-Unis. Elles interrogent l’identité des Afro-Américains dont …
Genre
Les études de genre analysent les rôles sociaux stéréotypés par lesquels on définit la féminité et la masculinité et leurs …
Islamophobie
Le néologisme « islamophobie » apparaît dans le débat public au début des années 2000. Il oppose ceux qui l’utilisent pour dénoncer les …
Les Echos journal du 22 mars 2021

Obtenir le journal › La France proche du zéro charbon éNERGIE : La centrale à charbon d’EDF du Havre a été discrètement débranchée mercredi dernier, avec quelques jours d’avance sur le …
Covid-19 : dans les secrets de l’immunité
Une série d’études françaises est venue éclairer la réponse des différentes composantes du système immunitaire à l’épidémie. Il faut noter …
Suez tente une ouverture dans sa bataille avec Veolia
Environnement : Le bras de fer continue. Suez a fait une nouvelle proposition à Veolia, en lui demandant d’accepter d’augmenter …
Les tensions sur les taux fragilisent les Bourses mondiales
Dette : La remontée des taux finira-t-elle par avoir raison de la hausse des Bourses mondiales ? Les investisseurs s’inquiètent d’une …
Hidalgo réclame d’ouvrir la va ccination à « tout le monde »
Invitée dimanche du Grand Rendez-Vous Europe 1 – C News « Les Echos », la maire de Paris, Anne Hidalgo, a exhorté …
La Dernière Heure/Les Sports journal du 22 mars 2021

Obtenir le journal › Charente Libre journal du 22 mars 2021

Obtenir le journal › L’Humanité journal du 22 mars 2021

Obtenir le journal › Bonne nouvelle En Tunisie, Rania Amdouni, militante féministe et LGBTQ+, a été libérée le 17 mars, à l’issue de son procès en appel …
L’actualité sur l’Humanité.fr
Reportage L’Équateur, troisième exportateur mondial de fleurs, mais à quel prix… Sur les flancs du volcan Cayambe, dans le nord …
Léna Lazare
Comme un air de déjà-vu, sauf que cette fois, il y a aussi de « la rage », prévient Léna Lazare, militante …
Bonne nouvelle
La Haute Cour du Kenya a confirmé l’interdiction des mutilations génitales féminine. La pratique avait été rendue illégale en 2011 …
Elyaas Ehsas
Il y a six ans, Elyaas Ehsas, reporter de guerre afghan, a été menacé sur son téléphone par des talibans …
Le Journal de Saône et Loire journal du 22 mars 2021

Obtenir le journal › L’Éclair des Pyrénées journal du 22 mars 2021

Obtenir le journal ›
Dordogne Libre journal du 22 mars 2021

Obtenir le journal › Le Figaro journal du 22 mars 2021

Obtenir le journal › Presse Océan journal du 22 mars 2021

Obtenir le journal › Un espoir pour traiter les maladies du cœur Applications. Tuan Huy Nguyen, fondateur de la société « GoLiver Therapeutics », société installée au sein du CRTI (Centre de recherche en …
Ces pépites locales qui échappent à la crise
La thérapie cellulaire aujourd’hui, c’est un peu comme l’ARN messager (NDLR : technologie utilisée pour les premiers vaccins anti-Covid mis au …
À Nantes, la société Affilogic relocalise sa production
En novembre dernier, la société de biothérapie Affilogic, basée à Nantes, a décroché le « gros lot », et une aide de …
Aéroport : « À quel jeu joue l’État ? »
En janvier 2018, malgré le soutien des élus locaux et l’expression massive des citoyens favorables au projet, le gouvernement renonçait au …
La révolution fraternelle du Secours catholique
Presse Océan : comment le Secours catholique fait-il face à la crise sanitaire ? Hervé Bonamy : « Nous avons une légère baisse du nombre …
Aisne Nouvelle journal du 22 mars 2021

Obtenir le journal › Corse Matin journal du 22 mars 2021

Obtenir le journal ›
Mon Quotidien journal du 22 mars 2021

Obtenir le journal › Femme Actuelle journal du 22 mars 2021

Obtenir le journal › Maxi journal du 22 mars 2021

Obtenir le journal › Le mot de la rédac’ Vous le savez, Maxi a toujours fait la part belle aux animaux. Cette semaine, nous nous attardons sur leur bien-être, …
Trois voix qui vont vous enchanter !
LANA DEL REY C’est toujours un plaisir de retrouver la chanteuse américaine Lana Del Rey, sa voix envoûtante et ses …
TÉLÉCONSULTATION MÉDICALE : COMMENT ÇA MARCHE ?
Depuis l’épidémie de coronavirus, la téléconsultation médicale connaît un boom. Accès aux soins facilités, gain de temps, consultation à toute …
DES PÉPITES À VOIR EN FAMILLE
BEAU FRISSON DE NOSTALGIE Bienvenue dans les années 1970-1980 ! Dans une île paradisiaque, M. Roarke et son assistant …
BULLES DE STARS
DANS L’OMBRE DE GAINSBOURG En 2010, le dessinateur Mathieu Sapin accompagne son ami Joann Sfar sur le tournage de …
Télé 7 Jours journal du 22 mars 2021

Obtenir le journal › Cover page DEUX MOIS APRÈS LE REMPLACEMENT DE JEAN-PIERRE PERNAUT AU 13 H, PARI GAGNÉ POUR TF1 Marie-Sophie Lacarrau LE GOÛT DES …
V’là le printemps !
Les saisons passent… et nos journées se ressemblent terriblement ! Mais le printemps, c’est le printemps. Certains d’entre vous vont se …
Sommaire
L’ACTU 4 7 jours 7nuits Les César 6 7 jours 7 buzz 8 Coulisses M6 : à fond sur le …
César 2021 Le “cru” du cœur !
Des revendications pour sauver la culture, un palmarès riche en diversité, tant au niveau des œuvres primées que des récompensés, …
Glisse éternelle
Au XVIe siècle, le peintre Pieter Brueghel l’Ancien fixait déjà, avec minutie, ce genre de scène sur ses toiles. En …
Télé Poche journal du 22 mars 2021

Obtenir le journal › Une enquête au final inouï …
Peau d’âne
Sa gouaille, c’est sa marque de fabrique à Corinne Masiero, alias Capitaine Marleau. Ce vendredi 12 mars, c’est sur Canal+ …
LA SAGA HAMILTON
» Retour sur le parcours de Lewis Hamilton. Mais qu’est-ce qui rend le Britannique si fort ? Le septuple champion …
Trop, c’est trop !
Je suis un téléspectateur fidèle de l’émission Tout le sport diffusée sur France 3 et je suis excédé par les …
Inégalités culturelles
Pourquoi des émissions telles que Symphonissime (dans un théâtre), Taratata (dans un studio) se déroulent en public et pas le …
Télé Star journal du 22 mars 2021

Obtenir le journal › Corinne MasieroUne mise à nu polémique …
Coup de chapka !
Qu’est-ce que l’on en a entendu parler de cette cérémonie des César ! La palme du coup d’éclat est attribuée …
Affaires émues
Voilà qui va clouer le bec de ceux qui le disent «pédant» voire hautain. Moi, je dis chapeau et bravo …
Olivier Marchal
Le retour d’Olivier Marchal en flic bourru pour la 3e saison des Rivières pourpres sur France 2 est une très …
Cela suffit de voir, et revoir, Die Hard, Indiana Jones, etc…
Nous serions reconnaissants aux chaînes télé de renouveler leur stock. Cela suffit de voir, et revoir, Die Hard, …
Télécâble Sat Hebdo journal du 22 mars 2021

Obtenir le journal › Pour le meilleur… Alors que certains se demandent encore si la dernière cérémonie des César restera comme la pire de son histoire, franchissons …
“À musée vous, à musée moi” : bientôt la suite
La série courte et loufoque qui revisite de grands tableaux sur Arte proposera à la rentrée prochaine une saison 3. …
De Tchernobyl à “Chernobyl”
Alors que, le 26 avril prochain marquera les trente-cinq ans de la catastrophe nucléaire de Tchernobyl, M6 a annoncé qu’elle …
Il était une fois… Élisabeth II
National Geographic diffusera, le 18 avril, Elizabeth II, destin royal, un documentaire inédit sur le règne de près de 70 …
Marie Portolano ouvre le mercato
Après sept ans de bons et loyaux services, la journaliste a quitté Canal+ où elle présentait le Canal Sports Club, …
Edition Multimédi@ journal du 22 mars 2021

Obtenir le journal › Sanglier et ses chasses journal du 22 mars 2021

Obtenir le journal › Midi Olympique Rouge journal du 22 mars 2021

Obtenir le journal › GAGNER LE TOURNOI, MODE D’EMPLOI Les essais de Charles Ollivon puis de Brice Dulin, après 3 minutes d’arrêts de jeu, ont permis au XV de …
UN MENTAL DE CHAMPIONS
Passé le faste des années folles, époque bénie des victoires dans le Tournoi et des finales de Coupe du monde, …
« C’est la victoire des joueurs »
Avez-vous pris du plaisir à voir le XV de France battre les Gallois dans les toutes dernières secondes samedi soir …
« Ô CAPITAINE ! MON CAPITAINE ! »
À quoi reconnaît-on un grand capitaine? D’abord, à sa capacité à se remettre en cause.ÀTwickenham, face à l’Angleterre, Charles Ollivon …
J’AI PEUR POUR WILLEMSE
Je pensais à un truc, samedi soir: vous imaginez l’explosion, la déflagration, le bruit de dingue, si ce stade avait …
Télé Loisirs journal du 22 mars 2021

Obtenir le journal › La République de Seine et Marne journal du 22 mars 2021

Obtenir le journal › La Lettre CHR-CHD journal du 22 mars 2021

Obtenir le journal › Un plan en trois phases pour la réouverture Après une première réunion de travail au début mars entre les représentants du secteur CHRD et des membres du Gouvernement, …
Organisations du CHR et ministère envisagent les conditions de la reprise
Le plan de réouverture sera accompagné d’un maintien des aides telles que le chômage partiel, dont la prise en charge …
B&B Hotels lève 180 millions d’euros
En vue de poursuivre son développement et malgré la crise sanitaire, le groupe B&B Hotels a effectué une levée de …
Positionnement renforcé pour The Fork
La filiale de TripAdvisor, qui a racheté l’entreprise française en 2014, a pu compter sur le rachat de Bookatable entre …
Hyatt inaugure son 1 000e hôtel et poursuit son expansion
Le Alila Napa Valley en Californie (États-Unis), fraîchement inauguré, est le 1 000e hôtel Hyatt à travers le monde. Ce …
Toujours en kiosque
Les Informations Dieppoises 19 mars 2021

Obtenir le journal › Le Progrès Saint-Affricain 18 mars 2021

Obtenir le journal ›
Célébrité Magazine 17 mars 2021

Obtenir le journal › Entreprendre 10 mars 2021

Obtenir le journal › Conformément à la loi Informatique et Libertés du 06 janvier 1978, vous bénéficiez d’un droit d’accès, de rectification et de suppresion des données personnelles qui vous concernent. Vous pouvez exercer ces droits auprès de ePresse en écrivant à l’adresse suivante : TOUTABO 59 rue spontini 75116 Paris, à laquelle vous pouvez également exercer un droit d’opposition à recevoir des offres commerciales. Pour vous désinscrire de cette revue de presse, rendez-vous sur cette page.
TOUTABO, SA au capital de 488 213.90 euros, RCS Paris 480 467 000, 59 rue Spontini 75116 Paris
Les Unes de l’Actu du 21/03/2021
Centre Presse Aveyron journal du 21 mars 2021

Obtenir le journal › Lydie et Julien ont relevé le gant de la tradition alliée à la modernité Créé par Christian et Chantal Caniac, en 1989, l’Atelier du gantier, à Millau, poursuit son savoir-faire grâce à Lydie Peron …
Natacha Lemaire, «coureuse» des bois La «cultiv’actrice» cherche un coup de pouce
Louna et Alma, les deux chiennes, jappent d’impatience. Les boucs (père et fils) ainsi que les chèvres (chacune a son …
C’est l’histoire d’un type et de la fin du monde…
Comme l’a si bien écrit, avec originalité, André Valverde, dans la préface,« c’est l’histoire d’un » … type – un …
Azmari
Les Azmari sont en Éthiopie des bardes et cela remonte aux temps de nos troubadours. Aujourd’hui, c’est un collectif belge …
Lalala Napoli
Entre tarentelle, blues, chanson, voire un soupçon de rock, les Lalala Napoli signent un folk italien imaginaire, sauvage et turbulent, …
Courrier Picard journal du 21 mars 2021

Obtenir le journal › Nord Littoral journal du 21 mars 2021

Obtenir le journal ›
L’Ardennais journal du 21 mars 2021

Obtenir le journal › Le Dauphiné Libéré journal du 21 mars 2021

Obtenir le journal ›
La Voix du Nord journal du 21 mars 2021

Obtenir le journal › Le Télégramme journal du 21 mars 2021

Obtenir le journal › Dimanche Ouest-France journal du 21 mars 2021

Obtenir le journal › Stade Rennais : victoire face à Metz En déplacement à Metz pour la 30e journée de Ligue 1, le Stade Rennais l’a emporté (3-1) grâce à des …
Affaire Magali Blandin : son mari avoue le meurtre
Elle avait disparu le 11 février. Hier, son mari a avoué en garde à vue l’avoir tuée, a annoncé le …
Le bois chasse le plastique en Finlande
Ce dimanche 21 mars, c’est la Journée internationale de la forêt. En Finlande, où les bois couvrent 70 % de la superficie …
L’Ouest à la conquête du plastique propre
Repères Quelles alternatives au plastique ? Gros consommateur d’emballages et très concerné par les risques sanitaires liés au plastique, le secteur de l’alimentation …
Chez Uzaje, on lave les emballages plutôt que de les jeter
Reportage Il faut dénicher l’entrepôt impersonnel, dans la zone industrielle de Neuilly-sur-Marne, à l’ouest de Paris. Mais le chauffeur de la …
The Independent journal du 21 mars 2021

Obtenir le journal › Nord éclair journal du 21 mars 2021

Obtenir le journal › Le Courrier de L’Ouest journal du 21 mars 2021

Obtenir le journal › Le patrimoine levier d’essor des Petites Cités de caractère Françoise Gatel, présidente des Petites Cités de caractère de France, était à Baugé hier.page …
Le nouveau projet artistique de Doris
…
Sur le ring de « Koh Lanta »
Saumurois. Originaire de Montreuil-Bellay, la championne d’arts martiaux Lucie Bertaud a fait une entrée surprise dans l’émission « Koh Lanta », diffusée …
Un Carnet d’Anjou au fond de la bouteille
Consacré aux « Patrimoines de la vigne et du vin », le troisième numéro des « Carnets d’Anjou » se déguste par petites lampées …
Collèges publics : premier ascenseur extérieur
Depuis cinq ans, la loi oblige tous les établissements recevant du public à en être équipé. Un ascenseur sera mis …
Le Journal de Saône et Loire journal du 21 mars 2021

Obtenir le journal › L’Est éclair journal du 21 mars 2021

Obtenir le journal ›
Le Journal du dimanche journal du 21 mars 2021

Obtenir le journal › La Nouvelle République Dimanche journal du 21 mars 2021

Obtenir le journal ›
Corse Matin journal du 21 mars 2021

Obtenir le journal › Corriere Della Sera journal du 21 mars 2021

Obtenir le journal › L’Equipe journal du 21 mars 2021

Obtenir le journal › NUIT Et là vous vous dites : je veux bien en reprendre pour six mois d’attestations marron pourvu que tous nos …
Bravo, mais restons lucides
C’est énorme. Bravo à l’équipe de France, pour cette force de caractère, que l’on connaissait déjà et qui leur a …
Objectif bonus offensif contre l’Écosse
La victoire sur le gong d’hier soir, obtenue avec le bonus offensif, maintient en vie les espoirs de victoire finale …
Les notes du match
Le sang-froid égaréJusque-là, il n’avait rien raté, bien au contraire : L. Williams (6) avait régné sur les airs, récupéré …
L’essai du bout du périph
Enfoncé dans sa parka sombre, il ne bouge pas. Derrière lui, Raphaël Ibañez s’est levé de son siège depuis déjà …
Sud Ouest Dimanche journal du 21 mars 2021

Obtenir le journal › La Provence journal du 21 mars 2021

Obtenir le journal › Presse Océan journal du 21 mars 2021

Obtenir le journal › Le Parti communiste célèbre son centenaire Gérard Guérin a 78 ans. Annaïck Magne-Dabin a 22 ans. Tous deux sont militants communistes. Le premier a adhéré au PCF en …
« Le PC est inscrit dans l’ADN français »
Héritage. « Cette célébration permet de rappeler notre héritage et de montrer que notre manière de penser la société est très …
Retracer l’histoire du Parti dans le département
À l’occasion du centenaire du PCF, l’historien et militant communiste rezéen Yann Vince a travaillé sur l’histoire du parti dans …
Chefs Extraordinaires aux fourneaux
Chefs Extraordinaires, c’est un média indépendant, inclusif et culinaire. Ce sont des vidéos pour gagner en autonomie grâce à la …
Marguerite a hâte de retrouver sa vie d’avant
Le calendrier lunaire et la petite loupe n’ont pas bougé. Bien à leur place sur la toile cirée de la …
Le Parisien journal du 21 mars 2021

Obtenir le journal › Comment Macron a tranché au dernier moment La mine est sombre et préoccupée quand Emmanuel Macron prend son téléphone pour parler avec Jean Castex. Depuis le salon …
Quand le gouvernement se prend les pieds dans l’attestation
Sur les réseaux sociaux, des captures d’écran des « 12 Travaux d’Astérix » ont fleuri, hier. Dans ce dessin animé, le Gaulois manque …
« On n’empêche pas les Français de sortir »
« Le quoi, pardon ? » fait ostensiblement répéter Olivier Véran lorsque nous lui parlons du confinement. Plus qu’une plaisanterie, son refus d’employer …
AstraZeneca, le mauvais plan
L’intendance suivra-t-elle ? Alors que, jeudi, le comité d’experts en pharmacovigilance de l’Agence européenne des médicaments (EMA) a jugé le vaccin …
Dehors, la vie pratiquement comme avant
Sous un cerisier en fleur du parc Martin-Luther-King, dans le XVII e arrondissement de Paris, un couple immortalise son mariage devant …
Les Dernières Nouvelles d’Alsace journal du 21 mars 2021

Obtenir le journal › Paris-Normandie Dimanche journal du 21 mars 2021

Obtenir le journal › Le Maine Libre journal du 21 mars 2021

Obtenir le journal › Dix chevreaux à l’Arche de la nature Depuis le 8 mars, cinq chèvres des fossés ont mis bat à la ferme des bois de l’Épau. Leurs prénoms, qui …
Coupe de France : le MSB éliminé en quart de finale
Les Manceaux n’ont pas tenu la distance, hier soir, face à une équipe d’Orléans intraitable au rebond. Pages …
Leur combat dépasse la survie d’une classe
Rouessé-Vassé. Habitants et élus étaient mobilisés, hier, pour lutter contre la fermeture d’une classe de leur école et rappeler l’importance …
Le prieuré s’ouvre à l’art urbain avec l’artiste italien Ravo
Repris en gestion en novembre 2020 par Lancelot Durand, il a accueilli sa toute première …
Le retour de la grisaille
Des nuages et des pluies éparses. Voilà ce qui attend les Sarthois ce dimanche. Il fait ce matin 4° à …
L’Union journal du 21 mars 2021

Obtenir le journal › Le Républicain Lorrain journal du 21 mars 2021

Obtenir le journal ›
L’Alsace journal du 21 mars 2021

Obtenir le journal › Libération Champagne journal du 21 mars 2021

Obtenir le journal › l’Indépendant journal du 21 mars 2021

Obtenir le journal › Des mesures opposées… pour un même résultat? Des deux côtés de la frontière franco-espagnole, l’épidémie de coronavirus semble être dans un dynamique très proche ces dernières semaines. …
Les chefs étoilés Michelin reçoivent leurs plaques… et rêvent de reprise
ÇMathieu d’Izarny-Gargas, en charge des partenariats pour le guide Michelin, ne pouvait trouver de mots plus justes pour la petite …
Pour entrer ou sortir de Catalogne, la Generalitat conseille – mais n’impose pas – de présenter un certificat d’autoresponsabilité de déplacement. Comme pour l’attestation française, il faut indiquer sur le document un motif impérieux qui justifie d’entrer ou sortir du territoire (assistance à personne dépendante, retour au domicile, obligation professionnelle…) En cas de voyage en voiture ou en bus vers la Catalogne, aucun test PCR n’est requis. À l’inverse, pour rentrer en France les voyageurs de plus de 11 ans doivent présenter un résultat de test PCR négatif réalisé 72heures avant le départ. Cette règle ne comporte que trois exceptions. Il n’est pas obligatoire de fournir un test PCR négatif dans le cadre: d’un déplacement professionnel dont l’urgence ou la fréquence est incompatible avec la réalisation d’un tel test; déplacement des professionnels du transport routier dans l’exercice de leur activité; déplacement d’une durée inférieure à 24heures dans un périmètre défini par un rayon de 30 kilomètres autour du lieu de résidence. Pour ce dernier point, la préfecture des Pyrénées-Orientales précise que les résidents du sud du département et des hauts cantons sont donc concernés par cette «dérogation», mais pas ceux du nord des P.-O. Concernant les restrictions sanitaires en Catalogne, un couvre-feu est en place de 22heures à 6heures du matin. En cas de violation de cette règle, des amendes sont prévues allant de 300 à 6000euros en cas de récidive ou d’outrage à agent. Les bars et restaurants sont ouverts de 7h30 à 17h00. Ces établissements peuvent utiliser 30% de leur capacité à l’intérieur et 100% en terrasse mais avec un espace de 2 mètres entre les tables. Le soir, le service est uniquement à emporter ou en livraison. Les lieux culturels peuvent recevoir du public mais avec une jauge baissée à 50% de la capacité d’accueil. Enfin, le ticket de cinéma ou théâtre sert de «dérogation» pour rentrer chez soi jusqu’à 23heures.D.S.
Pour rentrer en France il est impératif de présenter un test PCF négatif de moins de 72 …
Depuis la Covid, «on n’a plus que les camionneurs»
La ville frontière est devenue ville fantôme. La Jonquera, cette commune catalane frontalière connue pour ses cigarettes, produits alimentaires, prostitution …
Une économie au ralenti «depuis que l’on n’a plus vu un Français»
«Ici, on n’a pas les mêmes aides qu’en France»À Figueres, les rues commerçantes étaient bien vides ce samedi en fin …
Midi Libre journal du 21 mars 2021

Obtenir le journal › Le point sur la situation épidémique L’Agence régionale de santé a communiqué les derniers chiffres concernant la situation épidémique. 17 hospitalisations sont en cours en Lozère, …
Une pétition après l’abattage d’un bois classé à La Devèze
Les riverains dénoncent la destruction d’un poumon vert.Un collectif de riverains du bois classé au château de La Devèze, qui …
On s’interroge
Certes, le projet semble dans les clous. Les permis de construire sont ok. L’État, via la DDTM (la Direction départementale …
“La barque acide” en répétition à la Verrerie
Du 29mars au 7avril, dans La Verrerie, à Alès, la compagnie La barque acide est en résidence pour répéter son …
Environ 200 personnes contre la loi Sécurité globale
Les manifestants sont passés par l’avenue du Général Perrier.Les personnes passées à côté de la Maison Carrée samedi après-midi ont …
Le Petit Bleu d’Agen journal du 21 mars 2021

Obtenir le journal › Histoire l Le 19 mars 1971, Pierre Esquirol prononçait son premier discours de maire. l Il promettait toute son ardeur pour …
Soixante minutes qui font plaisir mais encore loin d’un retour à la vie normale
Il est 18 heures passé de quelques minutes et le parking de Passeligne est presque plein au trois-quart. Même si …
Feu dans un appartement : la nonagénaire n’a pas survécu
Un incendie s’est déclaré, samedi 20 mars, aux environs de 8 heures dans un appartement situé dans un immeuble. Un …
Flashés à 195 et 200 km/h sur l’autoroute A62
La bêtise humaine n’a pas de limite apparemment pour certains irresponsables sévissant sur les routes de l’hexagone. En tout cas, …
Article
Boé > Un homme placé en garde à vue pour conduite en état d’ivresse. Le conducteur âgé de 48 ans …
Le Progrès journal du 21 mars 2021

Obtenir le journal › Le Bien Public journal du 21 mars 2021

Obtenir le journal › La Dépêche du Midi journal du 21 mars 2021

Obtenir le journal › Que faire en cas de collision ? En cas d’accident de la route impliquant une collision avec un animal, il y a certains réflexes à adopter, comme …
« Tout le monde est un peu impuissant »
Avez-vous constaté ces derniers mois une augmentation des accidents de la route liés à des collisions avec des animaux sauvages …
Une étude du tronçon sur 20 km, au préalable
Entre Durbans et Cambes, sur le bas-côté de la chaussée, les agents du service voirie du conseil départemental du Lot …
Le réveil soudain d’un volcan éteint depuis des siècles
La lave n’avait pas coulé dans le secteur depuis le XIII e siècle : une petite éruption volcanique se poursuivait …
Alerte au tsunami au Japon
Un séisme sous-marin de magnitude 7,2 s’est produit hier tout près de la côte nord-est du Japon, selon l’Agence météorologique …
L’Est Républicain journal du 21 mars 2021

Obtenir le journal › La Presse de la Manche Dimanche journal du 21 mars 2021

Obtenir le journal ›
The Observer journal du 21 mars 2021

Obtenir le journal › journal du 21 mars 2021

Obtenir le journal › Toujours en kiosque
Science et Vie Découvertes 10 mars 2021

Obtenir le journal › La Presse D’Armor 17 mars 2021

Obtenir le journal ›
Le Pays Malouin 18 mars 2021

Obtenir le journal › Fluide Glacial 08 mars 2021

Obtenir le journal › Conformément à la loi Informatique et Libertés du 06 janvier 1978, vous bénéficiez d’un droit d’accès, de rectification et de suppresion des données personnelles qui vous concernent. Vous pouvez exercer ces droits auprès de ePresse en écrivant à l’adresse suivante : TOUTABO 59 rue spontini 75116 Paris, à laquelle vous pouvez également exercer un droit d’opposition à recevoir des offres commerciales. Pour vous désinscrire de cette revue de presse, rendez-vous sur cette page.
TOUTABO, SA au capital de 488 213.90 euros, RCS Paris 480 467 000, 59 rue Spontini 75116 Paris
Les Unes de l’Actu du 20/03/2021
Aisne Nouvelle journal du 20 mars 2021

Obtenir le journal › Le Figaro journal du 20 mars 2021

Obtenir le journal ›
Courrier Picard journal du 20 mars 2021

Obtenir le journal › L’Est éclair journal du 20 mars 2021

Obtenir le journal ›
Le Républicain Lorrain journal du 20 mars 2021

Obtenir le journal › Nord éclair journal du 20 mars 2021

Obtenir le journal ›
Le Journal de Saône et Loire journal du 20 mars 2021

Obtenir le journal › La Provence journal du 20 mars 2021

Obtenir le journal ›
La République des Pyrénées journal du 20 mars 2021

Obtenir le journal › Centre Presse journal du 20 mars 2021

Obtenir le journal ›
La Presse de la Manche journal du 20 mars 2021

Obtenir le journal › Le Télégramme journal du 20 mars 2021

Obtenir le journal › Le Petit Bleu d’Agen journal du 20 mars 2021

Obtenir le journal › Covid-19 l Ce vendredi, les TGV en partance de Paris (notre photo) ont connu une affluence plus importante que d’ordinaire. l …
L’heure de plus, pour le couvre-feu, qui soulage les Agenais
Le couperet n’est pas tombé en Lot-et-Garonne. Jeudi soir, le Premier ministre Jean Castex annonçait un couvre-feu retardé à 19 …
Domitys vaccine ses résidents « à domicile »
À l’initiative nationale du groupe Domitys, en étroite collaboration avec le conseil départemental (CD 47) et l’Agence régionale de santé …
Article
Dépistage cancer colorectal > à la clinique Esquirol-Saint-Hilaire. Le mois de mars est dédié à la sensibilisation au dépistage du …
L’autre conséquence du reconfinement
Il est 17 heures passé, sur le quai de la gare d’Agen. Avec 20 minutes de retard sur l’horaire affiché, …
L’actu journal du 20 mars 2021

Obtenir le journal › La Nouvelle République journal du 20 mars 2021

Obtenir le journal ›
Le Progrès journal du 20 mars 2021

Obtenir le journal › The Independent journal du 20 mars 2021

Obtenir le journal › l’Indépendant journal du 20 mars 2021

Obtenir le journal › «Savoir pourquoi il a tué Papa» «La fille de Gregory Nou vous l’a dit: “Je viens à l’audience pour savoir pourquoi il a tué mon papa”. …
Huis clos pour des viols et des actes de tortures sur trois mineures
Sans trente minutes de retard, ce ne serait pas le président Charles Pinarel. Hier matin, c’est sous sa présidence que …
6 mois de prison pour la détenue qui a blessé une surveillante
Ce vendredi 19mars, une détenue du centre pénitentiaire de Perpignan comparaissait devant le tribunal correctionnel après avoir blessé une surveillante. …
Le taux d’incidencerepart en flèche, les variants s’installent
Le vendredi 12mars, le traditionnel point hebdomadaire commun à la préfecture de l’Aude et à l’agence régionale de santé (ARS) …
La femme enceinte agresse une policière qui subit 10 jours d’ITT
Personne ne comprend vraiment comment la jeune mère de famille sans histoire, inconnue de la justice, a pu ainsi «fondre …
La Libre Belgique journal du 20 mars 2021

Obtenir le journal › La Dernière Heure/Les Sports journal du 20 mars 2021

Obtenir le journal ›
Le Dauphiné Libéré journal du 20 mars 2021

Obtenir le journal › Le Petit Quotidien journal du 20 mars 2021

Obtenir le journal › Presse Océan journal du 20 mars 2021

Obtenir le journal › La Baule : un enjeu d’accueil et de prudence Expérience. « Tous les trains sont complets » affirme ce vendredi soir le maire LR de La Baule. Si Franck Louvrier, se …
Confinement : c’est la nouvelle ruée vers l’Ouest
Ce vendredi, en gare de Nantes, les trains arrivant de Paris-Montparnasse sont bien remplis. En descendant, on se presse, comme …
Plusieurs centres de dépistage éphémères
Les données épidémiologiques montrent une circulation plus importante du Covid-19 dans certaines communautés de communes du département de la Loire-Atlantique. Dans …
Un grand centre en avrilà Nantes
Un centre de vaccination de taille très importante doit ouvrir en avril à Nantes, probablement au parc des expositions de la Beaujoire, …
Un an après, la « Ville imaginaire » prend vie
Il a permis aux petits et aux grands Nantais de s’échapper dans leur imaginaire pendant le premier confinement. Le 17 mars …
Le Parisien journal du 20 mars 2021

Obtenir le journal › Toutes les réponses à vos questions Est-ce que je peux aller chez le coiffeur ? Pourrai-je assister à un mariage ? Le télétravail est-il obligatoire ? Nous avons …
Négociations tendues autour des produits de première nécessité
Une journée de tractations. A l’issue des annonces de Jean Castex, selon lesquelles seuls les « commerces vendant des produits de …
Ces épidémiologistes avaient vu juste
Difficile de dire que personne n’avait prévenu. « L’arrivée du variant anglais pourrait conduire à la mi-mars à […] des conséquences …
Les effets du confinement, c’est pas pour maintenant
Le printemps revient aujourd’hui, mais pas le regain d’optimisme qu’on aime lui associer. « Vous voulez savoir si les semaines à …
Vous aviez réservé un billet ? Voici comment vous retourner
L’île-de-France, les Hauts-de-France, l’Eure, la Seine-Maritime et les Alpes-Maritimes sont confinés depuis hier soir. Les déplacements interrégionaux sont interdits. Quelles …
Midi Libre journal du 20 mars 2021

Obtenir le journal › Calligrammes au lycée Émile Peytavin Les élèves de 3e,prépa métier, et de seconde du lycée professionnel exposent leurs calligrammes au centre de documentation. Ils ont …
« Pourquoi avez-vous tué Francis Huster ? »
De la ministre en charge des discriminations,lisabeth Moreno, présente ce jeudi à Saint-Laurent-d’Aigouze sur le tournage d’. L’occasion de poser …
Plus vite encore
Avec cinq agents positifs au Covid dans la cuisine centrale, le service tourne au ralenti. Et il n’est pas le …
Covid : la réanimation du centre hospitalier se remplit très vite
La vaccination des Ehpad a des effets sur le centre hospitalier.Malgré des taux d’incidence de 406cas pour 100000habitants à Uzès …
Volcanique
La fronde des intermittents prend de l’épaisseur. Ils occupent plus de 75 lieux culturels à travers la France, pour réclamer …
Le Courrier de L’Ouest journal du 20 mars 2021

Obtenir le journal › Angélique, la SDF, hésite à quitter sa caravane …
Trois verbes face au Covid
Jusqu’à présent et jusqu’aux dernières annonces gouvernementales, le monde d’après ressemble à un monde de maintenant qui n’en finit pas. …
Les retraités en ont marre !
Michel Ferchaud, le président de l’association des retraités d’Avrillé, se fait le porte-parole de ses adhérents. Il espère relancer rapidement …
La relève lutte pour la planète
Angers. Ils ont chanté et dansé mais le petit millier de lycéens présents dans les rues hier pour la manifestation …
Nicols reçoit un prix de l’innovation au Salon Virtual Nautic
L’entreprise choletaise Nicols a reçu lors du salon Virtual Nautic un prix de l’innovation pour son « Quattro Fly C Green », …
Le Bien Public journal du 20 mars 2021

Obtenir le journal › La Croix journal du 20 mars 2021

Obtenir le journal › Ouest-France édition France journal du 20 mars 2021

Obtenir le journal › Confinement – Les Franciliens font leur retour dans l’Ouest Page …
Peut-on se débarrasser du jetable ?
Les images des vastes « soupes » de débris de plastiques qui se concentrent au gré des courants dans l’Atlantique, le Pacifique …
Nous croulons sous ses déchets, à quand la fin du tout plastique ?
De Bayeux à la Turquie, des plages des Landes au fond des mers, sous forme de déchets ou microscopique, le …
Alimentation – Le bio séduit toujours plus de Français
Page …
Magali Blandin – Un projet criminel derrière sa disparition ?
Page …
Centre Presse Aveyron journal du 20 mars 2021

Obtenir le journal › Social.Un millier de manifestants pour défendre l’avenir de l’usine Bosch Jean-François, «20 ans de boîte», pas désabusé mais «réaliste» Sirènes, pétards et feux d’artifice étaient hier de sortie pour accompagner un «petit» millier de manifestants entre la place des …
Covid-19.Deux écoles et onze classes fermées en Aveyron
D’après les données recueillies par l’académie de Toulouse, 11 classes et 2 écoles du département sont fermées suite à la …
Naucelle.La ministre a découvert la belle réussite des bennes JPM
Elle est arrivée un peu avant 10h, d’Aurillac, après un déplacement jeudi en Corrèze et dans le Cantal. Avant de …
Bosch.La visite de la ministre Agnès Pannier-Runacher n’a rien changé Quelles suites?
Le calme puis la tempête. Il est 15h40 quand les représentants syndicaux et Agnès Pannier-Runacher, ministre déléguée chargée de l’Industrie, …
Au fil des dossiers.Marché du faubourg maintenu, conseiller numérique…
Marché du Sacré-Cœur. Depuis 2018, le marché du Sacré-Cœur est installé dans la cour de la maison des associations. Et …
Libération journal du 20 mars 2021

Obtenir le journal › le confinement prend l’air Trop léger, trop tardif… Les épidémiologistes doutent de l’efficacité du dispositif qui entre en vigueur ce week-end et pour au moins un mois dans seize …
Pari
Confiner la population en la poussant à sortir à l’air libre, voici donc le nouveau pari d’Emmanuel Macron pour lutter …
Face aux contaminations, la revanche du plein air
Fini, le classique confinement avec interdiction de mettre le nez dehors. Annoncées jeudi soir, les mesures prises par le gouvernement …
Les Allemands déjà confinés hors de chez eux
Pour faire passer la pilule de son troisième confinement, le Premier ministre, Jean Castex, a signalé à ses concitoyens jeudi …
Confinement light S’enfermer dehors sera-t-il suffisant ?
C’est un pari risqué qu’a fait jeudi soir le gouvernement en choisissant un confinement très soft dans les régions et …
Le Maine Libre journal du 20 mars 2021

Obtenir le journal › Projet Ikea-Leclerc à Béner : nouveau revers des opposants Leur recours lié à la loi sur l’eau a de nouveau été rejeté par la cour administrative d’appel de Nantes. Page …
Un air de « printemps sarthois »
Sarthe. Sous l’effet de la crise sanitaire, la renaissance des campagnes s’accélère. Les initiatives se multiplient et font la part …
Un souffle nouveau
Parce qu’on a besoin de respirer, d’imaginer le monde d’après, de se rassurer aussi sur les solidarités d’aujourd’hui quand confinement …
Des lectures pour aller plus loin
Depuis quelques années, la ruralité nourrit des essais de sociologues, journalistes ou géographes. Après l’attrait des villes, nombre d’études (publiées …
Indispensables associations
Lorsqu’il évoque les territoires ruraux, Emmanuel Franco souligne le rôle fondamental des associations, gage de dynamisme et de vitalité dans …
La Nouvelle République des Pyrénées journal du 20 mars 2021

Obtenir le journal › V’là les beaux jours! Chaque matin, votre quotidien favori donne le dicton du jour. Hier, fête des Joseph, c’était « Le chaud à la …
Beaudéan : Sylviane n’est jamais rentrée des courses
L’inquiétude est immense. Sylviane Delavault Carpentier, une retraitée de 62 ans, ne donne plus signe de vie à ses proches, …
L’IFSI en renfort
96 élèves de 1 re année de l’IFSI de Tarbes ont suivi une formation spécifique « vaccination » auprès des …
Une convention pour un avion de légende
Chez les avionneurs, la patience est une nécessité. Aussi, les bénévoles de l’asociation Héritage Avions Morane-Saulnier ne se laissent pas …
Cluster et dépistage massif au tribunal de grande instance
Un dépistage massif à la Covid-19 a été organisé hier au tribunal judiciaire de Tarbes. Après un premier cas signalé …
Le Veinard journal du 20 mars 2021

Obtenir le journal › The Guardian journal du 20 mars 2021

Obtenir le journal ›
Libération Champagne journal du 20 mars 2021

Obtenir le journal › Corse Matin journal du 20 mars 2021

Obtenir le journal › Ouest-France journal du 20 mars 2021

Obtenir le journal › Magali Blandin – Un projet criminel derrière sa disparition ? Page …
Peut-on se débarrasser du jetable ?
Les images des vastes « soupes » de débris de plastiques qui se concentrent au gré des courants dans l’Atlantique, le Pacifique …
Confinement – Les Franciliens font leur retour dans l’Ouest
Page …
Alimentation – Le bio séduit toujours plus de Français
Page …
Nous croulons sous ses déchets, à quand la fin du tout plastique ?
De Bayeux à la Turquie, des plages des Landes au fond des mers, sous forme de déchets ou microscopique, le …
La Marseillaise journal du 20 mars 2021

Obtenir le journal › Article 27926 – 0320 – 3,00 E bouches-du-rhône et var 3,00 E http://www.lamarseillaise.fr Du samedi 20 au dimanche …
Article
Photo bruno giordano Photo dr Photo dr photo lycée des …
Titre suite titre
3 e vague, nouveaux confinements Fin de l’entracte et arrêt de la précarisation : les exigences du monde culturel sonné …
Titre suite titre
Les Olympiens se déplacent dans la Baie des Anges pour s’accrocher à une 5e place en Ligue 1, alors que …
Les rendez-vous
Marseille Rassemblement place Général de Gaulle Ce samedi à 11h, les occupants du théâtre du Merlan et de la Criée …
Les Dernières Nouvelles d’Alsace journal du 20 mars 2021

Obtenir le journal › La Voix du Nord journal du 20 mars 2021

Obtenir le journal ›
Charente Libre journal du 20 mars 2021

Obtenir le journal › L’Union journal du 20 mars 2021

Obtenir le journal ›
The New York Times International Edition journal du 20 mars 2021

Obtenir le journal › L’Alsace journal du 20 mars 2021

Obtenir le journal ›
L’Est Républicain journal du 20 mars 2021

Obtenir le journal › Dordogne Libre journal du 20 mars 2021

Obtenir le journal ›
Corriere Della Sera journal du 20 mars 2021

Obtenir le journal › L’Éclair des Pyrénées journal du 20 mars 2021

Obtenir le journal › La Dépêche du Midi journal du 20 mars 2021

Obtenir le journal › Nouvelles villes La prise de conscience ne date pas de l’épidémie de Covid-19, mais celle-ci suscite incontestablement une accélération bienvenue des projets …
Ces centres-villes qui veulent se renouveler
L’idée selon laquelle la métropolisation de la France conduirait à avoir de grandes villes riches et des périphéries plus pauvres …
« Risque de paupérisation »
La première carte postale de Lannemezan (Hautes-Pyrénées) à la sortie de l’autoroute plante le décor. La fumée crachée par la …
À Albi, « Cœur de ville » a été un véritable accélérateur
Densifier l’habitat et dynamiser le centre-ville. À Albi, le projet de transformation de l’école Pasteur est un des symboles de …
Pourquoi, selon Emmanuel Macron, « ça va taper dur jusqu’à la mi-avril »
L’expression est cash et effrayante à la fois. Emmanuel Macron a affirmé que le Covid-19 allait « taper dur jusqu’à …
Nord Littoral journal du 20 mars 2021

Obtenir le journal › L’Ardennais journal du 20 mars 2021

Obtenir le journal › La Tribune quotidien journal du 20 mars 2021

Obtenir le journal › Confinement : l’économie à nouveau sous pression L’économie tricolore n’est pas prête de voir le bout du tunnel. Lors de son point presse jeudi soir, le Premier …
Pourquoi Volkswagen adopte le modèle révolutionnaire de Tesla dans la voiture électrique
Les constructeurs automobiles allemands se réveillent enfin… Dix ans après l’arrivée de Tesla ou encore de la Zoé de Renault, …
Pourquoi Brandt retrouve des couleurs
Spécialisées dans la cuisson avec les marques haut de gamme De Dietrich et moyenne gamme Sauter et Brandt, les usines …
Et Macron plia face à Castex et à l’APHP sur le « reconfinement »
Et voilà le retour des attestations de déplacement (archaïsme qui fait certes la joie de policiers tatillons) pour près d’une …
Reconfinement en Île-de-France: les acteurs économiques impatients d’en sortir
L’épisode 3 du confinement (lien : https://www.latribune.fr/economie/international/une-partie-de-la-france-se-reconfine-la-vaccination-avec-astrazeneca-reprend-880371.html), annoncé hier soir par le P
Sud Ouest journal du 20 mars 2021

Obtenir le journal › Le grand flou …
«Il y a trop de nuances, c’est à s’y perdre»
Sur les bords du canal Saint-Martin, dans ce Paris de carte-postale, on déjeune sur un banc ou au bord de …
Les Parisiens débarquent dans l a région lassés et résignés
Le contexteReconfinés, vraiment ? Un tiers des Français sont soumis aux nouvelles restrictions décidées par l’exécutif, vues au mieux comme …
Couvre-feu à 19 heures, « moins boulot-dodo »
Dans la France toujours pas confinée, le report à 19heures du couvre-feu est porteur d’espoirs pour les commerçants. «Enfin une …
SNCF: tous les trains rouleront comme prévu jusqu’au 24mars
Avec près de 14millions de visites annuelles et plus de 110millions de billets vendus, ouisncf.com s’affiche fièrement comme le premier …
L’Equipe journal du 20 mars 2021

Obtenir le journal › CHASSEURS DE DRAGONS Vous connaissez la nouvelle ? Non, vous êtes passés au travers ? Bon, laissez-nous vous mettre à jour : dorénavant, les joueurs de …
Changez rien
Vous savez ce que dit le proverbe inventé autour d’une Suze au Café des Sports. On ne change pas une …
CYRIL BAILLE
« Techniquement, Cyril Baille a un profil de trois-quarts centre. » L’hommage vient de Philippe Doussy, l’entraîneur des skills du Racing 92, …
Enfants de l’impatriation
C’est un cadeau de l’administration fiscale pour toutes les entreprises ayant leur siège social en France et souhaitant embaucher des …
Objectif 30
Combien gagnera Kylian Mbappé au Paris-Saint-Germain s’il décide de prolonger son bail dans la capitale au-delà du 30 juin 2022 ? Dans …
L’Equipe Magazine journal du 20 mars 2021

Obtenir le journal › Le compte estbon Les mathématiques, dont on a fêté la journée mondiale le 14 mars, contribuent à rendre le monde meilleur, affirme l’Unesco. …
Le SAV
De nouveau A-t-il fait résonner une chanson du groupe Callejeros dans le vestiaire à la mi-temps pour réveiller ses …
LIGNE BLANCHE
Vendredi dernier, la plus célèbre des courses de ski-alpinisme a eu lieu à Arêches-Beaufort, station savoyarde du massif du Beaufortin. …
Les commotions touchent plus les femmes
La commission digital, culture, média et sport du Parlement britanniques’est lancée depuis le début du mois dans une vaste enquête …
Droit aux rébus
…
Mon Quotidien journal du 20 mars 2021

Obtenir le journal › Télé 2 semaines journal du 20 mars 2021

Obtenir le journal ›
Tout Lyon Essor Rhone journal du 20 mars 2021

Obtenir le journal › journal du 20 mars 2021

Obtenir le journal › Toujours en kiosque
Paris Match 18 mars 2021

Obtenir le journal › L’Eveil Pont-Audemer 16 mars 2021

Obtenir le journal ›
Technikart 18 mars 2021

Obtenir le journal › Grands Reportages 19 mars 2021

Obtenir le journal › Conformément à la loi Informatique et Libertés du 06 janvier 1978, vous bénéficiez d’un droit d’accès, de rectification et de suppresion des données personnelles qui vous concernent. Vous pouvez exercer ces droits auprès de ePresse en écrivant à l’adresse suivante : TOUTABO 59 rue spontini 75116 Paris, à laquelle vous pouvez également exercer un droit d’opposition à recevoir des offres commerciales. Pour vous désinscrire de cette revue de presse, rendez-vous sur cette page.
TOUTABO, SA au capital de 488 213.90 euros, RCS Paris 480 467 000, 59 rue Spontini 75116 Paris
Les Unes de l’Actu du 19/03/2021
journal du 19 mars 2021

Obtenir le journal › Réception En lançant une Année de la famille qui s’ouvre ce vendredi 19 mars, fête de saint Joseph, époux de la Vierge …
De la convocation d’un Synode à une Année de la famille
Octobre 2013. Le Vatican annonce la convocation d’un Synode sur la famille. L’Église veut « prendre des orientations pastorales communes sur les …
Les chiffres romains sont-ils menacés de disparition ?
La décision du Musée Carnavalet- Histoire de Paris de remplacer les chiffres romains par des chiffres arabes pour désigner les …
Le mystère des frères Philippe
Cette enquête de huit pages sur « Le mystère des frères Philippe » mérite d’être saluée. Ce n’est pas facile de revenir …
Le mystère des frères Philippe (suite)
Merci mille fois à Céline Hoyeau pour le gros dossier sur les frères Philippe (La Croix du 22 février). On comprend …
Le Télégramme journal du 19 mars 2021

Obtenir le journal › La Voix du Nord journal du 19 mars 2021

Obtenir le journal ›
Le Progrès journal du 19 mars 2021

Obtenir le journal › Le Bien Public journal du 19 mars 2021

Obtenir le journal › La Tribune quotidien journal du 19 mars 2021

Obtenir le journal › Apple : ce problème de concurrence ignoré par l’antitrust Dans leur bataille contre Apple, enclenchée en juin dernier (lien : https://www.latribune.fr/technos-medias/vie-privee-apple-lance-la-bataille-de-la-publicite-sur-mobile-851529.html), les acteurs de l
« Nous avons besoin de déboucher sur le Tigre standard 3 » (Général Thierry Burkhard)
LA TRIBUNE : Quelle est votre vision sur le débat « rusticité versus technologie » ? GENERAL THIERRY BURKHARD : C’est un faux …
Philippe Aghion : « Macron doit absolument créer le revenu d’insertion pour les jeunes »
PHILIPPE AGHION – Cela fait plus d’un an que le virus se propage en Europe. Quelles leçons ont été tirées …
Relance: la Banque des Territoires prête à apporter 47 milliards à l’économie
La Banque des Territoires (lien : https://www.latribune.fr/entreprises-finance/banques-finance/la-banque-des-territoires-sera-au-plus-pres-du-terrain-olivier-sichel-cdc-780162.html) a beau avoir céléb
Immobilier : ces villes du littoral normand à qui la crise redonne du tonus
« La semaine dernière, j’ai rentré une maison à 9 heures. A midi, elle avait trouvé un acheteur. » Bruno Rioult, …
Les Dernières Nouvelles d’Alsace journal du 19 mars 2021

Obtenir le journal › The Independent journal du 19 mars 2021

Obtenir le journal › Le Courrier de L’Ouest journal du 19 mars 2021

Obtenir le journal › Le Quai transformé en agora Angers. Le Centre national dramatique est devenu un lieu d’échanges et de formations entre artistes et élèves en art dramatique, …
Manœuvres d’ampleur dans le secteur du camping-car
Le groupe Trigano s’apprête à acquérir 70 % de Sud-Loire Caravanes à …
Lo’Jo compose avec de jeunes musiciens
Des ados de deux écoles de musique et de sept communes de l’agglomération angevine composent et créent un spectacle avec …
Le Festival d’Anjou devrait avoir lieu cette année
Frédéric Couturier, directeur du Festival d’Anjou, travaille « d’arrache-pied » pour l’édition …
Dépistage à Orée-d’Anjou et Montrevault-sur-Èvre demain
Une campagne de tests RT-PCR, par voie nasale, du coronavirus Sars-CoV-2 est organisée par l’Agence régionale de santé samedi 20 mars …
La Nouvelle République des Pyrénées journal du 19 mars 2021

Obtenir le journal › Couvre-feu à l’heure d’été « C’est comment qu’on freine Je voudrais descendre de là » Les paroles de cette chanson d’Alain Bashung (1982) reviennent …
La solidarité soigne son patrimoine
La solidarité et l’action sociale, ce ne sont pas que des concepts, il faut du monde, beaucoup de monde pour …
Vers une justice sans papier
Depuis le premier mars, la Justice tarbaise amorce la première phase d’un grand changement : sa transition vers le tout …
Article
VIDE-RESTAURANT > A l’Empreinte. Ce samedi 20 mars de 14 heures à 16 heures, le restaurant l’Empreinte situé 2 rue …
Article
Luz-Saint-Sauveur > Blessé à la main. Un homme de 84 ans, qui circulait à bord de sa voiture sur la …
La République des Pyrénées journal du 19 mars 2021

Obtenir le journal › Libération Champagne journal du 19 mars 2021

Obtenir le journal ›
Centre Presse journal du 19 mars 2021

Obtenir le journal › L’Est éclair journal du 19 mars 2021

Obtenir le journal › Libération journal du 19 mars 2021

Obtenir le journal › HARCÈLEMENT SCOLAIRE 700 000 enfants victimes par an pages …
putain, un mois…
Seize départements, dont toute l’Ile-de-France, replacés sous cloche : même si les règles ont été assouplies, le gouvernement a dû …
RECONFINEMENT Les montagnes virus
Restez chez vous mais allez dehors. Après plusieurs jours d’attente, le Premier ministre, Jean Castex, a annoncé jeudi soir un …
Tour d’Europe des mesures anti-Covid
nConfinements : certains espèrent entrevoir la sortie du tunnel, comme le Royaume-Uni et le Portugal, qui amorcent leur déconfinement. D’autres se résolvent …
L’Agence du médicament règle le cas d’AstraZeneca
Sur le papier, c’est juste un incident de parcours. Quatre jours après avoir suspendu son utilisation au nom du «principe …
Les Echos journal du 19 mars 2021

Obtenir le journal › A la traîne des autres capitales, Paris allume enfin la 5G TéLéCOMS : Après des mois de débats, Paris ouvre enfin la 5G. Orange, Bouygues Telecom, SFR et Free vont allumer …
Danone : le nouveau président s’explique sur l’éviction d’Emmanuel Faber
Le conseil d’administration de Danone a mis fin au mandat d’Emmanuel Faber, PDG débarqué dimanche après quatre ans aux commandes …
Les pistes de Bercy pour retrouver la maîtrise de la dette publique
BUDGET : Le rapport Arthuis rendu jeudi au gouvernement juge possible d’infléchir l’endettement à l’horizon 2030 grâce à l’instauration d’une …
Les marchés fébriles face au risque d’un retour de l’inflation
Politique monétaire : Les divergences de vues s’accroissent, entre les marchés et la Réserve fédérale américaine. La Fed maintient qu’elle …
Les ravages de la « cancel culture » en France
La « cancel culture » qui submerge désormais l’univers intellectuel et universitaire français détourne, à force de radicalisation, les débats des vraies …
The Guardian journal du 19 mars 2021

Obtenir le journal › La Dépêche du Midi journal du 19 mars 2021

Obtenir le journal ›
Dordogne Libre journal du 19 mars 2021

Obtenir le journal › La Nouvelle République journal du 19 mars 2021

Obtenir le journal ›
L’Est Républicain journal du 19 mars 2021

Obtenir le journal › Courrier Picard journal du 19 mars 2021

Obtenir le journal ›
Corse Matin journal du 19 mars 2021

Obtenir le journal › Nord éclair journal du 19 mars 2021

Obtenir le journal ›
Corriere Della Sera journal du 19 mars 2021

Obtenir le journal › Le Figaro journal du 19 mars 2021

Obtenir le journal › Midi Libre journal du 19 mars 2021

Obtenir le journal › Miss Samoussa, l’art et les saveurs d’une cuisine afro antillaise «Gimgembre, curry et curcuma, c’est le mélange des trois qui va donner ce bon goût.»Salamatou Moussa n’en dira pas plus… …
Libres de grammatica
par Boby lo contejaïreAvèm de còps patir a trapar un mot una frasa en occitan! Manca de vocabulari, la gramatica …
Paquita,el camion arrive
Rendez-vous ce samedi matin au marché de Beausoleil avec les Ehpad de la Croix-Rouge à Nîmes, les résidents, les salariés …
L’hôpital de Millau prend de plein fouet la situation catastrophiqueL’hôpital de Millau prend de plein fouet la situation catastrophique
C’est un nouveau cluster qui vient frapper le centre hospitalier de Millau. Le variant anglais, qui circule à toute vitesse …
Une étape 100 % Lozère
Le Tour cycliste féminin international de l’Ardèche, pour sa 19eédition prévoit une étape 100% Lozérienne qui aura lieu le samedi …
L’Ardennais journal du 19 mars 2021

Obtenir le journal › L’Union journal du 19 mars 2021

Obtenir le journal ›
L’Equipe journal du 19 mars 2021

Obtenir le journal › L’Opinion journal du 19 mars 2021

Obtenir le journal › Le Maine Libre journal du 19 mars 2021

Obtenir le journal › « On est sur une bonne série à domicile, il faut continuer » Sélectionné en équipe de France U20, Logan Costa se livre avant la réception de Concarneau ce soir. PAGES …
Seize départements reconfinés un mois
Covid-19. Face à la progression de l’épidémie, le Premier ministre Jean Castex a annoncé hier de nouvelles mesures notamment en …
Enfants malades : la corvée des papiers administratifs
Les parents d’enfants malades ou porteurs de handicap doivent souvent faire face à des défis …
Marc, un mordu des chiffres et des lettres
Adhérent au club du Mans, il avait participé il y a 17 ans au célèbre jeu télévisé. Celui qui ne rate …
Traiter ces dossiers en urgence
Anne-Sophie Marie-Angélique est manager de proximité et pilote du processus Allocation journalière de présence parentale. Des situations sensibles Le processus qu’elle écrit …
Ouest-France journal du 19 mars 2021

Obtenir le journal › Fusillade à Rennes – La victime décédée, un suspect mis en examen Page …
Sports – Les jeunes se désintéressent-ils vraiment du foot ?
En …
Les États-Unis changent de ton
Poutine est-il un tueur ? La question du journaliste de la chaîne de télévision américaine ABC a le mérite de la …
Confinement étendu, couvre-feu modifié : le point sur les mesures
Le Premier ministre Jean Castex a annoncé, hier soir, que seize départements français, dont l’ensemble de la région parisienne (ici, …
Mark Rutte, le frugal insatiable
Profil Pas de chichi. Pour son 4e mandat de Premier ministre, Mark Rutte n’envisage pas de « visio-fiesta » depuis le modeste rez-de-chaussée …
Le Petit Quotidien journal du 19 mars 2021

Obtenir le journal › Le Journal de Saône et Loire journal du 19 mars 2021

Obtenir le journal ›
La Presse de la Manche journal du 19 mars 2021

Obtenir le journal › L’Éclair des Pyrénées journal du 19 mars 2021

Obtenir le journal › La Marseillaise journal du 19 mars 2021

Obtenir le journal › Vente contestée du couvent des Prêcheurs Photo wikicommons Faute d’avoir pu négocier avec l’héritière de Picasso pour en faire un musée, la Ville a décidé de …
Des concerts tests à la Secret Place
La CGT 34 dénonce une criminalisation de l’action syndicale, au prétexte de la crise sanitaire. PHOTO Julie Chansel Julie Chansel …
Article
27931 – 0319 – 3,00 E Occitanie 3,00 E http://www.lamarseillaise.fr Du vendredi 18 au jeudi 25 mars …
Embarquement pour sept mois de dépollution
étang de berre L’association Wings of the Ocean débute un programme inédit pour nettoyer le plan d’eau salée et sensibiliser …
Titre sur 2 lignes
300 embauches au niveau national sur 3 ans Après des années de casse, l’heure est à l’embauche. Une annonce qui …
Al Bayane journal du 19 mars 2021

Obtenir le journal › The New York Times International Edition journal du 19 mars 2021

Obtenir le journal › Ouest-France édition France journal du 19 mars 2021

Obtenir le journal › Les États-Unis changent de ton Poutine est-il un tueur ? La question du journaliste de la chaîne de télévision américaine ABC a le mérite de la …
Santé – Ces soignants qui percent les secrets de votre sommeil
En dernière …
Sports – Les jeunes se désintéressent-ils vraiment du foot ?
En …
Confinement étendu, couvre-feu modifié : le point sur les mesures
Le Premier ministre Jean Castex a annoncé, hier soir, que seize départements français, dont l’ensemble de la région parisienne (ici, …
Des veaux irlandais exportés par avions
Dublin. De notre correspondante Quand les cochons voleront ! Une expression anglaise qui pourrait bientôt s’appliquer… aux bovins. Le gouvernement irlandais projette …
Presse Océan journal du 19 mars 2021

Obtenir le journal › La sablière retraite les gravats du futur CHU Diversification. Depuis quelques semaines, le trafic de camion s’est nettement intensifié entre le site du futur CHU de Nantes et …
«On ne veut pas devenir une nouvelle Andalousie»
D’un côté les sabliers, de l’autre, les maraîchers. La centaine de membres de la Tête dans le sable s’estiment cernés …
Sablières : le projet d’extension qui inquiète
C’est une butte qui se dresse le long de la D178, juste à la sortie de Saint-Colomban, au sud de …
Jadot veut « une écologie de solutions »
Presse Océan : les élections régionales dans la région s’annoncent rudes… Yannick Jadot : « Cela va être l’occasion d’un débat très riche sur …
« A la Bretonne ! » veut peser dans le débat
L’association « À la bretonne ! » veut peser dans le débat des élections régionales et départementales, prévues les 13 et 20 juin. Elle annonce …
L’actu journal du 19 mars 2021

Obtenir le journal › Mon Quotidien journal du 19 mars 2021

Obtenir le journal ›
France-antilles Martinique journal du 19 mars 2021

Obtenir le journal › Charente Libre journal du 19 mars 2021

Obtenir le journal › L’Humanité journal du 19 mars 2021

Obtenir le journal › Léna Lazare Comme un air de déjà-vu, sauf que cette fois, il y a aussi de « la rage », prévient Léna Lazare, …
Bonne nouvelle
La Haute Cour du Kenya a confirmé l’interdiction des mutilations génitales féminine. La pratique avait été rendue illégale en 2011 …
Crise d’inégalité
Bien évidemment, le suspense autour des nouvelles restrictions sanitaires, dévoilées jeudi soir par Jean Castex, a mobilisé toutes les attentions. …
Chez EDF, des secrétaires sous-traitées
Lors du dernier appel d’offres, Magali, Isabelle (1), comme la trentaine de leurs collègues, ont eu droit à un curieux …
Un confinement régionalisé pour juguler la troisième vague
Alors que la France entière est déjà sous couvre-feu, l’exécutif a tout fait pour retarder les restrictions supplémentaires. Cependant, il …
Le Petit Bleu d’Agen journal du 19 mars 2021

Obtenir le journal › Une destination qui tord le cou à la sinistrose… L’entreprise Nicols, également dans la location de bateau sans permis pour le tourisme fluvial, a conscience elle aussi du potentiel …
Sur le canal, une quiétude qui suscite des envies
Éternellement calme et paisible, le canal latéral à la Garonne est imperturbable, offrant un décor d’exception en plein cœur de …
Art et commerce se tendent la main pour sortir de la crise
« Quand on m’a parlé de cette idée d’exposer mes œuvres dans un magasin, j’avoue avoir été plutôt surprise », …
Article
listes électorales > Inscriptions. Pour participer à ces scrutins, vous devez être impérativement être inscrit sur les listes électorales au …
Petite toponymie communarde, et agenaise
Voilà un anniversaire qui n’est pas célébré à sa juste valeur : le 18 mars 1871 – il y a …
La Provence journal du 19 mars 2021

Obtenir le journal › Sud Ouest journal du 19 mars 2021

Obtenir le journal › Centre Presse Aveyron journal du 19 mars 2021

Obtenir le journal › Agriculture.L’Aveyron de moins en moins gourmand en pesticides Au cours de l’année 2019 dans l’Aveyron, 90359,50kg de produits phytosanitaires ont été achetés, ce qui représente 0,17kg de pesticides …
Justice.De l’Aveyron à la Roumanie, itinéraire d’un «parfait escroc» 4
C’est un dossier tentaculaire, de plusieurs milliers de pages, sur lequel le tribunal de Rodez se penche depuis plusieurs années. …
Aveyron L’auteur présumé de sept cambriolages sous les verrous
Entre2018 et2020, plusieurs résidences sont victimes de cambriolages à travers le département. L’auteur des faits dérobe essentiellement des bijoux et …
Formation.Chambre de métiers: les portes ouvertes sur rendez-vous
Les journées portes ouvertes de la Chambre de métiers et de l’artisanat de l’Aveyron reçoivent en temps normal près de …
Industrie.Bosch, des réponses sur l’avenir dès aujourd’hui?
«Cette journée doit marquer le début de la lutte après la suppression de 750 emplois d’ici 2025»: les syndicats de …
Le Parisien journal du 19 mars 2021

Obtenir le journal › « Désormais, on a un horizon » Figure de cette crise, Karine Lacombe, cheffe de l’infectiologie à l’hôpital Saint-Antoine à Paris (XII e), sait que les prochaines …
Le confinement revu et corrigé
Ni desserrement ni mise sous cloche généralisée. Pour freiner la troisième vague, dopée par l’émergence des variants, Emmanuel Macron a …
« Le pari de Macron est perdu »
L’approche « pragmatique, proportionnée et territorialisée » revendiquée par Jean Castex ne semble pas convaincre les élus locaux. « Je prends acte des …
Les Parisiens résignés et désabusés
« Non, on ne sera pas sages ! » Maxime, duffle-coat marine sur le dos, ne supporte pas l’idée de ce troisième confinement …
Obligés de fermer quatre semaines, les commerçants « non essentiels » se disent « atterrés »
Ce commerçant qui vend des jeux de société et des puzzles à Paris et dans le centre commercial Evry 2 …
l’Indépendant journal du 19 mars 2021

Obtenir le journal › J.-M. Pujol: «Les mémoires, mêmes partielles, doivent être respectées» Quel regard portez-vous sur le rapport de Benjamin Stora commandé par le Président de la République et qui est un …
Moyens humains et financiers renforcés à l’Agence technique départementale
Surveiller un ouvrage d’art, détecter une fuite dans les réseaux, effectuer une visite de station d’épuration, être assisté pour une …
Ouverture des inscriptions pour le tournoi «AudE-Foot»
Disputer une compétition de football manette en main sera bientôt possible dans le département avec «AudE-Foot», premier challenge E-Sport organisé …
La gauche juge sévèrement Louis Aliot
N». La décision du maire RN de Perpignan de dresser à la salle des Libertés un lieu de mémoire et …
Prolongation de l’exposition au 20mars
Initialement prévue pour la seule journée du 19mars, l’ouverture du site à la salle des Libertés (3 rue Edmond Bartissol) …
Le Veinard journal du 19 mars 2021

Obtenir le journal › Le Républicain Lorrain journal du 19 mars 2021

Obtenir le journal ›
Le Dauphiné Libéré journal du 19 mars 2021

Obtenir le journal › Nord Littoral journal du 19 mars 2021

Obtenir le journal ›
Le Courrier du Pays de Retz journal du 19 mars 2021

Obtenir le journal › Les Alpes Mancelles journal du 19 mars 2021

Obtenir le journal › Auto Plus journal du 19 mars 2021

Obtenir le journal › L’événement : Fiscalité, circulation… Ce qui vous attend au printemps Un nouvel arrêté étend la liste des véhicules essence éligibles à la pose légale d’un boîtier de conversion au superéthanol. …
De nouvelles contraventions sont apparues avec le Covid
…
Edito : Couvrez cette auto que je ne saurais voir
Rien ne se perd, rien ne se crée, tout se transforme… Nos constructeurs nationaux viennent simultanément d’illustrer cette fameuse maxime …
Kia XCeed Hybride Rechargeable
En quoi consiste cette offre ? C’est une location longue durée (LLD) d’un format un peu inhabituel puisque fixée sur …
Jusqu’à 120 € remboursés
Le deal ? Un grand classique du manufacturier, qui permet de réduire sa facture de pneumatiques. Voyons comment en profiter …
Closer journal du 19 mars 2021

Obtenir le journal › La cérémonie des César largement décriée « Fiasco », « désastre », « naufrage »… La 46e cérémonie des César, présentée par Marina Foïs, est loin …
Les toiles désenchantées
NON, CETTE ANNÉE, LES ÉTOILES DU CINÉMA FRANÇAIS N’ONT PAS VRAIMENT BRILLÉ. Et en lieu et place de la renaissance …
Babysitting in the rain
OÙ ? En plein air (mais sous la pluie… ). QUOI ? A Hawaï en famille pour profiter d’un break …
Bella croquer !
OÙ ? A table ! QUOI ? De passage au Sugar Factory, l’une des références d’Ocean Drive, la belle en …
La visite en rose
OÙ ? Dans une école. QUOI ? Le prince William et la duchesse de Cambridge sont rendus à la School …
Elle journal du 19 mars 2021

Obtenir le journal › Cover page AUDREY PULVAR LE ROMAN D’UNE AMBITION FAIT DIVERS LE GANG DES MARIEUSES ENQUÊTE SUR UN BUSINESS JUTEUX LA MODE REND …
SOMMAIRE
13 L’ÉDITO Par Marion Ruggieri. 14 TOUT CE QUI NOUS REND HEUREUX CETTE SEMAINE 16 LE QUESTIONELLE Vincent Darré {LE …
LIBRE COMME JANE
À 83 ans, Jane Fonda, qui vient de remporter un golden globe d’honneur pour l’ensemble de sa carrière, peut se …
TOUT CE QUI NOUS REND HEUREUX CETTE SEMAINE
ESPRIT DE SŒURS Zadig & Voltaire devient mécène de Band of Sisters, un collectif de femmes œuvrant pour la création. …
VINCENT DARRÉ
FANTAISISTE ET ICONOCLASTE, LE DÉCORATEUR DÉPLOIE SON IMAGINAIRE DÉBRIDÉ DANS UNE COLLECTION POUR MONOPRIX*. ET ÉGALEMENT DANS LA VIE. Votre …
Marianne journal du 19 mars 2021

Obtenir le journal › VACCINS : ORGANISER LE FIASCO EN TROIS LEÇONS Parfois, le sort semble s’acharner. Mais les mauvaises langues diront que la malchance, paradoxalement, ne relève pas du hasard et …
NOS OUÏGOURS
Le voyage du pape François en Irak a généralement été bien accueilli un peu partout et dans tous les milieux. …
LES PETITS SOUCIS DE L’ADOLESCENCE
…
LES TROUILLARDS
La Corse et l’omerta. Le cliché a la vie dure. Ne rien dire. Par tradition supposée. Par crainte de froisser …
PETIT CALENDRIER DES GRANDES PEURS
Il y a ceux qui se taisent par lâcheté. À qui on aurait volontiers tendu le micro, mais qui ne …
Public journal du 19 mars 2021

Obtenir le journal › Cover page Jennifer LopezElle a annulé son mariage avec Alex Simon Bakerpeine divorcé, déjà recasé ! Mode Dossier Spécial Éthique, c’est chic …
Paris Hilton
La classe à la française ! Comment croire que cette chicissime blonde aux airs de Grace Kelly était il y …
SOMMAIRE
NEWS 4 César : un césar et au lit ! 6 Vu dans l’actu 8 Julien Doré : papa d’un …
Un césar et au lit !
46ecérémonie des César sans after party, mais avec tapis rouge de compète pour le grand retour du gratin du cinéma …
Où est donc Big Ben ?
Depuis sa rupture avec Ana de Armas, en début d’année, l’acteur de 48 ans se faisait discret. Mais il est …
Le nouvel Economiste journal du 19 mars 2021

Obtenir le journal › La grande mutation du commerce de détail L’une des façons dont le capitalisme s’adapte aux préférences changeantes de la société est la réglementation et les lois gouvernementales, …
À quel point vous sentez-vous homosexuel(le) ?
35 % des personnes interrogées de la génération Z sont principalement ou également susceptibles d’être attirées par l’un ou l’autre …
La fin du bureau ?
Tandis que certains travailleurs rêvent d’un avenir sans trajets ni plats préparés, d’autres s’interrogent sur la menace qui pèse sur …
La nouvelle grammaire concurrentielle de la Big tech
La caractéristique la plus marquante de la nouvelle grammaire de la concurrence est peut-être le chevauchement croissant entre les cinq …
Le duel Apple-Facebook
Apple justifie ses actions dans le cadre d’un engagement à protéger la vie privée de ses utilisateurs. Facebook dit qu’il …
Le Figaro Magazine journal du 19 mars 2021

Obtenir le journal › Madame Figaro journal du 19 mars 2021

Obtenir le journal › France Dimanche journal du 19 mars 2021

Obtenir le journal › Cover page LE CHÔMAGE ET MAINTENANT LA MALADIE… Julien LEPERS UN CANCER FOUDROYANT ! France Dimanche SIX MOIS APRÈS SA MORT Annie …
INGRID CHAUVIN
INGRID CHAUVIN À peine divorcée, l’actrice de 47 ans est une maman solo comblée ! Son fils de 4 ans …
OLIVIER VÉRAN
OLIVIER VÉRAN Petit dormeur, il avoue carburer au Coca zéro, pourtant réputé mauvais pour l’organisme à cause de sa teneur …
Doubles couronnes ?
Pandémie oblige, les deux éditions du concours Miss Univers de 2020 et 2021 auront lieu cette année. La jolie Normande, …
JEAN-LOUIS AUBERT
JEAN-LOUIS AUBERT La maman du chanteur, Nicole, qui avait pu approcher le général de Gaulle quand son fils était bébé, …
Le Revenu Hebdo Bourse journal du 19 mars 2021

Obtenir le journal › My Little Weekly journal du 19 mars 2021

Obtenir le journal ›
Croix du Nord journal du 19 mars 2021

Obtenir le journal › EcoRéseau Franchise & Concept(s) journal du 19 mars 2021

Obtenir le journal ›
L’Echo du Tarn journal du 19 mars 2021

Obtenir le journal › Les Informations Dieppoises journal du 19 mars 2021

Obtenir le journal ›
Le Pays Briard journal du 19 mars 2021

Obtenir le journal › L’Eclaireur de Chateaubriant journal du 19 mars 2021

Obtenir le journal ›
Le Journal de Vitré journal du 19 mars 2021

Obtenir le journal › Le Petit Courrier L’Echo de la Vallée du Loir journal du 19 mars 2021

Obtenir le journal ›
Croix du Midi journal du 19 mars 2021

Obtenir le journal › Le Progrès – Le courrier journal du 19 mars 2021

Obtenir le journal ›
Le Pays d’Auge journal du 19 mars 2021

Obtenir le journal › Haute Saintonge journal du 19 mars 2021

Obtenir le journal ›
Haute Gironde journal du 19 mars 2021

Obtenir le journal › Le Tarn Libre journal du 19 mars 2021

Obtenir le journal › Midi Olympique Vert journal du 19 mars 2021

Obtenir le journal › Promotion canapé Vous n’irez pas au stade, ce week-end. Ça fait un an que ça dure et le manque est immense. On …
Gareth Edwards « Notre jeu a besoin de garçons comme Dupont »
Comment allez-vous, Gareth ? Il fait beau, je respire encore, la vie est belle… Qu’avez-vous pensé des quatre …
Alldritt – Faletau, un bras de fer de super-héros
L’an passé, à Cardiff, ce duel avait ressemblé à un choc des générations. Une confrontation du nouveau monde contre l’ancien.àl’époque, …
« ça fait plaisir de commencer »
Êtes-vous conscient d’avoir réalisé une grosse prestation contre l’Angleterre ? Je me sentais bien physiquement. On n’avait pas joué …
MARCHAND-CHAT, LES DEUX FONT LA PAIRE
Camille Chat était désigné comme le successeur de Guilhem Guirado. Un processus entamé dès la dernière Coupe du monde puisque …
Voix du Gers journal du 19 mars 2021

Obtenir le journal › La Dépêche journal du 19 mars 2021

Obtenir le journal ›
Le Film Français journal du 19 mars 2021

Obtenir le journal › L’Essor Isère journal du 19 mars 2021

Obtenir le journal ›
L’Essor Affiches Loire journal du 19 mars 2021

Obtenir le journal › 30 Millions d’Amis journal du 19 mars 2021

Obtenir le journal › Décision Boissons journal du 19 mars 2021

Obtenir le journal › Danone : le patron évincé avec effet immédiat Le conseil d’administration de Danone (notamment propriétaire des marques Évian, Volvic, Aqua, etc.) a évincé Emmanuel Faber de la tête …
Un alcool très pénalisé sur le marché français
La filière calvados a connu un repli de 17 % de ses expéditions en 2020 avec 4,2 millions de bouteilles …
Création d’une plateforme de e-commerce de gin français
Après avoir été à l’initiative du premier festival français 100 % gin & tonic, l’équipe de The Gin Addict vient …
Nestlé acquiert l’eau fonctionnelle Essentia Water
Nestlé USA a annoncé il y a quelques jours avoir acquis Essentia Water, une marque d’eau fonctionnelle haut de gamme …
Atlantique Boissons Nantes déstocke auprès des particuliers
Le distributeur de boissons Atlantique Boissons Nantes, confronté à une situation inédite avec des stocks et des sorties de marchandises …
The Guardian Weekly journal du 19 mars 2021

Obtenir le journal › Nouvelles Semaine journal du 19 mars 2021

Obtenir le journal ›
Aujourd’hui en France (Week-end) journal du 19 mars 2021

Obtenir le journal › journal du 19 mars 2021

Obtenir le journal ›
journal du 19 mars 2021

Obtenir le journal › journal du 19 mars 2021

Obtenir le journal › Toujours en kiosque
Voix du Midi 18 mars 2021

Obtenir le journal › Golf Magazine 05 mars 2021

Obtenir le journal ›
Science et Vie Junior 10 mars 2021

Obtenir le journal › Femme Actuelle 15 mars 2021

Obtenir le journal › Conformément à la loi Informatique et Libertés du 06 janvier 1978, vous bénéficiez d’un droit d’accès, de rectification et de suppresion des données personnelles qui vous concernent. Vous pouvez exercer ces droits auprès de ePresse en écrivant à l’adresse suivante : TOUTABO 59 rue spontini 75116 Paris, à laquelle vous pouvez également exercer un droit d’opposition à recevoir des offres commerciales. Pour vous désinscrire de cette revue de presse, rendez-vous sur cette page.
TOUTABO, SA au capital de 488 213.90 euros, RCS Paris 480 467 000, 59 rue Spontini 75116 Paris
























































































